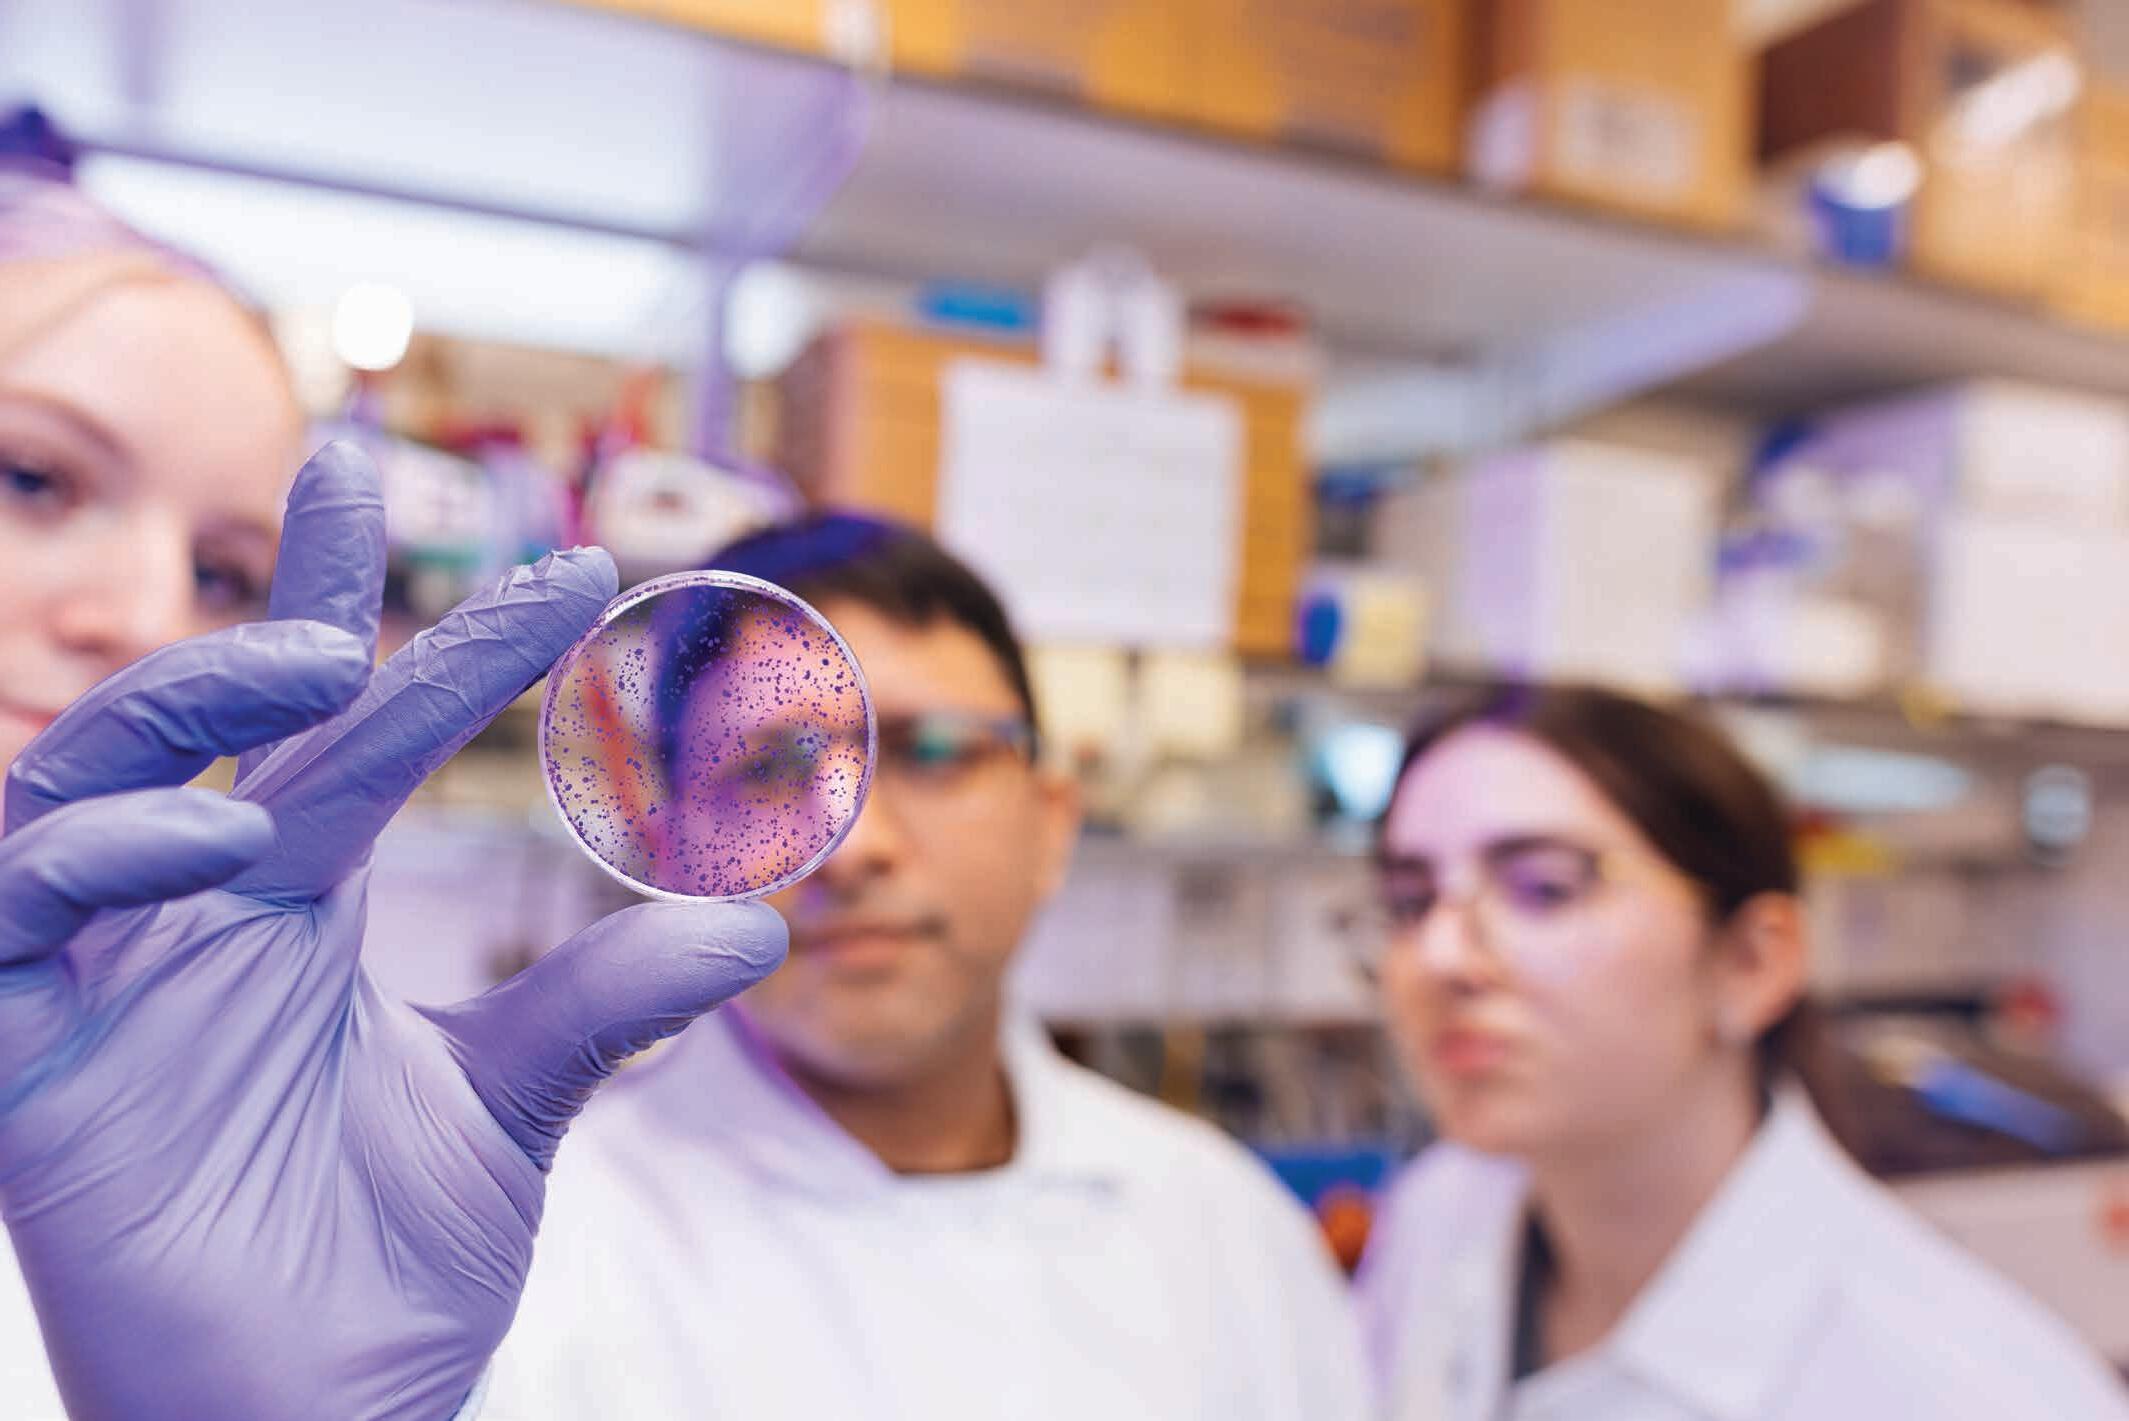

Mother Earth’s

Psychedelic-Assisted Therapy in Nebraska
KING ISO • OOH-DE-LALLY RESTAURANT • TERI ROBERTS • DEAR JUDY • UNO’S PITCH LAB MARCH/APRIL | U.S. $5.95 The Health & Wellness Issue Omaha’s Top Dentists
Medicine
Many have seen the Milan Laser Hair Removal clinics in central, midtown, and west Omaha but don’t know their corporate headquarters call Omaha, Nebraska, home. The nation’s largest laser hair removal company’s humble beginning started in Papillion, Nebraska, with a single Clinic providing laser hair removal, body contouring, botox, and fillers.
Two high school friends from Omaha, now both doctors, took a chance on a place called Milan Laser Aesthetics. The company was for sale and o ered over 10 di erent medspa treatments such as laser hair removal, botox, fillers, and lipo laser. Dr. Shikhar Saxena, co-founder and CEO of Milan Laser, and Milan co-founder Dr. Abe Schumacher made the game-changing decision to focus only on laser hair removal because it yielded the best, most consistent results and proved life-changing for clients.



In their new endeavor, Saxena and Schumacher tapped into a frustration felt by consumers tired of the subpar laser hair removal results common in the industry. Clients purchased treatment packages that wouldn’t deliver the desired results, putting them into a cycle of paying for extra treatment sessions and endless touch-up fees.
Schumacher and Saxena took this common frustration as an opportunity to set themselves apart, so they set out to become leaders in the accelerating laser hair removal industry by delivering exceptional results, transparent pricing, and introducing a first-of-its-kind customer service philosophy. Milan Laser revolutionized the industry with their exclusive Unlimited Package™, which comes with every purchase. This unique package gives clients unlimited treatments on any body area for life with no touch-up fees.
The duo’s medical backgrounds helped create a proprietary treatment protocol still in place today and continuously refined to deliver the results clients wanted as quickly and safely as possible. They did this all while working almost every job in the original Clinic, including sales manager and front desk receptionist.

Fast forward 11 years: Milan Laser has 326 locations in 33 states, with new Clinics opening weekly. But even with Clinics in big cities like Chicago, Atlanta, Houston, and Miami, the company stays true to its Nebraska roots with corporate headquarters in Omaha. Throughout the years, Milan has moved from a humble clinic with a team of three to a premier laser hair removal provider with 2,000+ employees nationally.
Their corporate headquarters in west Omaha houses teams ranging from IT, Accounting, and Marketing with 230+ employees. Milan’s Call Center and Fulfillment Center have 150 employees combined, who book consultations for clients and supply materials for Clinics around the country, respectively.
Milan Laser shows no signs of slowing down. In 2024, they plan to open even more clinics and remain the nation’s largest laser hair removal company.
































TO 326+ CLINICS NATIONWIDE FROM 1 CLINIC IN PAPILLION, NE (and growing!)
Visit milanlaser.com or call 833-NO-RAZOR for more information.

3125 South 72 nd Street (Easy access off I-80, take 72nd Street Exit) Catering . Private Party Rooms . Walk-Ins Welcome Here’s to a Very Saucy 20 Years! 2024 Winner Romantic Restaurant 2024 Winner Happy Hour 2024 First Place Italian Dining SPEZIA SPECIALTIES WOOD FIRE STEAKS & SEAFOOD INNOVATIVE PASTA—RISOTTO—GNOCCHI FRESH SALMON DAILY Open 7 Days a Week for Lunch & Dinner 402.391.2950 . Call today to make your reservation


diagnosed with Alzheimer’s, research into using psychedelics to treat mental illness, the importance of self care, and how the formerly incarcerated have healed to have a second chance. Inspiration for health and well-being unfolds in each story and on every page.
From all of us at Omaha Magazine : be well, stay well, and live well.
Kim Carpenter Editor-in-Chief, Omaha Magazine kim@omahapublications.com
*Note: The hotel edition of Omaha Magazine has a different cover and does not include all of the editorial content included in the magazine’s full city edition. For more information on our city edition, visit OmahaMagazine.com.




MARCH/APRIL // 1 // 2024
RealEstate Company
RealEstate Company

FEATURES THE USUAL SUSPECTS 001 From the Editor To Your Health 004 Between the Lines 005 Calendar of Events 026 Adventure Special Journeys 034 History Walter Reed 073 Obviously Omaha Independent Gyms 090 Explore! 095 Instagram 096 Not Funny LOCKJAW ARTS + CULTURE 012 Music King Iso 018 Video Omaha Guidebook 022 Visual Shelby Seier PEOPLE 030 Gen O April High School Alliance 028 Profile Exist Green 016 Profile Rachel Fox 054 Sports UNO Pitching Lab GIVING 058 Calendar 062 Feature Nebraska Cures TABLE of CONTENTS 042 038 MAGIC HOUR, SHORT EXPOSURE Psychedelic-Assisted Therapy a Focal Point for Mental Health LIGHT AMID THE DARKNESS Teri Roberts Overcomes to Encourage 038 // 2 // MARCH/APRIL 2024 QR QR
Roberts
Teri





60PLUS 066 Active Living Jeanie Neal 068 Nostalgia Omaha Racers 070 Profile Michael James DINING 074 Feature Ooh-de-Lally 078 Profile Don Doty Cibo Vino 080 Review Fig 084 Dining Guide SPECIAL SECTION 048 Omaha's Top Dentists QR 020 read current and previous issues online at omahamagazine.com 074 MARCH/APRIL 2024 // 3 // Listen to the entire issue here. Open the camera on your smart device and hover over the QR code. This conceptual cover underscores how psychedelic-assisted therapy is a promising medicinal alternative for treating mental health. The story, written by Omaha Magazine senior staff writer, Julius Fredrick, begins on page 42 Cover design by Rachel Birdsall & Renee Ludwick. ABOUT THE COVER KING ISO OOH-DE-LALLY RESTAURANT TERI ROBERTS DEAR JUDY UNO’S PITCH LAB MARCH/APRIL U.S. $5.95 The Health & Wellness Issue Omaha’s Top Dentists Medicine Psychedelic-Assisted Therapy in Nebraska Mo E ’s Emily Kassmeier Marks' Signature Mac & Cheese

THE LINES Between
A LOOK AT THREE OMAHA MAGAZINE CONTRIBUTORS

HOLLY MCATEE — Contributing Writer
Holly McAtee is originally from Cincinnati, Ohio. She received her BA in English with a Creative Writing emphasis and a Theatre Minor from Northern Kentucky University. She enjoys reading, painting, acting, attending live theater and concerts, and traveling. She has recently acted in two shows at the Lofte Community Theatre in Manley. She loves to hear people’s stories and is honored to be able to write about them. She is married to her husband, Ray, and they have two children, who attend UNO. She lives in Springfield and enjoys being part of a small community.

LEO ADAM BIGA Contributing Writer
Omaha native Leo Adam Biga has been telling Nebraska stories since the 1980s. As a freelance writer, his work appears in local, statewide, regional, and national publications. His cultural journalism spans film, television, media, literature, theater, music, and athletics. He also covers social justice issues. In addition to writing for media clients, he creates content for nonprofits. As an author his published books include “Alexander Payne: His Journey in Film;” “Crossing Bridges: A Priest's Uplifting Life Among the Downtrodden;” and “Forever Grateful: The Gift of New Life from Organ Donation.” His newest book, “Triumph After Trauma,” publishes this winter.

DAMIAN & SAMANTHA INGERSOLL — Contributing Writers
Omaha Magazine’s favorite son and Distribution Supervisor, Damian, has stepped into his writing shoes with his wife, Samantha, for this issue’s restaurant review. Damian, who has a degree in Early Childhood Education and English from Sacramento State, has been with Omaha Magazine for four years. Samantha, who has a degree in English and Journalism, also from Sacramento State, has worked in the banking industry for the last 20 years. Both Samantha and Damian moved to Omaha from California 11 years ago and immediately fell in love with the city. In their free time, the couple enjoys spending time outdoors, going to movies, doing DIY projects around their house, visiting local restaurants, and relaxing at their favorite spot: home. They also love spending time and energy keeping up with their 6-year-old son, who is definitely turning out just like his parents. Well played, karma. Well-played.
JANUARY/FEBRUARY 2024
VOLUME 41 // ISSUE VIII
EDITORIAL
Editor-in-Chief
KIM CARPENTER
Senior Writer
JULIUS FREDRICK
Associate Editor & Staff Writer
NATALIE VELOSO
Assignment Editor & Staff Writer
CLAUDIA MOOMEY
Contributing Writers
LEO ADAM BIGA · TAMSEN BUTLER · DAISY HUTZELL-RODMAN
CHRISTOPHER J. MCLUCAS · CAROL NIGRELLI
VERONICA WORTMAN PLOETZ
KARA WESELY · LISA LUKECART · HOLLY MCATEE
SAMANTHA & DAMIAN INGERSOLL
DOUGLAS “OTIS TWELVE” WESSELMANN
CREATIVE
Creative Director
RACHEL BIRDSALL
Senior Graphic Designer
RENEÉ LUDWICK
Graphic Designer II
NICKIE ROBINSON
Graphic Designer I
JOEY WINTON
Contributing Photographer
SARAH LEMKE
SALES DEPARTMENT
Executive Vice President
Sales & Marketing
GIL COHEN
Branding & Digital Specialists
DAWN DENNIS · GEORGE IDELMAN
GREG BRUNS · TIM McCORMACK
FRANCINE FLEGG
Publisher’s Assistant & OmahaHome Contributing Editor
SANDY MATSON
Senior Sales Coordinator
ALICIA HOLLINS
Sales Coordinator SANDI M cCORMACK OPERATIONS
Business Manager KYLE FISHER
Ad Traffic Manager
DAVID TROUBA
Digital Manager
LUIS DE LA TOBA
Distribution Manager
DAMIAN INGERSOLL EXECUTIVE
Executive Publisher TODD LEMKE
Associate Publisher
For Advertising & Subscription Information :
BILL
SITZMANN
402.884.2000 Omaha Magazine Vol 41 Issue VIII, publishes monthly except February, April, August, December, totaling 8 issues by Omaha Magazine, LTD, 5921 S. 118 Circle, Omaha, NE 68137. Periodical postage at Omaha, NE, and additional offices and additional mailing offices. POSTMASTER: Send address changes to Omaha Magazine, 5921 S. 118 Circle, Omaha, NE 68137 // 4 // MARCH/APRIL 2024
STAY IN THE KNOMAHA!
The metro is jam packed with tons do—art, concerts, theater, festivals—we’ve got you covered with our comprehensive list and highlighted picks!
COMPILED BY NATALIE VELOSO
Music Art Festival

LATIN FIRE
Holland Performing Arts Center
March 2-3
1200 Douglas St. ticketomaha.com
Led by Enrico Lopez-Yañez, Nashville Symphony's Principal Pops Conductor and former Assistant Conductor of the Omaha Symphony, this evening allows listeners to immerse themselves in the vibrant celebration of Latin American music with "Latin Fire." Th is three-piece ensemble, composed of acclaimed musicians deeply rooted in Spanish-speaking cultural treasures, delivers an exhilarating performance. Expect renditions of classics like “Estrellita,” “Bésame Mucho,” and selections from "Carmen," all conducted and curated by Lopez-Yañez. Featuring trumpeter Jose Sibaja, known for collaborations with Celia Cruz, Ricky Martin, and Gloria Estefan, alongside soprano Monica Abrego, this fiery concert, ignited by the infectious energy of Latin music, promises an irresistible rhythm that will have you on your feet. 402.345.0202

NEO-CUSTODIANS: WOVEN NARRATIVES OF HERITAGE, CULTURAL MEMORY, AND BELONGING
Bemis Center for Contemporary Arts
Through April 14
Admission: Free 724 S 12th St. bemiscenter.org
Showcasing 13 artists utilizing textiles as a medium of expression, this exhibition reimagines notions of migration, identity, and environmental sustainability. Th rough the works of El Anatsui, Malene Barnett, Layo Bright, and others, materials entrenched in rich histories uncover buried narratives, each artist assuming the role of a custodian for often disregarded stories. Their art weaves cultural, social, and political significance into contemporary contexts, inviting visitors to explore these multifaceted threads throughout the free exhibition. Dive into this showcase where intricate textiles serve as vessels, rewriting and illuminating complex tales, urging contemplation on the deeper layers of uncelebrated histories and their relevance in today's world. 402.341.7130

RALSTON SPRING FESTIVAL ART & CRAFT SHOW 2024
Liberty First Credit Union Arena
April 5–7
7300 Q St.
libertyfi rstcreditunionarena.com
The Ralston Spring Festival Art & Craft Show is an annual event organized by Huff man Productions in Ralston, NE, welcoming attendees across a three-day span. Th is regional extravaganza celebrates artistry and craftsmanship, featuring a diverse array of creations from talented artisans representing the region. Exhibitors gather to present their distinctive works, engaging with potential patrons and forming connections. Spanning a wide spectrum of arts, crafts, and gifts, the show ensures an inclusive appeal, catering to varied tastes and interests. The Ralston Spring Festival Art & Craft Show stands as a prime platform for exhibitors to display their artistry, forging lasting bonds with attendees. Th is event is not to be missed—a splendid opportunity to revel in creativity and connect with skilled artisans! 402.934.9966
MARCH/APRIL 2024 // 5 //
9 16 23
L D C E A of 8 15 22
EVENTS
» Exhibitions «
OMAHA LAWN, FLOWER, & PATIO SHOW
March 1, 11 am–8 pm, at CHI Health Center, 455 N 10th St. Welcome spring at the 58th Annual Omaha Home & Garden Expo! Discover the latest home products, fi nd inspiration, and explore blooming gardens, water features, and entertainment all in one place. Dive into the season's spirit by exploring an array of cutting-edge products and services for your home, all conveniently housed under one roof. From master gardener advice to garden club displays, gather ideas and insights for your own lawn and garden at this vibrant event. 402.341.1500
—chihealthcenteromaha.com
WORLD OF WHEELS
March 8–10 at CHI Health Center, 455 N 10th St. World of Wheels is back! Get ready for the 69th annual O’Reilly Auto Parts showcase at the CHI Health Center, spotlighting the best Hot Rods, Custom Cars, Trucks, and Motorcycles in America. Experience Gravity Falls Valve Cover Racing, thrilling BMX stunts, and non-stop car audio demos throughout the entire weekend! 402.341.1500
—chihealthcenteromaha.com
GALLERY TALK: “THE PROCESS OF PRINTMAKING”
March 9, 1:15 pm, at El Museo Latino, 4701 S 25th St. Experience the museum’s latest Gallery Talk detailing “Th e Process of Printmaking,” presented by Howard Paine, an Associate Professor and the Head of Printmaking at the University of Nebraska at Omaha. Paine has been integrating digital imaging and traditional printmaking processes for 25 years, and his work has been exhibited nationally and internationally. 402.731.1137
—elmuseolatino.org
“THE MARVEL OF OLD MASTERS: REMBRANDT, GOYA, AND DÜRER”
rough March 16, 1–3 pm, at El Museo Latino, 4701 S 25th St. El Museo Latino's visiting exhibition “The Marvel of Old Masters: Rembrandt, Goya, and Dürer” depicts themes including landscapes, biblical stories, portraits, and more. Included in this exhibition is a selection of 22 works by the Dutch artist Rembrandt van Rijn, 32 works by the Spanish artist Fransisco Goya, and 11 works by the German artist Albrecht Dürer. Their crafted etchings and prints are akin to captivating photographs. 402.731.1137 —elmuseolatino.org
GREATER OMAHA ORCHID SOCIETY ORCHID SHOW AND SALE
March 23–24 at Lauritzen Gardens, 100 Bancroft St. Experience the annual Orchid Show and Sale hosted by the Greater Omaha Orchid Society at Lauritzen Gardens. Discover a stunning array of orchid displays curated by local, regional, and national vendors and growers. Accredited judges from the American Orchid Society will select prize-winning orchids while visitors can engage with local orchid experts about these captivating plants. Learn more about their unique requirements—light, moisture, temperature, and more—to foster a deeper understanding of their care and cultivation. 402.346.4002 —lauritzengardens.org
PAOLO ARAO: REVERBERATIONS
rough April 14 at Bemis Center for Contemporary Arts, 724 S 12th St. Visit this free exhibition to experience artist Paolo Arao’s sewn paintings, weavings, and site-responsive installations that are rooted in geometric abstractions. Th is exhibition showcases the Filipino-American artist’s work over the past fi ve years centered on a cross-cultural and queer perspective, including work he began as a resident at Bemis Center in 2020. 402.341.7130 —bemiscenter.org

// 6 // MARCH/APRIL 2024
A N R 7 14 21



F O O D F E AT U R E S . C H E F P R O F I L E S . R E S TA U R A N T R E V I E W S O M A H A M AGA Z I N E .C O M HUNGRY? MARCH/APRIL 2024 // 7 //

FRIDA KAHLO AND THE BLUE HOUSE
April 5—July 27 at El Museo Latino, 4701 South 25th St. Th is exhibition presents a selection of over 60 color photographs of the architecture and interior spaces of the Blue House created by Kahlo as well as vintage black-and-white photographs taken by Diego Rivera, Antonio Kahlo, Lola Álvarez Bravo, Florence Arquin, and Juan Guzmán. Opening reception: April 5, 5 to 7 pm; Gallery talk by Frida Kahlo’s great grand niece, Cristina Kahlo: April 5, 6 pm. 402.731.1137 —elmuseolatino.org
Concerts
STEVIE NICKS: LIVE IN CONCERT
March 3, 7 pm, at CHI Health Center, 455 N 10th St. Catch legendary Rock and Roll Hall of Fame member Stevie Nicks live in concert this March. The iconic singer, songwriter, and former Fleetwood Mac icon has expanded her ongoing tour into 2024 with seven additional performances across the country, including Omaha. With eight Grammy Award nominations and two American Music Award nominations as a solo artist, Nicks also earned a Grammy for Album of the Year in 1978 for the timeless classic "Rumours." 402.341.1500 —chihealthcenteromaha.com
TOBYMAC’S HITS DEEP TOUR
March 7, 7 pm, at Baxter Arena, 2425 S 67th St. Bring the family to Baxter Arena for TobyMac’s Hits Deep 2024 Tour. Top artists join forces for an unforgettable experience! Featuring TobyMac, Cory Asbury, Mac Powell, Tasha Layton, Jon Reddick, and Terrian, this show guarantees a musical odyssey like none other. TobyMac, renowned as an American contemporary Christian music luminary—singer, rapper, songwriter, and record producer—leads this dynamic lineup for an electrifying event. 402.554.6200 —baxterarena.com
BRETT YOUNG: DANCE WITH YOU TOUR
March 8, 7:30 pm, at Steelhouse Omaha, 1100 Dodge St. Hailing from Orange County, California, Brett Young is celebrated as a top-tier American country pop singer, songwriter, and guitarist, renowned for his emotive ballads. His latest tour derives its name from his hit song, "Dance With You." 402.345.0606 —steelhouseomaha.com
RAJATON: THE MUSIC OF ABBA
March 8–9 at Holland Performing Arts Center, 1200 Douglas St. Finnish a cappella sensation Rajaton teams up with the Omaha Symphony for an electrifying concert showcasing ABBA's iconic hits like “Mamma Mia” and “Dancing Queen.” ABBA's legendary status as one of music's best-selling acts has left an indelible mark worldwide. Rajaton, known for their touring success, brings ABBA's timeless tunes to life, promising an unmissable experience. Join the Omaha Symphony and Rajaton for an unforgettable evening featuring hits like “Take a Chance on Me,” “Voulez-Vous,” and many more. 402.345.0202 —ticketomaha.com
EXCISION: NEXUS TOUR
March 10, 6:15 pm, at Steelhouse Omaha, 1100 Dodge St. Excision, the Canadian DJ and electronic music producer, arrives in Omaha for the 2024 Nexus Tour, promising his most colossal tour production to date. With his trademark bass music and stage technology, Excision is electrifying the country. Fans in every city will encounter the complete Excision concert experience for the fi rst time, marking an unparalleled musical journey. 402.345.0606
—steelhouseomaha.com
OLIVIA RODRIGO: GUTS WORLD TOUR
March 13, 7:30 pm, at CHI Health Center, 455 N 10th St. At just 21 years old, singer-songwriter and actress Olivia Rodrigo is set to dazzle Omaha with her chart-topping hits. Building on the triumph of her 2022 debut tour, The SOUR Tour, the GUTS world tour marks her inaugural arena tour. GUTS follows Rodrigo's 4x Platinum 2021 debut album, “SOUR,” continuing her meteoric rise in the music scene. Th is concert promises a spectacular showcase of Rodrigo's evolving talent and sensational melodies for Omaha's audience. 402.341.1500
—chihealthcenteromaha.com
ALICIA VILLAREAL: DONDE TODO COMENZÓ
March 8, 7:30 pm, at Steelhouse Omaha, 1100 Dodge St. Grammy-winning Mexican artist Alicia Villarreal kicks off her much-anticipated, 16-city Donde Todo Comenzó tour on an Omaha stage. Aptly named "Where It All Began," the tour invites fans to relive Villarreal's triumphant career, exploring the origins of her music alongside her latest chart-toppers. Enjoy a blend of Villarreal's timeless classics and recent hits, an unforgettable ode to her musical journey. 402. 345.0606 —steelhouseomaha.com
APPALACHIAN SPRING
March 17, 2 pm, at Strauss Performing Arts Center, 6305 University Dr N. Experience an “Appalachian Spring” concert with maestro Paul Haas leading the Omaha Symphony. Delight in Aaron Copland’s Pulitzer Prize-winning suite, adapted for 13 instruments to resonate with the essence of the original orchestral score. Th is rendition evokes the spirit of the American frontier, exuding themes of hope and new beginnings. 402.554.3411
—unomaha.edu
COPLAND’S RODEO
March 22–23 at Holland Performing Arts Center, 1200 Douglas St. Join Music Director Ankush Kumar Bahl and the Omaha Symphony for an enchanting evening featuring American and British musical luminaries. Barber's overture to "The School for Scandal" sets a satirical tone, contrasting Britten's “Four Sea Interludes” and “Passacaglia” from Peter Grimes, capturing the sea's diverse moods and the protagonist's inner turmoil. Concluding the performance, revel in Pulitzer Prize-winner Caroline Shaw's lighthearted “Entr’acte" and Aaron Copland's spirited “Rodeo,” a vibrant ode to the American West, evoking cowboys, rodeos, and expansive prairie landscapes. 402.345.0202
—ticketomaha.com
CARNIVAL OF THE ANIMALS
March 24, 2 pm, at Holland Performing Arts Center, 1200 Douglas St. The Holland comes alive with a musical zoo adventure courtesy of the Omaha Symphony and the Henry Doorly Zoo and Aquarium. From the regal lion to the playful donkey, join in the orchestra's rendition of SaintSaens' “Carnival of the Animals,” brimming with animal-themed melodies. Th is delightful concert promises an engaging experience for children, captivating their imaginations as they journey through a musical menagerie fi lled with a variety of beloved creatures. 402.345.0202
—ticketomaha.com
BRIAN CULBERTSON: THE TRILOGY TOUR
March 24, 7 pm, at Steelhouse Omaha, 1100 Dodge St. Renowned for his fusion of smooth jazz, R&B, and funk, musician and producer Brian Culbertson has carved a distinctive path in music, skillfully playing the synthesizer, piano, and trombone. "The Trilogy" comprises 30 of his compositions across three albums, chronicling the stages of a relationship. The Trilogy Tour is set to showcase a blend of tracks from these albums, alongside his greatest hits, off ering a captivating journey through his extensive musical repertoire. 402.345.0606
—steelhouseomaha.com
// 8 // MARCH/APRIL 2024
QUEEN OF THE NIGHT: A TRIBUTE TO WHITNEY HOUSTON
March 30, 7:30 pm, at Steelhouse Omaha, 1100 Dodge St. Prepare for an unforgettable Whitney Houston tribute in Omaha, delivering an unparalleled experience. Th is remarkable production features powerhouse performances that captivate audiences, earning accolades as a concert that exceeds expectations. Embark on a nostalgic journey spanning three decades of iconic hits like "I Wanna Dance With Somebody," "One Moment In Time," "I’m Every Woman," "I Will Always Love You," "My Love Is Your Love," "So Emotional Baby," and more. Enjoy an exceptional evening honoring the Queen of Pop, featuring a sensational cast and an incredible live band. 402.345.0606
—steelhouseomaha.com

FALL OUT BOY: SO MUCH FOR (2OUR) DUST
April 5, 6:30 pm, at CHI Health Center, 455 N 10th St. American rock band Fall Out Boy is stopping in Omaha for their 2024 tour, So Much for (2our) Dust. The tour boasts special guests including Jimmy Eat World, Hot Mulligan, and CARR. Originating from Wilmette, Illinois, a suburb of Chicago, the band was founded in 2001 and includes lead vocalist and rhythm guitarist Patrick Stump, bassist Pete Wentz, drummer Andy Hurley, and lead guitarist Joe Trohman. 402.341.1500
—chihealthcenteromaha.com
DAN + SHAY: HEARTBREAK ON THE MAP TOUR
April 6, 2 pm, at CHI Health Center, 455 N 10th St. The country pop music duo Dan + Shay are set to stop in Omaha on their 2024 The Heartbreak On The Map Tour. Composed of vocalists and songwriters Dan Smyers and Shay Mooney, the duo has released fi ve albums to date and won three Grammy Awards. 402.341.1500
—chihealthcenteromaha.com
STAR WARS: THE FORCE AWAKENS IN CONCERT
April 6–7 at Holland Performing Arts Center, 1200 Douglas St. Join the Omaha Symphony for an epic presentation of Star Wars: The Force Awakens in Concert, combining a screening of the entire 2015 fi lm with a live performance of Oscar®-winning composer John Williams' iconic score. Relive the saga on screen as the orchestra brings the music to life to encapsulate the fi lm's magic. Resident Conductor and Principal Pops Conductor Ernest Richardson will lead this thrilling concert experience, transporting audiences into the Star Wars universe with this unforgettable cinematic and musical fusion. 402.345.0202
—ticketomaha.com
JOHN MELLENCAMP
April 7, 8 pm, at Orpheum eater, 409 S 16th St. John Mellencamp, previously known as John Cougar, is an American singer-songwriter known for his catchy brand of heartland rock, which emphasizes traditional instrumentation. Mellencamp’s most famous music is full of passion, heart, and an understanding of the lives of ordinary folks living in the American Midwest, fusing the bold punch of arena-ready rock with defi ant, thoughtful songwriting. 402.661.8501 —ticketomaha.com
MARCOS EDUARDO’S LATINO MUSIC EXPLOSION
April 12, 7:30 pm, at Holland Performing Arts Center, 1200 Douglas St. Don't miss out on a Latino Music Explosion in Omaha—a dynamic showcase boasting four singers, two guitars, bass, drums, keys, two dancers, percussion, and a horn player. Delight in the vibrant beats and melodies of cumbia, bachata, norteño, and other beloved Latin American genres performed by a talented ensemble of musicians hailing from South Omaha. Get ready to groove to the infectious sounds and rhythms of this sensational celebration of Latino music. 402.345.0202
—ticketomaha.com
MICHAEL BOLTON
April 13, 7:30 pm, at Holland Performing Arts Center, 1200 Douglas St. Experience some of the unforgettable melodies that defi ne life's moments—from Michael Bolton's chart-toppers like "When a Man Loves a Woman" to "How Am I Supposed to Live Without You." Join this Grammy Award-winning artist for a musical odyssey spanning pop, rock, soul, standards, and even classical tunes. Renowned for his emotive voice and poignant lyrics, the multiple Grammy Award-winner will perform alongside the Omaha Symphony, conducted by Maestro Ankush Kumar Bahl. Expect soulful renditions enriched by the orchestra's grandeur, while Bolton infuses his energy and passion into this performance. 402.345.0202 —ticketomaha.com
JOURNEY: FREEDOM TOUR 2024
April 15, 7:30 pm, at CHI Health Center, 455 N 10th St. Legendary rock icons Journey take the stage in Omaha this spring. Marking their 50th anniversary with the Freedom Tour 2024, the band brings their electrifying performance on April 15, joined by special guest Toto. Emerging from San Francisco in 1973, Journey was founded by ex-members of Santana, Steve Miller Band, and Frumious Bandersnatch, delivering decades of unforgettable music. 402.341.1500 —chihealthcenteromaha.com
BOYWITHUKE: LUCID DREAMS TOUR
April 19 at e Admiral eater, 2234 S 13th St. At 21 years old, Charley Yang, also recognized as BoyWithUke, stands as a Korean-American singer, musician, and internet sensation. Rising to fame through TikTok, Yang captivated audiences with his track "Two Moons," later unveiling hits like "Toxic" and "Understand." His online presence and musical prowess have propelled him into the spotlight, marking him as a notable fi gure in the digital music realm. 402.345.7569
—admiralomaha.com
WILKINS RETURNS
April 19–20 at Holland Performing Arts Center, 1200 Douglas St. Thomas Wilkins, Music Director Laureate of the Omaha Symphony and Principal Conductor of the Hollywood Bowl Orchestra, returns to Omaha for a captivating performance. Leading both evenings, Wilkins conducts the recently unearthed masterpiece, William Dawson’s “Negro Folk Symphony” in a blend of folk tunes and extraordinary orchestral resonance. 402.345.0202
—ticketomaha.com

ETIENNE CHARLES: EARTH TONES
April 26, 7:30 pm, at Holland Performing Arts Center, 1200 Douglas St. Earth Tones, a multimedia jazz showcase, presents original compositions spotlighting communities and areas at the forefront of climate change impacts. Etienne Charles, a versatile performer, composer, and storyteller, delves into untold narratives through sound. His acclaimed album, "Creole Soul," blends Afro-Caribbean roots, earning global acclaim for its fusion of authentic rhythms. Th is performance documents and highlights regions aff ected by climate change, embracing his quest to weave together unheard stories with rich, soulful melodies. 402.345.0202
—ticketomaha.com
MARCH/APRIL 2024 // 9 //
ZACH BRYAN: THE QUITTIN’ TIME TOUR
April 29–30 at CHI Health Center, 455 N 10th St. Set for a two-day stop in Omaha, Grammy-nominated country sensation Zach Bryan headlines his Th e Quittin’ Time Tour. Joining him for the Omaha show are special guests The Middle East and Levi Turner. Hailing from Oologah, Oklahoma, the 27-year-old singer-songwriter has made waves in American country music. His debut album, "American Heartbreak," stormed into the U.S. Billboard 200, securing the fi fth spot and cementing his status as a rising star in the genre. 402.341.1500 —chihealthcenteromaha.com
THE STRUMBELLAS
April 30 at e Waiting Room Lounge, 6212 Maple St. Originating from Lindsay, Ontario, The Strumbellas are a Canadian alternative country ensemble composed of Simon Ward, David Ritter, Jon Hembrey, Izzy Ritchie, Darryl James, and Jeremy Drury. Established in 2008, their musical style traverses alternative country, indie rock, farm emo, and gothic folk genres, showcasing a diverse sonic palette that resonates with audiences worldwide. 402.884.5353 —waitingroomlounge.com
STAGE PERFORMANCES

THE LION KING
March 1–24 at Orpheum eater, 409 S 16th St. Don't miss The Lion King at the Orpheum Th eatre—a spectacular showcase of artistry, music, and choreography. Th is multi-awardwinning Best Musical follows Simba's extraordinary evolution from outcast Prince to the majestic ruler of the animal kingdom. Th is live production enhances the story’s storytelling and character depth. An unmissable experience, this show promises memories to last a lifetime. 402.661.8501
—ticketomaha.com
KEN LUDWIG’S BASKERVILLE: A SHERLOCK HOLMES MYSTERY
March 8–30 at Omaha Community Playhouse, 6915 Cass St. Don't miss the mystery of Baskerville—a captivating show packed with rapid transformations and eccentric characters. Witness fi ve actors skillfully portray over 40 characters, breathing life into this classic novel. Join Sherlock Holmes and Watson in their quest to unravel the enigmatic Baskerville family curse. With an energetic take on the classic Sherlock Holmes tale, this whodunit promises a delightful, edge-of-your-seat experience from beginning to end. 402.553.0800
—omahaplayhouse.com
SHEN YUN
March 26–27 at Orpheum eater, 409 S 16th St. Discover Chinese history through Shen Yun's performance celebrating virtues, wisdom, and goodness with timeless legends steeped in valor and traditional ideals. Based in New York, Shen Yun aims to revive 5,000 years of civilization, blending classical Chinese dance's expressiveness and athleticism with innovative stagecraft, an East-West live orchestra, and pioneering backdrops. Each year, Shen Yun unveils a groundbreaking production that captivates audiences worldwide. 402.661.8501 —ticketomaha.com
TREY KENNEDY: GROW UP
March 27, 7 pm, at Steelhouse Omaha, 1100 Dodge St. Comedian Trey Kennedy brings his Grow Up Comedy Tour to Steelhouse Omaha. Kennedy is a comedian, actor, and singer, known best for his YouTube and TikTok videos. Experience a night of laughter and the relatable themes of Kennedy’s popular skits. 402.345.0606 —steelhouseomaha.com
BROTHERS OSBORNE
March 29, 8 pm, at Steelhouse Omaha, 1100 Dodge St. Brothers Osborne hit Omaha with their Might As Well Be Us Tour. Fresh from a nomination at the 66th annual Grammy Awards for Best Country Album and Best Country Duo/ Group Performance with "Nobody’s Nobody," the duo arrives with their self-titled fourth studio album. Showcasing their distinct fusion of classic Southern rock and refi ned modern country, the album underscores the brothers' signature sound, promising a remarkable evening fi lled with their trademark musical blend. 402.345.0606 —steelhouseomaha.com
CABARET
rough March 30 at Omaha Community Playhouse, 6915 Cass St. With 12 Tony Awards, including Best Musical and Best Revival, Cabaret stands as an iconic and pioneering musical of the 20th Century. Set against the rise of the Nazi party in Germany, the magnetic Emcee invites audiences to the Kit Kat Klub with the famous “Willkommen.” Witness the gripping tale as performer Sally Bowles encounters an American writer in this seedy world. Th rough timeless melodies like “Maybe this Time” and “Cabaret,” be transported to an era rich with unforgettable musical moments. 402.553.0800 —omahaplayhouse.com
FLIP FABRIQUE: BLIZZARD
April 2, 7 pm, at Orpheum eater, 409 S 16th St. FLIP Fabrique presents Blizzard—an enchanting, poetic voyage through the wintry depths. Embark on a journey with this circus company based in Québec, Canada, as performers showcase their artistry. With stunning visual poetry, Blizzard is poised to sweep everything in its path, delivering an extraordinary experience that transports audiences to a realm of absolute fascination. 402.661.8501
—ticketomaha.com
TAIKOPROJECT
April 6, 7:30 pm, at Orpheum eater, 409 S 16th St. For over two decades, TAIKOPROJECT has captivated global audiences with their fusion of traditional taiko and innovative artistic expression. Combining percussive prowess, dynamic melodies, and elegant choreography, they craft a mesmerizing narrative. Prepare for a journey that intertwines the power of percussion, evocative music, and graceful movements—an enthralling spectacle that transcends expectations. 402.661.8501
—ticketomaha.com
RANDY RAINBOW FOR PRESIDENT
April 7, 7:30 pm, at Steelhouse Omaha, 1100 Dodge St. Comedian Randy Rainbow, a fourtime Emmy and Grammy nominee, brings his Randy Rainbow for President Tour to Omaha. With his trademark musical comedy, Rainbow tackles current aff airs, lampooning political fi gures with his unique fl air. His live show showcases popular viral video song parodies performed on stage, accompanied by talented Broadway musicians. Th is event promises a hilarious take on the hottest topics and a chance to witness Rainbow's comedic genius in action. 402.345.0606
—steelhouseomaha.com
// 10 // MARCH/APRIL 2024
ERTH’S DINOSAUR ZOO LIVE
April 12, 6:30 pm, at Orpheum eater, 409 S 16th St. Erth invites audiences on an awe-inspiring journey through a prehistoric realm. Witness astonishingly realistic dinosaurs and creatures in a theatrical spectacle led by a team of adept performers and puppeteers. Crafted in collaboration with paleontologists, this show brings a mesmerizing world to the stage, off ering an immersive experience that showcases lifelike renditions of ancient creatures, promising a blend of science and entertainment. 402.661.8501
—ticketomaha.com
UNBREAKABLE: A NEW MUSICAL
BY ANDREW LIPPA
April 13, 7:05 pm, at Orpheum eater, 409 S 16th St. Experience the River City Mixed Chorus and their guest performers as they present "Unbreakable," composed by Tony Award-nominated Andrew Lippa. Th is grand choral and theatrical piece debuted in 2018 with the San Francisco Gay Men’s Chorus' 40th anniversary. In its own 40th season, RCMC unveils the mixed chorus rendition, a musical odyssey spanning 12 decades of LGBTQ+ history. Lippa's 14-part, multimedia opus celebrates unsung heroes, tragedies, triumphs, and the indomitable spirit of a community. 402.661.8501
—ticketomaha.com

PRETTY WOMAN: THE MUSICAL
April 16–21 at Orpheum eater, 409 S 16th St. "Pretty Woman: The Musical," inspired by Hollywood's cherished romantic tale, comes alive through a dynamic creative team spearheaded by Jerry Mitchell, a two-time Tony Award®-winning director and choreographer renowned for his work in productions like "Hairspray" and "Legally Blonde." Th is stage adaptation promises to breathe new life into the beloved story, delivering a theatrical experience under the guidance of Mitchell's exceptional vision and expertise in bringing stories to life on stage. 402.661.8501 —ticketomaha.com

BLIPPI: THE WONDERFUL WORLD TOUR!
April 14, 2 pm, at Orpheum eater, 409 S 16th St. Blippi is coming to Omaha for the ultimate curiosity adventure in Blippi: The Wonderful World Tour! Come dance, sing, and learn with Blippi and special guest Meekah as they discover what makes diff erent cities unique and special. 402.661.8501
—ticketomaha.com
CHICKEN AND BISCUITS
April 19–May 12 at Omaha Community Playhouse, 6915 Cass St. Discover the unexpected hilarity in a funeral turned uproarious gathering in this heartwarming family comedy. As the Jenkins family reunites to honor their patriarch's life, hidden secrets emerge. Amidst the chaos, confl icting family members are pushed to embrace each other wholly—their virtues, fl aws, and comical quirks. Chicken and Biscuits showcases the journey of acceptance, emphasizing the enduring bonds and devotion within a family, proving that amidst the laughter, love remains the cornerstone of this tale. 402.553.0800 —omahaplayhouse.com
MORE:
OMAHA FILM FESTIVAL
rough March 3 at Aksarben Cinema, 2110 S 67th St. Join Omaha Film Festival (OFF) for its 19th year and witness an array of extraordinary talent. Celebrating cinematic excellence, the festival curates a rich tapestry of over 100 fi lms. The diverse lineup spans narrative features, documentaries, short fi lms, and animated gems, alongside a dedicated showcase spotlighting Nebraska's own fi lm creations. OFF promises an immersive experience, off ering a glimpse into the captivating world of storytelling through the lens of exceptional fi lmmakers from around the world. —omahafi lmfestival.org
ART & SOUP 2024
March 10, 2–5 pm, at Omaha Design Center, 1502 Cuming St. The Visiting Nurse Association eagerly presents the 27th Annual Art & Soup fundraiser at the Omaha Design Center. Th is vibrant event invites community participation, off ering a diverse collection of art genres for purchase, a compelling array of auction items on which to bid, and a culinary delight with unique soups crafted by top chefs from Omaha and Council Bluff s. Join us for a day fi lled with art, auctions, and fl avors that celebrate creativity and community support. 402.930.4000 —vnatoday.org
OMAHA SUPERNOVAS
March 14, 16, 28, and 30; April 4, April 20, April and 26 at the CHI Health Center, 455 N. 10th St. Come cheer on Omaha’s newest professional sports team, the Omaha SUPERNOVAS. Nebraska’s only professional women’s sports team, the SUPERNOVAS made their debut in February with record attendances. In it’s inaugural season, the pro Volleyball Federation and Nebraska Pro Volleyball added the Supernova’s ( a tribute to the night skies over Nebraska) as part of a seven-team league in July 2023 for the start of the 2024 season. 402.641.1500 —provolleyball.com/teams/omaha-supernovas
TAILS 'N TRAILS
April 27 at Chalco Hills Recreation Area, 8901 S 154th St. Bring your best furry friend along for this race! The Half Marathon, 10k, 5k, and 1 Mile Walk as part of Tails 'n Trails are all about fun and family, including your beloved pets. Every contribution from this event goes directly to aid fi ve local non-profit animal rescues, ensuring a paw-sitive impact for local animals in need. 402.444.6222 —tailsntrailsomaha.com

Would you like weekly event recommendations delivered right to your inbox? Open the camera on your smart device and hover over the QR code (left) to subscribe to Omaha Magazine ’s Weekend Entertainment Guide online.
MARCH/APRIL 2024 // 11 //
KINGKing ISO ISO KINGKINGISOISOKINGISOKING ISO KING

KINGISO
STORY
BY CHRISTOPHER J. MCLUCAS
PHOTOGRAPHY BY BILL SITZMANN
DESIGN BY RENEE LUDWICK
KingISOKING ISOKINGISO ISOKINGISOKING KINGKINGISOKING KINGISOKING ISO KING KING REIGNING WITH EMPATHY
ISO A/C MUSIC JANUARY/FEBRUARY 2024 // 13 //

ing Iso didn’t just stand out because he had just become the second Black person in the coffee shop, the first being me. He commanded attention due to his calm and welcoming aura. Rap music has a connotation of being a violent medium, but when Johnny Cash sang, “I shot a man in Reno just to watch him die,” that was somehow more folksy than a mirror to society. Rap is always viewed through a different lens.
Iso, though, uses rap to explore issues typically not associated with the genre. Childhood trauma, mental health struggles, suicidal depression those are the heavy themes with which the rapper grapples.
More humble than a Buddhist monk and as cheerful as Santa Claus, the 34-yearold rapper, who was born Tarrel Gulledge in Omaha, manages his mental health struggles through musical alchemy. After generating millions of streams and having every music venue in which he performs heaving with energy, Iso decided to issue a call for healing to troubled generations. In late October 2023, he debuted one of his most personal and critically-acclaimed albums, simply titled, “iLLdren.” He produced and collaborated with producers and artists like Tech N9ne and Matt Phoenix for the release, splitting the album into three concepts: Baby Blues, Teen Trauma, and Adult Adversity. He dedicated the latter to his young son, Andreas, telling the story of his level one autism diagnosis and experience.
Tracks are intensely personal. In “Nightmare,” Iso opens up about his own struggles: “One day I’ll wake, one day I’ll pray / One day I’ll wake up from this nightmare.” The track “Way You Are” speaks to his son’s diagnosis, as well as others “on the spectrum, or dealing with autism,” creating an anthem for them that avers: “You are not sick. You are fine just the way you are.”
K
"Have those uncomfortable conversations with yourself & the people in your life. You will feel better when you do.”
-King Iso

Those kinds of words carry power, especially in a genre not often considered a platform for promoting mental health.
Iso’s lyrics have resonated with his fans, or “Isoldiers.” One heartfelt comment under the video for “Way You Are” on YouTube stated: “I love your music, Iso. I’m 30 and autistic and super depressed. Your music has helped me so much. I don't know how many hours I've spent memorizing your lyrics. Not only are they super relatable to me, but they are fast enough to engage my neurodivergent brain.
And your speed and unique flows are unmatched. Thank you.”
Another added, “Aside from the beautiful message in the song, can we please APPRECIATE THAT DROP! He always has these crazy build ups and the greatest drops with flows to match and this one was fire.”
V13 Media critic Aaron Willschick hailed the autobiographical release as “one of the most powerful albums of the year.” He went on to write, “With this album, King Iso proves that he’s not just a rapper; he’s a modern-day bard whose tales are as enlightening as they are entertaining.”
Iso remains humble about such effusive praise. “We have to speak life over ourselves. When you have
moments when you don't understand something, give yourself protection, awareness, and love to know that bad moments don't define you,’” he reflected. “On the front of the album art you can see the words, ‘You are not your childhood trauma.’”
Iso, indeed, is so much more. His discography is a road map of pain and growth. His six albums weave a lyrical narrative about surviving an upbringing beset by mental and physical obstacles, suicide attempts, incarceration, and homelessness.
“Before I was able to put what I felt into a song format, I used to journal. I would take my mom’s big yellow legal pads and write poetry. I got introduced to hip-hop in ’93,” Iso said. “I would write down the lyrics to my favorite songs and try to emulate their cadences to write down what I was feeling.”
Justin Strawstone, Iso’s tour manager, spoke with me over the phone. He practically spilled out of the receiver, the positive energy he gave not only for King Iso but everyone under the umbrella of his company, Nice Enough Entertainment. “I’m not a Strange Music guy, I’m a King Iso guy,” he enthused.
Strawstone told me how he and Iso got to know each other through Omaha’s rap-battle scene and developed mutual respect for one another. When they met some years after, it felt natural to work together. “We did 260 shows in 2023, and we’re currently building his ‘iLLdren’ tour for next spring,” he said. “The music King Iso makes is a heavy undertaking; it’s a precious burden. His fans have gone through similar or more challenging experiences. It can be a lot to take on. I hope he looks after himself.”
As Iso removed his glasses to clean them, he revealed tattoos above his eyebrows: on the right, “mental;” above the left, “health.” They are a message to the people who meet him or happen to glance at him in passing. He isn’t a billboard; he’s putting himself
into the thick of it, with V.I.P. sessions during his tour and being a present father. He understands who he is and how he’s perceived.
“I finished an all-ages show in Tempe, Arizona, there was this little girl had to be about 5 or 6 and she was waiting with her mother, and I stopped and asked her: ‘What do you want to be when you grow up?’ She said: ‘I want to be like you when I grow up.’ That was a mouthful. All I could think about was all the horrible stuff I had done, but what she sees is the hero, the leader, the advocate for mental health. I don’t want her to think I’m perfect or anything. I just want to be responsible.”
After he spoke those words, it was clear that not only is he a king, but a big brother of sorts to the world as well. “King Iso has openers for his shows, and he doesn’t have to do that,” Strawstone shared. “He remembers being homeless and hungry, artistically and physically. He gives people who were like him a shot.”
This journey is what led the rapper to create “iLLdren” and spaces for conversations around mental health for all ages.
“You can’t heal until you feel. I put down the drugs and alcohol, and a lot of my childhood trauma started to pop back up,” Iso shared. “I checked myself in a mental health facility to get a reset. When I got in, there were so many children 15, 16 babies. They speak about themselves as if it’s over, that they're always going to be sick, and not just the children, but people of every age. ‘iLLdren’ is a gateway to a thought process; this album is about running towards what triggers us.”
Iso paused and issued this decree: “Have those uncomfortable conversations with yourself and the people in your life. You will feel better when you do.”
The King has spoken.
Follow King Iso on Instagram @therealkingiso.
A/C MUSIC
MARCH/APRIL // 15 // 2024
RACHEL D. FOX LIVES TO UPLIFT

REST, REFLECT, REJUVENATE

Contagious joyful energy radiates from Rachel D. Fox, and spending time in her presence is refreshing and invigorating. As a woman of many interests, she manages numerous passion projects and wears many hats, including mother, wife, author, podcaster, entrepreneur, keynote speaker, and the founder of a nonprofit. Calling her “busy,” however, stings of judgment, prompting her to aver with a cheerfully pithy, yet assertive, “I am not busy. I am full.”
The 41-year-old’s capacity for the work that feeds her soul also fuels her body and mind. Fox controls her capacity and freely admits that her limits change depending on options that align with her life’s purpose, an outlook that provides a foundation for her to say “no” to some requests while also allowing space for more.
It wasn’t always this way.
Fox, like many mothers and working women, worked in the corporate world trying to determine her next career steps when her 16-year-old daughter, Genesis, was diagnosed with Anti-NMDA receptor encephalitis, a type of autoimmune brain infl ammation caused by antibodies. Genesis almost died multiple times. “Th at situation—as tragic as it was— led me to step out and start my own business,” Fox shared.
In a demonstration of determination and perseverance, she also channeled her grief so as not to be overcome by it. Reflecting on the old adage that exhorts making lemonade out of life’s sour lemons, she said, “Well, I made lemonade, lemon meringue, and then a custard!”
In those moments of tragedy and grief, Fox made herself a singular promise: to aim as high as she possibly could, hopeful that she was encouraging her daughter to do the same. “I used all of that tragedy—or God used it—as fuel,” she stated.
Fox’s husband, Brent, her family members, friends, and community members embraced her ambition. She wrote a book, “Back to Me: Authentic reflections, hilarious recollections, and hard truths on the road leading back to me,” published by Bright Communications in the fa ll of 2021.
Fox also founded the nonprofit organization, You Go Girl, initially to support Genesis, who was exoeriencing bullying about her physical appearance and the impact steroids had on her face. The organization’s mission is to encourage, empower, and inspire young women to end the cycle of self-doubt and low self-esteem by creating unique experiences in safe environments for them to learn, grow, love, and accept themselves and others. Fox additionally went back to school and fi nished her bachelors (in multi-disciplinary studies) and masters (in organizational leadership) degrees. She is on track to complete a doctorate in strategic leadership at Oral Roberts University.
Fox drew upon her corporate technology and project management experience and coupled it with her passion for supporting female entrepreneurs to open Catapult Consulting Solutions. The fi rm offers entrepreneurial clients services such as creating stronger branding, websites, and mobile apps, devising sales and marketing strategies, and managing operations on a short- or long-term basis.
Entrepreneur Aissa Aset Bey, the owner of Loc Legacies and pioneer in Omaha’s loc hair community, speaks to Fox’s talent. For over 20 years, Bey has provided hair services to clients of all hair textures, but in 2019, her focus shifted to educating licensed cosmetologists. During the pandemic, Bey was no longer able to provide in-person instruction so she pivoted to training through the Facebook group “Loc Legacies Academy." She navigated establishing an online presence, but needed additional technology, strategy, and support. Her social network recommended partnering with Fox and Catapult Consulting Solutions for search engine optimization, data analytics tracking, and spam management.
Bey’s business re-opened and eventually rebranded with Fox’s help. “Rachel made every effort to fi ll me in on the things I did
not know about the functionality of my website that I built. She really showed a sincere desire to deliver what I was seeking. She and her team handled all of the details of redesigning my website and reconfiguring some important areas,” Bey said.
Th is partnership enabled her to focus on moving her business to its new location in the Old Market. “Rachel has helped me step away from managing my website so I can focus on serving my clients more optimally. Having her on my team has been a huge relief.”
Fox has successfully kicked complacency and comfort to the curb. Each success she creates provides a stronger platform for another. “Emerging from the pandemic to a world of anxiety and depression has an impact on the human psyche. Media, news, and social media make it hard to stay positive and see the good, fi nd encouragement, fi nd the smile. I choose to focus on a message of hope. It is the secret sauce,” Fox said.
Th at hope shapes her approach to remaining true to her ideals and evolving into the new and next versions of herself. Fox shares her journeys as an author, podcaster, and keynote speaker. When Jaymes Sime, President and CEO of Child Saving Institute, needed a motivational keynote address for his employees’ conference, he invited Fox to speak about growth and renewal. She approached the topic using plants as the ideal metaphor for growth.
“It was the perfect message for our staff to hear. [They] picked up on her sincerity and authenticity,” Sime said. “Rachel is just an amazing human and did not disappoint. She went above a nd beyond.”
Fox has also received praise for her work as “chief encourager” at the Omaha Children’s Business Fair. Rachel Benson, founder of the Acton Academy Omaha, described Fox as a bold voice of change with a ca ring heart.
“I have seen Rachel walking from booth to booth, showering encouragement and constructive feedback to the many young entrepreneurs we host for this one-day market,” Benson said. “I have seen her get on their level and call forth their greatness through her encouragement and strong vision. I've even had parents reach out to me, saying, ‘My child was so inspired by Rachel. Her encouragement made their day!'”
and prioritizing oneself. She encourages clients to challenge thoughts of selfishness when considering their personal needs. Fox recently followed her own advice and embraced a 75-day challenge wherein she made a promise to herself to focus on the mind, body, and sou l trifecta.
“It is okay to prioritize yourself over anything else. During this challenge, I had to push past enablement, roadblocks, and self doubt,” she confided.
There were days when she struggled with the challenge, and in the spirit of authenticity, she invited her social media followers into those moments.
“The biggest lesson for me was learning that my body was naturally going to do what it does throughout the days, weeks, months, so I needed to ensure I was paying attention to what I was feeling on the inside,” Fox said.
The fulfi llment of the promise she made to herself was as rewarding as the results. “It was a one-day over one-day approach. The transformation happened over time. It didn’t show up on a scale, but in the defi nition of my arms, my abs, and my gratitude. I’ve had seven natural born children. When I look in the mirror and see the defi nition I have not seen in years, I almost cried,” Fox said. She recalls being glad she didn’t tie the 75-day challenge to a number on the scale, because she might have been disappointed in herself for not hitting a specific number and would have missed out on the joy of celebrating the unexpected good results.
As Fox looks to the future, she plans to attend a retreat in Arizona to be alone in thought and explore her creativity. She feels there may be another book within her. She might even share origin stories of community leaders, founders of movements, businesses, and otherwise unheard voices through her newly-honed skill of video production.
“Well, I made lemonade, lemon meringue, and then a custard!”
—Rachel D. Fox
“I will take the time to rest, reflect, and rejuvenate. Then I will again pour energy into my passion.”
Sharing experiences and storytelling often result in mentorship or coaching. Fox approaches those relationships by focusing on mental wellness rooted in a positive mindset
To learn more about Rachel D. Fox, visit racheldfox.com and catapultnow.net. For information about the nonprofit You Go Girl, visit yougogirlomaha.com.
STORY
| PHOTOGRAPHY BY BILL SITZMANN | DESIGN BY RACHEL BIRDSALL PROFILE //
BY VERONICA WORTMAN PLOETZ
MARCH/APRIL 2024 // 17 //

Emily Kassmeier Soothes Anxiety with Omaha Guidebook
BY CLAUDIA MOOMEY PHOTOGRAPHY BY BILL SITZMANN // DESIGN BY RENEE LUDWICK A/C VIDEO MORE! // 18 // MARCH/APRIL 2024
MAPS No
STORY


"B
efore you go to a new place–maybe it’s a restaurant or a coffee shop, or whatever it is–do you check out the place on Google Maps beforehand to see what the parking situation is like? Maybe you look at their tagged photos to see what the vibe is. Or, maybe you study the menu like it’s your job. If any of this sounds familiar, you are going to want to give us a follow.”
This is how Emily Kassmeier explains the purpose of her social media page, Omaha Guidebook, in a video pinned to the top of her Instagram profile.
Kassmeier is a marketing project manager for an agency, so she gets to work from home, which makes it much easier for her to run Omaha Guidebook in her free time. She originally created her channel as a means for people with anxiety to feel more comfortable when experiencing local places for the first time. It spans across most social media, utilizing TikTok, Instagram, Facebook, and a website of the same name, ensuring easy access for everyone.
Kassmeier began her project in July 2023 when she realized others may also have a need for extra preparedness. “I had a conversation with someone about how we wished something like this existed,” she explained. “I kept thinking about it and wondered how many other people would like something like this so I decided to find out.”
Sure enough, plenty of others liked it, too.
Omaha Guidebook has since gained over 18,000 followers across its social media pages with around 100 reviews of local businesses and even some gift guides for holidays, birthdays, and special occasions.
When deciding where to go and what to review, Kassmeier just goes with the flow. “Some places are requests from followers. I get some requests from business owners or just places I like to go,” she explained. At the end of every video, Kassmeier invites her followers to “drop a comment” requesting new places to be reviewed.
The Guidebook posts at least once a week, sometimes up to five times, featuring places in Omaha and surrounding areas like Elkhorn and Lincoln. Videos cover everything people would need to know before arriving, including directions, parking, physical accessibility, how to navigate the buildings, and how to pay for products.
“I have anxiety, so I definitely understand how it can be a little uncomfortable going somewhere new,” Kassmeier reflected.
“The original intent was that it would be a resource for people who deal with anxiety,” she continued, “but as it has grown, I’ve realized it’s not just people who deal with anxiety who benefit from this; it’s also helpful for people who have ADHD, depression, mobility challenges, et cetera. Then there are people who don’t struggle with any of those issues, who just like to learn about new local places they haven’t been before.”
The Guidebook is not only helpful for customers, but benefits business owners as well. Erin Smith of Mango’s Manis had nothing but glowing compliments for Kassmeier and her channel when she visited Smith’s nail salon in October 2023.
“She is wonderful very sweet, detail-oriented, and very organized. You can tell she really has a passion for this,” Smith said.
She was nervous, she admits, about allowing Kassmeier to create a video regarding her private business, but is beyond pleased with the results. “I was really anxious because I know some social media people can be mean, especially in the beauty industry,” she recalled, “but the way she presented my business was amazing; she captured the environment and everything so beautifully!”
According to Smith, the Omaha Guidebook video “quite literally changed the trajectory of [her] year.” Over the weekend the video dropped, Smith acquired 150 new followers, 20 new clients, and a significant increase in attention to her small business. “I’ve gotten a ton of people who mention it, and it made me feel way more seen and heard in the community. It’s incredible! I highly recommend her to any business.”
Omaha Guidebook continues to rapidly gain followers and engagement on their social media, and Kassmeier remains optimistic about the future of her unique social media project.
“I have gotten quite a few messages from people about how they’ve gone out and explored more after they have watched the videos, which is really encouraging,” she beamed.
Follow Omaha Guidebook on social media platforms, including TikTok, Instagram, and Facebook, or visit omahaguidebook.com.
“I have gotten quite a few messages from people about how they’ve gone out and explored more after they have watched the videos, which is really encouraging.” -Emily Kassmeier
A/C VIDEO MARCH/APRIL // 21 // 2024
In the hands of an Omaha artist, quilts, beds, and chairs weave a narrative beyond their functional existence. They represent a familiar intersection of personal comfort and accommodation for Shelby Seier, a disabled and chronically-ill visual artist and access worker.
Seier sketches beds and chairs adorned with quilts and repurposes old bedsheets into intricate improvisational quilts, which she creates without intentional designs, instead allowing the concept to inform the work. The artist finds inspiration in her own disabilities, particularly neuroimmune axis disorder and dysautonomia, which serve as the primary guiding muses for her creations. They shape and influence every stitch, sketch, and advocacy effort that she undertakes.
"Textiles, especially quilts, are things that protect us and comfort us," Seier explained. Her affinity for chairs and beds essential accommodations in her life due to chronic illness melds seamlessly with her artistic expression. For someone spending substantial time in bed due to disabilities, these objects of rest transcend their utilitarian purpose as Seier transforms them into vibrant expressions of comfort and beauty.
"Fatigue and chronic illness affect my artistic process," Seier admitted. Her artistic timeline is unconventional, a result of navigating the barriers imposed by her own disabilities.
Upon earning a theater degree, Seier committed herself to artistic pursuit until her disabilities hindered her continued engagement. She transitioned into the world of improvisational comedy for a more flexible method of creative expression.
 RENEE LUDWICK
RENEE LUDWICK
 BY BILL SITZMANN
STORY BY NATALIE VELOSO
BY BILL SITZMANN
STORY BY NATALIE VELOSO
// DESIGN
// PHOTOGRAPHY
BY
MARCH/APRIL // 22 // 2024

Shelby Seier’s Journey & Advocacy
Through Textiles, Accommodations,
A/C
VISUAL

Exploring a new artistic avenue, Seier then embraced improvisational quilting in 2021. Inspired by quilts on eBay, she also sketched them to immortalize their beauty. Her intuitive understanding of sewing techniques, passed down from her skilled seamstress grandmother, JoAnn, honed her abilities. This journey spurred her to uncover the roots of the tradition in African American culture, drawing insights from resources like the International Quilt Museum in Lincoln.
“Improvisational quilting is a slight deviation from my heritage, yet it honors my lineages, and I’ve made the practice my own by using my artistic backgrounds to inform my fiber arts practice,” Seier said. “I sew without a plan and let the fabrics speak to me; they tell me where they should go.”
Still, the barriers of chronic pain coupled with chronic fatigue limit the hours the artist can dedicate to her work. “I have yet to make a full-sized quilt,” Seier noted. “Instead, I make quilt blocks and quilt tops, [but] my outputs are decreased due to energetic depletion.
“When I am able to create, I really savor it. Creating a quilt that couldn't be created by a machine means a lot, because it reflects my imperfections and my inability to perform at a certain level.”
Employing ledger paper for her drawings of chairs and beds is also deliberate; she juxtaposes these objects of rest on a medium often associated with productivity and finance, an intentional contrast that signifies her relationship with productivity as a disabled person experiencing time differently.
“When I sit in a chair in public, I experience so much relief,” Seier reflected. “[T]here's a huge gratitude toward these objects…they’ve enhanced my life, and I honor them in that way.”
Seier is well-acquainted with limitations encountered by disabled people, as well as the relief that arises upon entering a space that prioritizes inclusion efforts. That’s why her own endeavors aren’t just about creation; they’re also a means for advocacy. In 2019, Seier founded All Kinds Accessibility Consulting, which practices accessibility as an art form and offers resources and accommodations that go above and beyond what is legally mandated the bare minimum, she emphasized.
"I want to normalize disabled people being in public and having access to the things that non-disabled people take for granted," Seier affirmed. "In my experience, disability is really neutral and at best is just kind of boring; it's just another part of me that is informative and sometimes joyful and wonderful.”
Kelsey Celek, Affiliate Relations Manager for Destination Imagination in Dayton, Ohio, and Seier’s current client, echoed the value of Seier’s work with All Kinds. “[Seier] comes to advocacy work with a wealth of experiences, both professional and personal, which she shares with openness and vulnerability,” Celek shared. “Working with Shelby has been an important milestone in my organization’s progress toward inclusion.
“The warmth and enthusiasm she brings to her advocacy work is infectious; she makes those around her feel empowered to become champions for accessibility, too.”
Seier perceives the art community's adoption of accessibility as essential, urging organizations to consider beyond mere physical accommodations and implement more thoughtful solutions.
“Disabled people have to spend a lot of time researching whether or not a program, opportunity, event, or otherwise will meet their needs,” Seier explained, “and a lot of times, the accessibility begins and ends with information for wheelchair users and that's absolutely vital but the disability experience is so much more than ASL interpreters and wheelchair access.”
Completing a full quilt and securing an artist residency slot both loom on Seier’s artistic horizon. Her advocacy plans call for a world where creativity knows no barriers, where art and accommodation merge effortlessly, and where inclusivity is the cornerstone of every canvas and stage.
“We create [resources] at All Kinds, and we hear great feedback about [disabled people] feeling comfortable leaving their house to go to an event and then feeling excited to be welcomed into the community,” Seier said. “There's a solution for nearly everything and there's no excuse for not including people with disabilities into any program or space.”
For more information, visit allkindsaccessibility.com. Follow Seier’s work on Instagram @shelbyseier and @allkindsaccessibility.
“I sew without a plan and let the fabrics speak to me; they tell me where they should go.”
-Shelby Seier
A/C VISUAL
// 24 // JANUARY/FEBRUARY 2024





VOTED #1 FOR 13 YEARS 3618 N. 165th St. (165 & Maple) americannailsandspaomaha.com 402.779.8700 PEDICURE • MANICURE • SHELLAC DIPPING POWDER ARTIFICIAL NAILS • NAIL ART WAXING • VERSAPRO SUNLESS TANNING 023 F rst Place icure & Pedicure 2024 F rs Place Manicure & Pedicure MARCH/APRIL 2024 // 25 // Digital Advertising Solutions Reach your ideal audience, wherever they are. EMAIL MARKETING SOCIAL MEDIA DISPLAY ADVERTISING business by contacting our digital manager, Luis De La Toba, at 402.884.2000 luis.delatoba@omahapublications.com HELPING FAMILIES PROTECT A LIFETIME OF WORK OUR FIRM HAS ONE MISSION: Our mission is to help families design, share and preserve their family legacy for future generations, through careful legal planning and lifetime relationships. Protect your Family, Protect your Assets, Leave a Legacy Achieve Peace of Mind WE CAN HELP. ESTATE PLANNING | MEDICAID PLANNING | BUSINESS LAW TRUST ADMINISTRATION & PROBATE 2024 F rst Place Employer-Less Than 100Employees 2024 First Place Estate Planning 2024 W nner Law Firm 9859 S. 168th Avenue, Omaha, NE 68136 402.235.5625 | info@ldstrategies.com | www.ldstrategies.com OmahaMagazine.com/Pages/Subscribe
Special Journeys
Omaha Couple Takes t he Disabled on Spectacular Trips
wenty-nine-year-old Autumn Yender was born with the odds stacked against her. Diagnosed with autism, cerebral palsy, and epilepsy, Yender lives in a well-appointed, immaculately kept group home at Village Northwest Unlimited, a private facility for adults with disabilities in Sheldon, Iowa. She could easily spend her days participating in the slew of activities offered on the sprawling, buc olic campus.
She could but this Iowa woman has found a field of dreams outside her c ommunity.
Once a year, Yender embarks on a trip with her devoted mother, Sheila, a nurse who travels as her one-on-one caregiver. The two loving companions, part of a large group of disabled travelers, have enjoyed several shows in Branson, Missouri. They’ve listened to country music at the famous Opryland in Nashville, thrilled at the theme park rides in Dollywood, and clapped to authentic Smoky Mountain music. They’ve marveled at the hot-air balloon races in Louisville, Kentucky, and basked in the sights, sounds, and sun at Disney World, returning home loaded down with as many Magic Kingdom souvenirs as their luggage cou ld contain.
Autumn, who is verbal and ambulatory, has joined hundreds of disabled Midwesterners leading fuller lives through Special Journeys, the Omaha nonprofit changing perceptions about special needs one trip at a time. It’s a vacation experience fueled by the passion of its founder, Lexi Mann. She doesn’t mince words extolling the capabilities of the people she serves and loves.
“Society has a picture of special needs that they’re sitting in a wheelchair, isolated and drooling. We’re constantly trying to overcome that mentality,” emphasized Lexi, looking over at her husband, Tom, an attorney and computer programmer. “People with disabilities are more ‘normal’ than most of ‘normal’ society because they can transform the lives of everyone ar ound them.”
Tom, the organization’s director of operations, picked up on Lexi’s thoughts. “The average client that goes with us is mild-to-moderately developmentally disabled,” he explained. “Many hold community jobs, working in grocery stores or restaurants.”
With every word and gesture, Lexi talks about the disabled with the fervor of an evangelist. In fact, she and Tom met while both worked as youth ministers in their native Chicago. They married in 1999. Less than a year later, the couple moved to Omaha when Tom got a technology position at a large law group. He suggested to Lexi that she earn a college degree. In 2004, she graduated from the University of Nebraska at Omaha with a bachelor’s in broadcast journalism.
But the degree didn’t quench a burning desire to help the disabled, a seed planted years before when she took a summer job working with special needs adults. She also loves to travel. The two passions led Lexi to reassess her priorities after she graduated. She went to Tom and said, “Let’s start a company.”
While Lexi did the legwork, Tom took care of the legal aspects of creating a nonprofit. The inaugural trip of Special Journeys saw a small group travel to the Black Hills and Badlands of South Dakota in 2005. Tom didn’t join Lexi on trips until two years later, when finances allowed him to leave the legal profession.
Special Journeys serves the disabled from Nebraska and four surrounding states Iowa, Missouri, Kansas, and South Dakota. The travelers pay for their own trip, whether by bus, boat , or plane.
And, oh, the places they’ve seen!
Over the last 20 years (except for a two-year hiatus during COVID), the Manns have led groups to all 50 states. They’ve toured such far-flung places as Copenhagen, Denmark, and Saint Petersburg, Russia; groups have taken cruises on the Caribbean, the Baltic, and the Panama Canal; tours have also
sample the cuisine in Cuba, the colorful splendor of Spain, and relived history at the original Olympics venu e in Greece.
Tom and Lexi average two trips a month. They also spend hundreds of hours planning every detail of each trip.
None of this would be possible, however, without volunteer travel companions. Volunteers travel for free, needing money only for snacks and souvenirs. Each companion assists a group of three or four travelers who don’t need a 24-hour caregiver. They talk with them and assist with tasks like choosing items on a menu, souvenirs at a gift shop, or what to wear in the morning. Travel companions have their own hotel rooms and require rather simple qua lifications.
“You don’t have to be a licensed health care worker. Our medical staff has the licenses. You just have to have a heart for others,” Lexi said. Between trips, Lexi managed to earn a master’s degree in Christian Spirituality from Creighton University in 2014.
The travelers have had a profound effect on Sheila Yender, who cared for Autumn, the youngest of five children, until she turned 18. Sheila’s gratitude for Special Journeys has led her to volunteer as a nurse on 23 trips and counting. “I get my purpose back from them,” she said with emotion. “I get my compassion back from them. I get more out of the trips t han I give.”
With the help of selfless volunteers, Tom and Lexi Mann have worked diligently to redefine what constitutes a “normal” life. In the process, they have opened the world to remarkable possi bilities.
For detailed information on upcoming trips, to apply as a volunteer, or to donate, visit specialj ourneys.org.
// 26 // MARCH/APRIL 2024

People with disabilities are more ‘normal’ than most of ‘normal’ society because they can transform the lives of everyone around them.
—Lexi Mann
STORY BY CAROL NIGRELLI PHOTOGRAPHY BY BILL
DESIGN
RACHEL BIRDSALL
ADVENTURE
SITZMANN
BY
Lexi & Tom Mann

PROFILE
Story by Daisy Hutzell-Rodman // Photography by Bill Sitzmann // Design Rachel Birdsall
The heart of Dundee is host to a business called Exist Green, featuring lush greenery and fabulous curb appeal. Inside, however, is a one-of-a-kind business model, at least for the Omaha metro. A glance around the shop reveals Castile soap, reusable straws, and other items often carried in stores to help people reduce their consumption of plastics and packagings that go in the trash bin and consequently the landfill. The difference between many of those stores and Exist Green, however, is that the packaging in this store often comes from the consumers themselves.
Running a retail store is a 90-degree turn from owner Leigh Neary’s first career. She studied groundwater pollution at Colorado State University in Fort Collins, and her research discovered why river restoration isn’t working.
“I proved, essentially, with two other women on my team, that these river restoration projects are pointless, because we don't allow rivers to go through floodplains,” she said, noting that it’s critical to create different areas of rivers for fish lifecycles. “And so they kind of add boulders in these different spots to create eddies and calm areas instead of just straight river flow. But the way we have created berms and levees, these projects go away after 10 years, and it goes back to like the way it was.”
While in Fort Collins, she also worked at the Colorado State University Center for Contaminant Hydrogeology, conducting research with the flammable liquid Methyl tert-butyl ether (MTBE), which has been used as an additive for unleaded gasoline since the 1980s. The research was partly funded by Chevron Corp., which was so impressed by her work they gave her a chance to intern at their headquarters in Northern California.

During that time, in 2006, California passed AB 32, the California Global Warming Solutions Act that required a sharp reduction of greenhouse gas emissions to help transition to a low-carbon future. It was the first comprehensive law to address climate change, requiring a reduction of greenhouse emissions by 15% ov er 15 years.
“This was a pretty amazing learning experience, because I was working at the refinery,” Neary said. “I was able to look at every single fuel input at all of the different potential spots for emissions and then quantify how much fuel they're burning in these different spots. That’s not even talking about what their final product emits, which is even larger, but this is just what's happening at the refinery. I was able to learn even more about how our refi nery works.”
100% Committed toMother Earth
Omaha Store Strives for Zero Waste
She thought she would be at Chevron for a five-month internship, then return to Colorado for a master’s degree, but she remained at the company for an additional 14 months, simultaneously studying at University of Californi a Berkeley.
Her work as an environmental engineer taught her that what she wanted was to create change for, rather than working on Band-Aid solutions to, major environmental problems. On a plane ride, she dreamt of an online, Earth-friendly business. That business became a reality in 2019, when she opened Exist Green, a nearly-zero-waste market and eco-friendl y boutique.
Much of the 5,000-square-foot store is devoted to large containers those holding bulk items such as grains, herbs and spices, teas, and cleaning or beauty items from which patrons can specify their desired quantity. Shoppers then place products into their own receptacles, which are weighed before goods are added to ensure the correct cost. Those who forget their own containers can acquire ones in store.
Samantha Nieman of Elkhorn is a sustainability consultant with Hillside Solutions and an Exist Green customer. She keeps crates inside her bathroom and kitchen, and when she is running low on a product, such as hairspray, she puts her container in the crate. That way, when she goes to Exist Green, she has all her containers together. Nieman and other customers drop off their containers to be washed and filled as they browse, or in Nieman’s case, run errands, and then return to pick up their items.
“My favorite products would be the hairspray, the laundry detergent, and the dishwashing (soap) block,” Nieman said. “The hairspray is my top product because I can go to the store, refill the hairspray, take it home, and it works really well with my hair chemistry.”
While no store can ensure 100% zero waste, Neary’s is as close as possible. Boxes of trash bags are compostable (both the box and the bags), mascara wands are bamboo and reusable, and the mascara tubes themselves are metal and refillable. All packaging that comes into the store, such as shipping
boxes, are recycled or composted. Neary’s concern for the environment extends to the brands she carries in the store. Razor brand Albatross, for example, is committed to a take-back program for their blades, leaving only a paper box to be recycled.
While carting jars to a store isn’t normal for most people, those who patronize Exist Green have discovered their reduction in carbon footprint makes it worthwhile.
“It's new. It's different. It is an extra step than just, you know, doing a Target run and being done,” Nieman said. “But what I would like to tell people is just go into the store, bring some jars, and try some products out.”
Visit existgreen.com for more information. Follow social media @ExistGreen1 on Facebook; @Exist_Green on X; and exist_ green o n Instagram.
MARCH/APRIL 2024 // 29 //
THE FUTURE
 STORY BY SARA LOCKE
BILL SITZMANN
STORY BY SARA LOCKE
BILL SITZMANN
WINTON F
GEN O
PHOTOGRAPHY BY
DESIGN BY JOEY
MEDICINE

UNMC’S HIGH SCHOOL ALLIANCE STUDENTS ARE SHAPING HEALTHCARE NOW
MARCH/APRIL 2024 // 31 //
hile many of her peers are just getting around to touring colleges and choosing a major, Millard South Senior Julia Matos has been on the path to her future career for over a year. Among the standard classes, volunteer work with Children’s Hospital, and time spent with HOSA (Health Occupations Students of America), she spends her afternoons in the research lab of Kishore Challagundla, PhD, at University of Nebraska Medical Center.
“I have always been interested in science, so when my counselor told me about this program, I decided I had to go for it,” Matos said of the hands-on lab time she spends at UNMC. “I know this isn’t something that many high school students get the opportunity to experience, so I’m really grateful for this exposure.”
The program in question is UNMC’s High School Alliance initiative, an exclusive and hard-earned opportunity for juniors and seniors to learn directly from UNMC’s doctors, physical therapists, and researchers. Students from over 25 local schools participate in this accredited program. These future healthcare professionals spend their time shadowing, observing, and assisting in real-life, cutting edge medical scenarios.
“Entering into this program, I was sure I wanted to work in the medical field in the future,” Matos continued. “But now I’m defi nitely more invested in research. I’ve spent time here developing those skills, working with cells, learning to understand viruses. I want to spend more time researching diabetes and Zika virus. Right now, they’re incurable. But I’m getting to see the studies that are happening around them, and the advances that are being made in medicine.”
Matos speaks of her time in the lab like any passionate musician speaks of time with their instrument—with a reverence and passion singular to the artistic mind. While the gravity of the work at hand isn’t lost on her, neither is the humility and curiosity needed to approach a field as vast and complex as vira l research.
These sentiments are mirrored by fellow High School Alliance student Mischa Mikityuk, a senior at Central High School.
“I found out about this program when I was still in middle school. Since then, I started taking specific classes to become more competitive so I could earn a spot,” Mikityuk said. “I was able to join last year, and it was such a great experience, I decided to reapply for senior year. The fi rst year we were in a lot of classes, but this year we’re right there in a doctor’s research lab and learning so much every day.”
Like Matos, Mikityuk doesn’t see medicine as a hypothetical future option, but has been building her experience both by joining the HSA program and in her work as a certified nursing assistant.
“In my job now, I am learning a lot about patient care, which I love. But in the lab, I get to see the science that goes into the treatment protocols and the behind-the-scenes of medicine. I always believed I would practice medicine as a surgeon, but with everything I’m learning now and all that I will learn in medical school, there are so many fields to learn about and choose from. I know that my focus could change as I continue t he process.”
The High School Alliance has been operating for 14 years, and instructor Anup Pathania, PhD, has been proud to be part of the program for the last seven.
“When I was growing up, high school students only had access to the most basic science classes,” said Pathania. “Here, we have one student looking at the friction coefficient of different materials for replacement joints, one student working in the pharmacy studying proteins, and one doing a mid-study analysis on the use of wound vacs after major leg surgery. Th is isn’t what I had access to as a teenager, and this program is very supportive of the passion these students have for this work.”
Other students in the program are working in the brain lab, researching the effects of Parkinson’s disease on patients’ ability to drive, studying the efficacy of new HIV treatments, and exploring vir us proteins.
“We have a student working on developing a database of chemical molecules. Right now, there are three separate databases the students need to look at, and having them all accessible in one space could be very beneficial,” Pat hania said.
Under Pathania, Matos and Mikityuk are both researching alternative therapies for relapse of highrisk neuroblastoma, one of the most devastating pediatric cancers. These students are working, learning, and practicing techniques and experiments that will very likely change the future of medicine.
“We are always supervised, but the attention to detail in this research is critical,” Matos said. “Even a minor mistake can seriously alter the results of an experiment. We are learning to pay close attention and to document each step so that if a mistake does happen, we can track where and when and what the result was. Th is research really lets me explore my creativity and problem solving [skills], and I’m so grateful this progra m exists.”
To learn more about UNMC’s High School Alliance program, visit unmc.edu/alliance.
// 32 // MARCH/APRIL 2024
GEN O
 Mischa Mikityuk
Dr. Anup Pathania
Julia Matos
by Claudia Moomey | Design by Rachel Birdsall
Mischa Mikityuk
Dr. Anup Pathania
Julia Matos
by Claudia Moomey | Design by Rachel Birdsall

Walter Reed’s Fateful Years in Nebraska
“The prayer that has been mine for 20 or more years, that I might be permitted in some way or sometime to do something to alleviate human suffering, has been answered!”
—Dr. Walter Reed
History
Story
“We doubt if Fort Robinson will ever contain a physician as affable and accommodating as the outgoing doctor has been, not only to the soldiers but settlers as well.”

Inscribed on his burial marker at Arlington National Cemetery, this statement summarizes the great medical influence of Dr. Walter Reed.
Typhoid fever, erysipelas, cholera–these were all challenges that Reed encountered during his time as post surgeon at Fort Sidney, Fort Robinson, and Fort Omaha, Nebraska. Dr. Reed, ranked Captain at the time, treated many cases of infectious diseases and presided over several births.
Tending mainly to other soldiers stationed at the forts and their families, Reed was able to save and improve the lives of countless people while using his influence to create more sanitary conditions for aili ng soldiers.
Reed, who had graduated with an M.D. from the University of Virginia at the age of 17, was soon enlisted in the military; stationed at Fort Omaha, his wife Emily gave birth to a daughter, who shared her mother’s name.
From Fort Omaha, Reed was ordered in October of 1883 to Fort Sidney, Nebraska, where his temporary responsibility was to reside over the military hospital. “Upon taking charge of medical affairs at Fort Sidney,” Reed wrote, “I find the ward rather full of ‘ugly’ cases.” These cases fostered the spread of diseases among soldiers in the barracks. The living and treatment spaces were so unclean and dangerous that Reed
suggested to his superiors that the military post be shut down. While not on duty as a surgeon, he wrote by candlelight his medical reports, which included his suggestions for better conditions and improved equipment to make for safer medica l practices. His treatment of several infections and illnesses at this fort, primarily erysipelas, a skin infection that can spread to the lymphatic system, inspired his first medical article, “The Contagiousness of Erysipelas,” publis hed in 1892.
MARCH/APRIL 2024 // 35 //




Having spent only about nine months at Fort Sidney, Reed was then transferred to Fort Robinson in July 1884. Among the patients at this third Nebraska location was Swiss immigrant Jules Sandoz, who had broken his ankle while digging a well. Reed was prepared to amputate Sandoz’s foot, because he believed that removing the limb was the only solution. The patient, however, refused to consent. Sandoz reportedly threatened to kill Reed if the doctor amputated. Reed, an honorable physician who respected his patients’ wishes, proceeded with an alternate, albeit extensive course of treatment, and ultim ately saved the man’s foot.
A local newspaper in the area praised Dr. Reed’s achievements as he left the fort: “We doubt if Fort Robinson will ever contain a physician as affable and accommodating as the outgoing doctor has been, not only to the soldiers but settle rs as well.”
The myriad cases Reed treated during his years in Nebraska sparked his interest in the relatively new field of bacteriology, which he continued to study. In 1890, Reed requested a leave of absence, which was granted, along with special permission to study at Johns Hopkins University.
After his time in the Midwest, Reed went on to do prominent research in Havana, Cuba, particularly dealing with the epidemic of yellow fever. At the time, medical professionals widely believed that the disease was spread by fomites, or infected materials such as bedding or cutlery. Reed, however, saw that each of his patients had a common hobby: walking through the










to your employees, clients and customers with a subscription to Omaha Magazine! Say Thank You AMPING UP the standard base camp: omaha subscriptions@omahamagazine.com Fa of Omaha 2023 A subscription to Omaha Magazine includes Omaha Home Magazine. We offer bulk subscriptions of our local magazine to businesses to help them express their appreciation. Benefits: • Significant savings over individual subscriptions. •Increase client referral and advocacy • Customer retention program • Show appreciation year round (8 times a year) • Your business name and message will be on the top line of every mailing label. (Up to 36 characters) ★ BONUS Each subscription includes FACES of Omaha and Best of Omaha Results issues // 36 // MARCH/APRIL 2024 Get a Jump on Your Summer Body Now! Visit topformtelehealth.com for more information. 402-855-5480 105 N Washington St. Papillion NE 68046
Look your best in spring fashions you’re going to love! 2024 Winner Women s Boutique 402.991.4477 84th & 1st St. / Downtown Papillion Open Tues - Fri 10 - 6PM Sat 10 - 5PM, Sun - Mon CLOSED MARCH 15TH 10-6PM & 16TH 10-5PM Spring Fling
Through a series of experiments, Reed and his colleagues proved that mosquito bites were to blame for spreading yellow fever. This became Reed’s crowning scientific achievement, earning him various awards and leading to one of the most prominent hospitals in the country taking his name: the Walter Reed General Hospital, later renamed the Walter Reed National Military Medical Center, in Bethesd a, Maryland.
Reed’s influence on the medical world is still celebrated today. In March 2020, the Marie Sandoz High Plains Heritage Center in Chadron, Nebraska, presented an exhibition entitled “Hindsight 20/20,” which documented Reed’s time at Fort Robinson. This exhibition told his story alongside a display of a collection of pharmaceutical items from the time period.
Although a disease like yellow fever may be thought of as ancient in comparison to current medical knowledge, it presented a serious risk to those infected before Walter Reed was able to pinpoint its cause. For this unprecedented discovery, he is one of the most prolific medical professionals in American history, inspiring doctors and scientists everywhere to think outside the box.
For Reed, however, fame was not important. As he wrote to his wife, “The prayer that has been mine for 20 or more years, that I might be permitted in some way or sometime to do something to alleviate human suffering, has been answered!”






MARCH/APRIL 2024 // 37 // So Much More Than 20/20 Vision! and Fashion Eyewear Shop Voted Best of Omaha 14 Consecutive Years! 2024 First Place Optometrist Marsha Kubica, O.D., Kristen Johnson, O.D., Corey Langford, O.D., Lexye Bruegman, O.D. Schedule your appointment online at omahaeyecare.com or call us at 402.330.3000 1011 S. 180th St., Elkhorn, NE 68022
402.397.8050 • 2thdoc.org • 15751 West Dodge Road Marty J. Matz, D.D.S. 12 years in a row! Dental Implants • Cosmetic Dentistry • Sedation • Family Dentistry • Wisdom Teeth Removal Call to join our Membership Club and start saving today! No Insurance? Our patients don’t need it! 2024 Winner Cosmetic Dentist


“There’re going to be days when you’re going to be in pain. We’ve earned days where we can feel a little sorry for ourselves. But it’s very important not to stay down. You’ve got to pick yourself back up and move forward. "
—Teri Roberts
expanded content, open the
on your smart
and
over the QR
For
camera
device
hover
code above.

DARKNESS
Teri Roberts Overcomes to Encourage
hen Teri Roberts makes volunteer rounds at the Methodist Acute Rehabilitation Center, she can identify with patients more than most visitors. That’s because she was a patient there herself after a life-changing event in late 2014 that began as a suspected case of flu but turned out to be group A Streptococcus, a bacterial infection that can cause skin, soft tissue, and respiratory tract infections.
Roberts’ situation worsened when she developed sepsis and toxic shock syndrome. Her kidneys and liver shut down, and she fell into a coma that las ted 12 days.
Mere hours before life support was scheduled to be removed, Roberts regained consciousness. Mixed with the joy of survival was the devastating knowledge that her hands and feet had turned gangrenous due to lack of oxygen. All four needed to be amputated. Through the amputations, her recovery, and physical and occupational therapy, Roberts’ positive attitude was her se cret weapon.
She needed it, too. Only 16 months before developing group A Streptococcus and losing her limbs, Roberts' only daughter, Andrea Kruger, a mother of three, was brutally murdered in Omaha by serial killer Ni kko Jenkins.
For Roberts, who believes in silver linings, that tragedy was almost too much to bear.
“I’ve never been a negative person. We were pretty much knocked to our knees in 2013 when we lost our daughter,” she shared. “There were times I didn’t think I was going to get back up off the floor after we lost Andrea. I relied heavily on my faith. I prayed a lot for strength. I guess maybe He’s still there giving me the strength that I nee d to go on.”
When her daughter was taken from her, Roberts leaned into caring for her gr andchildren.
“If I didn’t have them to take care of up until I got sick, it would have been very difficult, I think, to come out of that dark space in my life ,” she said.
That experience, combined with her naturally upbeat, can-do personality, helped her choose life a second time when she emerged fr om her coma.
FEATURE // STORY BY LEO ADAM BIGA | PHOTOGRAPHY BY BILL SITZMANN | DESIGN BY RACHEL BIRDSALL MARCH/APRIL 2024 // 39 //
“I got knocked to my knees once before and got up,” Roberts said. “Through the grace of God, I’ve come forward this much and will just keep going on the ride.”
Embracing life without limbs was a very consc ious choice.
“Number one, what’s important is you have to accept the new you, whatever it is. And then you have to decide to move on. I mean, you’ve got two decisions,” Roberts reflected. “You decide to move on mainly for yourself but also for all those around you. Or, you decide to just stay there and make everyone around you miserable. But more importantly, in my view, you’re making yourself miserable. To me, that’s not living.”
Impatient and ever ready to just get on with things, she said, “I never thought of not moving forward. I just kept saying, ‘Okay, what do we have to do? I’m going to have my hands amputated, wh at’s next?’”
Never one to shirk a challenge or avoid learning new skills, Roberts leaned into learning how to use prosthetic legs. She opts not to use prosthetic arms. Her overriding goal then was clear: to return home and have a func tional life.
Occupational therapist Katrina Balak recalled that Roberts was “motivated from the start,” adding, “There weren’t a lot of ‘woe-is-me’ moments not that she didn’t get frustrated, but she never gave up. With each new issue that needed to be surmounted, Teri was like, ‘How can I get better? How can I make it work?’ She just had a lot of pe rseverance.”
Self-pity was not an option in Roberts’ mind. “I never remember asking anyone, ‘Why did it happen to me?’ I never sat and felt sorry for myself ever. I’m a firm believer that everything happens for a reason. I’ll learn that reas on one day.”
If there’s anyone she’s leaned on, it’s her husband of four decades, Kent. The pair’s shared sense of humor has helped them get through back-to-back challenges that would have been the end of s ome couples.
“We’ve had a lot of heartache and tragedy in our lives,” Kent said, “but we don’t sit around and wring our hands and moan and groan about it. All in all, we just move forward and try t o have fun.”
When she awoke from the coma, Roberts shared, “I told Kent, ’You can’t get rid of me that easy.’ Humor is, in my opinion, fantastic medicine. I think you need to find a way to laugh every day.”
About being a quadruple amputee, she once quipped, “I’m just letting the other people finally catc h up to me.”
Roberts recalled one day in the hospital telling Kent that she was scared. “He said, ‘What do you mean you’re scared?’
“I said, ‘Well, you hear these stories of people seeing a white light when they’re that close to death, but, Kent, I didn’t see a white light.’ And he leaned over and said, ‘Honey, did you see flames?’ ‘No.’ ‘Well, there you have it.’ And that was the end of it.”
Roberts said she still marvels, “He never
“After sitting around for a year, I said to myself, ‘There’s a reason I’m here, and I need to figure it out.' And that’s when I thought, ‘I want to give back.’”
—Teri Roberts
complained. He was always there for me. I have an awesome support system between my family and my friends.”
Kent said it’s easy to be there for someone who i nspires him.
“She has the most positive mindset of anyone I’ve ever met,” he averred. “She doesn’t seem to get upset about her disabilities. There’re certain things she simply cannot do such as cooking, which is fine, because I love to cook. But most things she can do.
“It doesn’t slow her down, she just keeps going. She finds a way to work around differ ent things.”
Besides the comfort of family and friends, Roberts is active in online support groups. “There’s a community, and I love it,” she said. “I learn a lot of stuff just from reading posts that other amputees make.”
Beating the odds as she did, however, prompted a question that nagged her.
“Most people with the condition I had do not make it. I shouldn’t have made it,” Roberts reflected. “So I kept thinking, ‘Why? Why did I make it?’ I sat for the first year after I got home. I couldn’t take care of the grandkids anymore. I was very limited on what I could do.”
Before her health crisis, she had worked in the insurance field and served two terms on a local school board. Without a job to go back to, Roberts, who had always been very active, sou ght answers.
“After sitting around for a year, I said to myself, ‘There’s a reason I’m here, and I need to figure it out.' And that’s when I thought, ‘I want to give back.’”
What better place to give back than at the Methodist Acute Rehabilitation Center, the center that helped her transition to her new life?
“I asked, ‘Do you ever have volunteers come out and talk to your patients?’” Roberts recounted. “After making that initial call, I think I was up at Methodist Hospital within a week. I was thrilled. I didn’t know it was possible to do the volunteering I wa nted to do.”
Her goal is to be a positive light in a pa tient’s day.
“Driving in on Wednesdays when I normally do my volunteering, I will shut the radio off in the car and pray that maybe I can bring some encouragement,” Roberts shared. “I pop in on patients when they have down time to say, ‘Hi,’ tell my story, ask what brought them there, and hopefully, bring some encouragement and friendship. That’s the main thing.”
That encouragement extends to staff having a bad day. “She just puts a bright light on the day and gives us more motivation to do the work we do,” Balak said.
Roberts wishes that every patient had the family support she does, but she acknowledges some si mply don’t.
“After doing this volunteer work for four years, I realize not everyone is as lucky as I am as far as having a support system,” she said. “Unfortunately, several folks I’ve met are alone in life. They don’t have anyone. It’s those people my heart goes out to. I wish I cou ld do more.”
Roberts wants patients to know, though, that they are in good hands. “I tell them that they’re in the greatest spot they can be. You can tell the therapists at Methodist genuinely love their jobs. They want to help these people. The therapists there are awesome and extrem ely caring.
“They’re the very first step. Whether it’s a stroke patient or a heart patient or a diabetic or an amputee, the therapists are the first people there to encourage someone who’s gone through something very traumatic. They’re there to encourage them that
// 40 // MARCH/APRIL 2024
there still is a lot of good ahead of you and ‘Let’s work together to get you there.’”
With the help of therapists, Roberts said that she has learned that “you have to move forward and work. It means pushing yourself and finding adaptive new ways to do things. Every day, you’re figuring out how to accomplish some thing else.”
With practice, she now drives, does laundry, mows the lawn, works in the garde n, and more.
“Whatever my limitations are, those are my limitations. I just needed to learn to deal with them,” Roberts reflected. “Life is still good. I certainly believe that. Every day I be lieve that.”
She carries that same message to patients, but she also “doesn’t sugarcoat things. She tells them that it takes a lot of hard work and grit,” Balak said.
“There’re going to be days when you’re going to be in pain,” Roberts said. “We’ve earned days where we can feel a little sorry for ourselves. But it’s very important not to stay down. You’ve got to pick yourself back up and move forward. You can do whatever you set your mind to. You may be doing it differently, and it may take you longer than in the past, but you can s till do it.”
Balak said she and her colleagues treasure Roberts’ work wit h patients.
“She’s an amazing story and an amazing person to work with our patients. It’s one thing from a patient’s perspective to hear from us that they’ll get better, but it’s a whole other perspective to hear it from someone who’s actually gone through these experiences.
“We’re very impressed that she can make a connection with patients so quickly. Hopefully, she can be a picture for them that they do have something to look forward to.”
Roberts also does peer counseling at Madonna Rehabilitation Hospital and at QLI, where she continued her recovery and rehabilitation after leaving Methodi st Hospital.
About engaging with patients, she said, “I get more out of this, I believe, than what I ever give back. It’s therapy for me. It just makes my heart full. Being able to talk to people, listen to their stories I love it.”
Kent said what started as just something to do has evolved into the highlight of his wife’s week. “She pretty much wears her heart on her sleeve. What you see is what you get. She’s just a very caring person and has a real loving heart. I think she was cut out for this. It’s right up her alley.”
When Roberts missed several volunteer stints to care for her dying father, she found herself gettin g depressed.
“Boy, did I need it,” she remembered. “But since returning, it’s helped my attitude. Methodist save d me again.”
Roberts has delivered her message of hope and resiliency as a public speaker, but she prefers more intimate exchanges with patients and students. For example, she speaks regularly to Nebraska Methodist College occupational ther apy classes.
In many respects, Roberts’ approach to her life remains unchanged from when she was fully able-bodied.
“I’m constantly out in public. When I’m out doing my stuff, running my errands, whatever it may be, I guess I don’t even think that people are looking at me differently,” she reflected. “It’s not until I go to pay for something, and the clerk asks if I need help, and I go, ‘No, no, no! I’ve got this!’ I tell them, ‘Believe me, I learned how to eat and spend money right away after my amputations.’”
Those occasions also present teaching opportunities.
“Little kids will look at me. Their parents say, ‘Don’t stare at her.’ And I go, ‘No, that’s fine. They’re just curious,’” Roberts shared. “When I’m asked, ‘What happened to you?’ by a child, I try very hard not to use the words ‘I got sick,’ because I don’t want those kids to think they’re going to lose their hands and feet if the y get sick.”
She reminds people that no one should be defined by their disabilities. Spreading positivity seems to be one of her gifts. That, along with taking charge of her life and moving on, is just the way she’s wired.
Always looking to maximize her time to help others, Roberts said, “I guess I’m still continuing to search. Is this why I’m still here? Do I need to find mor e to do?’”
To see more of Roberts’ story, view her Methodist video at bestcare.org/volunteerimpact. For more information on Methodist’s rehabilitation program, visit bestcare.org/ specialties/acute-reh abilitation.
“I got knocked to my knees once before and got up. Through the grace of God, I’ve come forward this much and will just keep going on the ride.”
—Teri Roberts
MARCH/APRIL 2024 // 41 //


content, open the camera on your smart device and hover over the QR
For expanded
code above.

harmaceutical drug commercials, they’re everywhere these days… Action!
Fade in. A dark cloud curdles over a suburban home. Sunken, briefly startled eyes retreat back into a thousand-yard stare. A bleating alarm clock melts into the sobs of a child out of frame. Drifting through motes of greyscale dust, a hand reaches languidly for the bedside curtains— then pauses.
“Does every day…feel more exhausting than the last? Is making special memories…just another chore? Is the view outside…always cloudy?” a clear, yet tender, voice probes. “Then you may be experiencing symptoms of depression…”
Overhead shot. An umbrella bursts open, revealing a yellow frowning face; garlands of rainwater spill over its cheeks and over the edge. Grocery bag in hand, the figure beneath pauses.
Cue music. Snare drums. Brass. Double time.
“Lexachant can help.”
The curtains snap shut…and the front door opens to a pair of mischievous grins. Four yellow rain-boots kick up puddles as as the umbrella lowers.
“Call your doctor if you experience…” Cue list of side effects.
The family of three collides in a sopping, laughing embrace. Clouds break as the umbrella rolls into frame, a yellow smiley face sparkling a sun-slick canopy. Pan up. “Lexachant: Seize the Smile, Rain or Shine.” Fade out. And… Cut!
Depression, of course, is no laughing matter—in 2023, the number of Americans suffering from the condition reached a record-breaking 60 million individuals, or just under 18% of the population. The country, and indeed the world, has been described as enduring an “epidemic” of mental health crises, the human toll not only immediately devastating, but incalculable in the longterm.
Still, it’s worth examining pharmaceutical ads’ ubiquity and the predictable, practically memetic, cadence they’ve produced in the popular imagination. The stilted quality of their “candid” lifestyle scenes; the derivative, if occasionally surreal, themes and symbolism; the calm, assuring voiceover turned auctioneer at the fi rst syllable of adverse reactions.
There’s something uncanny about these commercials, partly because this type of generic, suggestive advertising implies, but does not outright promise, desirable outcomes. In fact, the legality of direct-to-consumer pharmaceutical advertising is more stringent than alcohol internationally. Only two countries, the United States and New Zealand, refrain from banning their syndication outright.
Of all the things left unsaid, however, perhaps the most jarring is how these drugs actually work. In the specific case of antidepressants, nobody, not even the world’s leading neurologists and psychoanalysts, can explain with certainty how they function—nor conclusively, to what extent.
The pharmacological thesis underlying their efficacy—the monoamine hypothesis, or in layman’s terms, mental illness as a consequence of chemical imbalance—was initially described following the synthesis of drugs intended to treat tuberculosis, their incidental “antidepressant” effects prompting a lasting rebrand. Th is premise was later refi ned and heavily marketed to the Federal Drug Administration (FDA) to push the fi rst “blockbuster” antidepressant, Fluoxetine (Prozac), in 1988, before the medical community roundly rejected it around the turn of the millennium.
Despite this, an estimated 1 in every 8 Americans take antidepressants today, the loftiest new peak in a trend of prescriptions surging by 65% between 1999 and 2014. As of 2022, the antidepressant industry commands a $15.6-billion global market share, with North America leading a forecasted $23.22 billion by 2030. Needless to say, the ad campaigns have proven successful.
MARCH/APRIL 2024 // 43 //
MARCH/APRIL 2024
In 2022, the journal Molecular Psychiatry published a rigorous ‘umbrella review’ encompassing decades of relevant literature, which stirred something of a media frenzy when it declared what most academics had long surmised: the specific link between depression and serotonin volume is wholly unsubstantiated. The authors, apparently anticipating this response, added, “80% or more of the general public now believe it is established that depression is caused by a ‘chemical imbalance.’ Many general practitioners also subscribe to this view and popular websites commonly cite t he theory.”
They even went a somewhat controversial step further in their conclusion:
“…this belief shapes how people understand their moods, leading to a pessimistic outlook on the outcome of depression and negative expectancies about the possibility of self-regulation of mood. The idea that depression is the result of chemical imbalance also influences decisions about whether to take or continue antidepressant medication and may discourage people from discontinuing treatment, potentially leading to lifelong dependence on these drugs. […]
We suggest it is time to acknowledge that the serotonin theory of depression is not empirically supported.” (Moncrieff et al., University Col lege London)
Yet antidepressants, selective serotonin re-uptake inhibitors (SSRIs) the most readily prescribed, do appear to alleviate depressive symptoms in a small but not insignificant number of patients. According to yet another 2022 meta-analysis—which tabulated more than 232 randomized, double-blind, placebo-controlled trials submitted to the FDA between 1979 and 2016— approximately 15% of the 73,388 participants involved showed a significant therapeutic response to the ingredients beyond a placebo effect. Nonetheless, the authors cautioned that “the potential for substantial benefit must be weighed against the risks associated with the use of antidepressants, as well as consideration of the risks associated with other treatments that have shown benefits.” (Stone et al., FDA Division of Psychiatry and Johns Hopkins University).
Researchers have been quietly seeking a replicable explanation for years. A few positions have gained traction, but none the empirical heft required to tip the scales of consensus.
Outside the unexpected strength and indirect positive outcomes of placebos, those more critical of antidepressants’ mechanisms point to a general “numbing effect,” loosely supported by anecdotal patient reports and
observed suppression of the amygdala, the two almond-shaped clusters of nuclei located deep in cerebellum. Th is part of the brain processes memory, decision making, and emotional responses such as fear and anxiety. Conversely, a handful of limited but compelling studies suggest the synaptic interplay induces a multimodal “downstream effect” that may also account for the two-to-three-week delay typical of relief: the enhancement of neuroplasticity, or adaptive structural changes to the brain. In other words, the revival of dormant neural connections i n the brain.
thus far only, federally-sanctioned investigation of the substance in Nebraska.
While psilocybin and other recently approved “breakthrough” psychedelics have never starred in focus-group tested, multi-million dollar television commercials, they’ve become the subject of renewed interest—and optimism—as promising data trickles in. Besides, screen time isn’t recommended.
“If you have your eyes open, your brain is processing stimuli and trying to interpret it. When you close your eyes, all you have is what’s inside your head, and that’s where the therapeutic impact usually is,” Luka s advised.
Apertures
As the Chief of Palliative Medicine at the Nebraska Veteran’s Health Association, Dr. Lukas is well acquainted with the psychological pitfalls encountered by those approaching their mortality. As a study participant and eventual colleague of pioneering psilocybin researcher Dr. Roland Griffiths—whose landmark 2006 study all but jumpstarted the field—she’s equally familiar with the profound, potentially life-changing outcomes psychedelic-assisted therapy can support. It is the marriage of these experiences that colors her lessons from behind the lectern as an associate professor at the University of Nebraska Medical Center, and the portmanteau at the heart of her studies: Heartland Palliadelic Rese arch Center.
Dr. Lou Lukas, an Omaha-based physician, professor, and clinical researcher, believes the latter theory holds merit. Although for her, a different drug has stolen the limelight.
In 1971, the compound in question was deemed a Schedule I-tier substance, which, according to the 1970’s Controlled Substance Act, possesses “no currently accepted medical use and a high potential for abuse,” and was therefore excluded from grant funding and laboratory testing alongside drugs such as heroin and quaaludes. After decades of sporadic evidence to the contrary, the red tape is fi nally beginning to peel.
Psilocybin, a naturally-occurring compound found in over 100 species of fungi (“magic mushrooms”), received “breakthrough therapy status” for treatment-resistant depression in 2018 and for major depressive disorder in 2019. At this time, Lukas and her team’s exploratory pilot trial represents the fi rst, and
“We’re 11-and-a-half years out and I can still describe minute by minute parts of the experience...I can feel that sense of awareness that you have of yourself […] a sense of identity that you just take for granted until you have this experience where you actually get a kind of ‘behind the scenes’ look at what’s going on,” Lukas recalled of the 2011 Johns Hopkins clinical trial that introduced her to psilocybin. “What I found, even though it wasn’t an explicit part of my psychedelic experience, I was practicing palliative medicine at the time, I just felt this sense that all is well. Th at this fear we have around dying, it’s okay […] and if we approached it with just a little bit more courage and a little more curiosity, it wouldn’t be as all-consuming and terrifying.”
Depressive and anxious episodes are understandably common responses to terminal illness diagnoses, the unpredictable temperature of stress responses and decision-making at times blistering with panic, other times glacial with detachment. While opiates and anti-infl ammatory adjuvants are common
SECTION // NAMES // 44 // MARCH/APRIL 2024
prescriptions for physical pain, antidepressants are the go-to for psychological distress. Lukas’ pilot trial, which began enrolling participants last spring, aims to gauge the efficacy, pharmacology, and overall utility of psilocybin-assisted therapy for those facing a particularly lethal form of illness: pancreatic cancer. While recording neuronal activity and collecting experiential reports, she hopes the sessions do more than simply dull the pain experienced by patients and their families, but promote serenit y, even joy.
“[Psilocybin’s active metabolite, psilocin] is the key that gets you in the door, and then these downstream effects unfold long after the drug is out of your system,” Lukas explained. “The neuroplasticity that happens, we think, persists for about a month after the altered state of reality, which is over in about six hours […] It’s creating an imbalanced state in the system that is temporary, but that imbalance causes changes in the way your brain is able to adapt to fut ure things.”
and you move from a nice maple tree to a Joshua tree or a cactus and there aren’t many options […] and you can be stuck in maladaptive patterns. But under psilocybin, you can return to that jungle for a little while.”
As reflected in a growing body of research, the subjective aspect, or the “trip,” may be just as crucial to therapeutic outcomes as the biomechanics. Following three 90-minute introductory sessions, a standardized 25 milligrams of synthetic psilocybin—a “sweet spot” dose, as Lukas put it—is administered under vigil of two facilitators.
The patient wears a soft, gre y blindfold.
“The interior world is more vast than you can imagine. I just had a study participant say in our trial, ‘I feel like I’ve lived my whole life in a utility closet. I didn’t realize I could just open the door and step out into an amphitheater. And not only is it an amphitheater, but you can sit in any seat and you can have any view you want,’” Lukas recalled with a grin.
“Th is whole idea that there’s a personality disorder, and there’s depression, and there’s anxiety, and there’s trauma…it’s quite useful to be able to categorize them in some way. It’s helpful to know a little bit of the differences, but underneath most of them, there’s probably a similar underlying neurological-psychological structure, and this gets to what we call a cross-diagnostic or trans-diagnostic approach,” she said. “It has different fl avors, and it manifests in slightly different ways, but it’s the consequence of this reality model not functioning properly and not being adequately adaptive.”
Psychedelics, under professional care and sustained by cognitive therapy, have shown to recalibrate one’s “reality model” with few side effects, low toxicity, and virtually zero risk of physical dependence—by no means panaceas, but less risky for those who believe in such things. While “magical” might be a stretch, it’s hard to deny their transcendental qualities. For some, they can open fresh eyes of gratitude in the face death.
“This mode of treatment (psychedelics) is not numbing. It’s facing and truly processing and integrating your trauma and how you got to where you are. And that’s real growth.” –Jordan Martin
Lukas noted that “imbalanced cells” are among the most signifi cant diff erences between psilocin and serotonin’s interactions with key neural receptors, comparing the latter to driving with “one foot on the gas, one foot on the brake.” The former, meanwhile, hits the serotonin system like a hypersonic missile, pulling in and rearranging nearby receptors in its wake. Thus, the theory goes, neural connections are rapidly reestablished, even after a single session.
“When we think about this idea of neuroplasticity, think about when you’re born, when you’re a baby—you don’t have any connections that know how to do anything, right? Your whole childhood is spent figuring out which connections get you further down the road and which do not. Like, how many times does it take you to learn how to stand?”
Lukas posited. “Well, while you’re doing that you’re tightening the connections that help you stand and throwing away the ones that aren’t effective.
“You’re slowly pruning the forest. By the time you’re an early adult, you’ve gone from being in a jungle to this really robust maple tree […] But then as you get older, some of the richness fades, you get stuck in your ruts, and you’re doing the same thing over again. And the older you get the more trauma you experience,
“There are things under the rug or in the basement that are yearning for your attention, that can’t fi nd your attention because you can’t see them […] but when you can bring your attention to these things you’re able to fi nd healing. A lot of what we do in these clinical trials is looking for tools to prepare someone to take advantage of that experience.”
While Lukas hones her research on psilocybin, she’s a fi rm believer in “psychedelic-assisted” as an umbrella term. From other “classical” compounds like LSD and DMT to “non-classical” drugs like MDMA and Ketamine, Lukas believes psychedelics have the potential to revolutionize treatment for a host of psychological affl ictions when properly ad ministered.
Beyond palliative care, early findings suggest psilocybin may also be effective in treating mood disorders, addictions, and possibly eating disorders. The results of a placebo-controlled study published in Nature Journal in May 2021 revealed that those treated with MDMA against a placebo for moderate to severe PTSD were twice as likely to recover, with an astonishing 71.2% no longer meeting the DSM-5’s diagnostic criteria by the end of the 18-week trial (Mitchell, et al. University of California, San Francisco). Now, MDMA is the first psychedelic in history pending review for full FDA approval.
For others, they can break its seductive gaze.
Wide Angles
Note: Due to legal and privacy concerns, the names of subjects in the following sections have been altered to protect their identities.
“In late January we did psilocybin, and I did not know going into the psilocybin journey that it could be utilized as a treatment for depression,” said Jordan Martin, her husband, Nick, sitting next to her. “But it treated my depression. Nothing had treated my depression, and in fact, I did have a suicide attempt last summer. I mean, I was in a really, really dark place.”
Jordan described a number of physical sensations during the experience—shivering, shaking, crying, laughing. An enormous release of pent up trauma built over 18 years of treatment-resistant depre ssion, then…
“I think it was like, three days after that experience,” she continued. “And my depression was gone. It was like, literally, clouds parting, blue sky, and a sun beaming through. It was just gone. It just vanished, and it was a miracle.”
MARCH/APRIL 2024 // 45 // MARCH/APRIL 2024 // 45 //

// 46 // MARCH/APRIL 2024
Dr. Lou Lukas

The initial series of events that led to Jordan’s full recovery—from a form of depression that not only defied all conventional treatment, but would typically be described with terms like “chronic” and “lifelong”—are only marginally less remarkable.
Married for nearly 10 years, father to two young sons, a thriving small business under his purvey, a “like” on Nick’s Facebook page may well have been a “like” for the American Dream itself. Tragically, much of it was a dream, one that had all but faded to black years prior—an advertisement for a life already spent by domestic strife, the trials of parenthood, the unyielding pressures of business ownership, and walls thick with the miasma of mental illness.
Nick wanted to sell the business; Nick wanted a divorce. He couldn’t muster the courage to carry through with it. Then, a close friend and confidant suggested a way to fi nd it, one he’d never considered before. Equal parts desperate and intrigued, Nick covertly made arrangements and embarked on a solo sabbatical out of state.
“I went to this experience expecting that I was going to divorce Jordan and sell the business. Like, that I was fi nally going to get the courage and the clarity that this is what I need to do,” Nick confessed. “And the experience was exactly the opposite…it became abundantly clear, during my experience, that Jordan was the love of my life, and despite how difficult our marriage was, Jordan and Nick were meant to be forever. And that I love my business and that it was meant to go on for perpetuity.”
The process itself begins with a battery of medicinal precursors, vitamins, minerals, and sessions with guides to frame goals and expectations. The primary medicine used: an injection of ketamine to the arm.
“It was like being shot out of a rocket for the fi rst 15 minutes, seeing visuals and experiencing things I’ve never experienced in my life as I’m listening to music and have blindfolds on, and I’ve got a microphone attached to me, and for the next four hours it’s just a stream of consciousness,” Nick recounted. “Under the influence of this medicine, you’re going to talk for the next two to six hours and just have these calm ‘downloads.’ And then after the fact, you transcribe the entire recording—I listened to it, transcribed it, then I worked with an integrator afterwards to do something with this information.
“My friend said to me, ‘Your ego is the jailer of the soul,’ and the idea behind this outfit is that when your ego goes to sleep, love is what’s left […] It was a real shift in the direction of my life and in my relationships.”
Upon Nick’s return, Jordan was incredulous of the man who stood before her. The one who’d left had been furtive, irritable. Now, proclamations of love and renewed commitment sprang easily from the mouth that’d been tight-lipped mere weeks prior.
“Jordan wasn’t having it,” Nick said, recalling her words at the time: “‘I didn’t have this experience with you and I don’t believe you.’”
Still suspicious and having never experimented with psychedelics before, it took some coaxing from Nick before Jordan agreed to try MDMA as a couple.
“I’ve never considered myself a person who takes drugs, like, I smoked some pot in college, but never did drugs, never desired to do drugs, and you know, with MDMA being a rave drug, or party drug, that scared me a lot,” Jordan said. “But Nick wanted to do an at-home ceremony with the two of us […] and I had a call with the people who provided us with medicine and addressed a lot of my fears around the safety of the drug. Th at was my primary conc ern: safety.
“[Now] we refer to it as December 10, like it’s a holiday for us. It was so profound that it has its own name […] so we did the ceremony, December 10, and we were able to heal a lot of wounds in our marriage. Yet, I was still depressed…”
And a just over a month later, she wasn’t.
“I think that our society just wants to run and take pharmaceuticals, and that dampers our ability to experience true joy, we’re just trying to numb ourselves,” she said. “Th is mode of treatment (psychedelics) is not numbing. It’s facing and truly processing and integrating your trauma and how you got to where you are. And that’s real growth.”
Jordan and Nick plan to continue exploring different “rabbit holes” of their lives via psychedelics. Willed by a promise made at his grandmother’s deathbed, Nick untangled decades of bitter resentment— stemming from a cycle of abuse that saw him channeling his father’s abuse toward his younger brother—during a sibling MDMA ceremony. Still, regardless of these outcomes, the couple cautions moderation and respect for the power of these substances.
“We’re huge advocates for the medicines, and they’re extremely powerful, more powerful than we realized when we started taking them,” Nick said. “When we started, were like, ‘Man, everybody should do this! And then as we got into some of the deepest, darkest, trickiest stuff, we started to change our minds […] This should really be done in the hands of experienced professionals, not recreationally on your own just for fun.”
Dark Room
It was a cold September night when Marie Ledger found herself tramping over brackish leaves and spindly branches toward the dark maw of Elmwood Park’s southern entrance. About 45 minutes before, she and two of her best friends had excitedly passed around ziplock baggies, an earthy scent preceding hasty mouthfuls of “magic mushrooms.” It was their fi rst time, and she reassured them of the great things to come.
But now, though the stars shown bright in the waxy night sky, she couldn’t seem to shake the darkness that stalked the tree line, nor the grasping squelch of mud that pulled at her sneakers. As the green arches of the swing set came into view, and the trio spread their blanket over the grass, Ledger prayed the feeling would pass. Her friends seemed nervous too, but in a giddy way. She placed a clammy hand over her quickening heartbeat—it wouldn’t steady. Her vision began to narrow. Guiltily abandoning her ‘babysitter’ role, she simply couldn’t remain.
“Hey guys…I think I’m going to call an Uber, I’m sorry…”
“Are you okay?” they answered, concerned.
“Yeah, I just want to go home. I want you guys to have fun!”
And with that, Ledger’s plans for a fun night were dashed with the arrival of the Uber, an awkward goodbye, and growing unease.
“You know, honestly, I had such great experiences on [magic mushrooms], such a positive connection to this earth and life that I never gave up an opportunity,” reflected Ledger, a 31-year-old Omaha native working in healthcare. “In fact, I ended up moving out of Nebraska with my significant other, and we actually bought half an ounce of magic mushrooms and I ended up pretty semi-regularly t aking them.”
When Ledger visited her hometown for her aunt’s funeral in 2018 and found out two of her best friends had yet to indulge, she thought it would serve as the perfect distraction from the somber tone of her visit. Her friends, after she left, she’s told, had a lovely time. However, despite the vibrant interior and colorful lights of her driver’s vehicle, Ledger was barreling toward a dark tunnel.
“I knew my friends knew I was distressed, but I also knew I just needed to get to a safe place where I could lay down,” she continued. “I didn’t know what was to come…but I knew I needed to get out of there. I needed to get home.”
The loud music and strobing ambiance of the car only amplified her sense of dread and panic. She called her brother on the way, taking deep breaths as he strained to listen to her panicked voice: “I’m having a very bad time. I’m heading to our parents’ house. I’m having a very bad time.” continued on pg.53
MARCH/APRIL 2024 // 47 //
This list is excerpted from the 2024 topDentists™ list, a database which includes listings for over 110 dentists and specialists in the Omaha Metro Area. The Omaha list is based on thousands of detailed evaluations of dentists and professionals by their peers. The complete database is available at www.usatopdentists.com. For more information call 706-364-0853; write PO Box 970, Augusta, GA 30903 ; email help @usatopdentists.com or visit usatopd e ntists.com.
SELECTION PROCESS
“If you had a patient in need of a dentist, which dentist would you refer them to?”
This is the question we’ve asked thousands of dentists to help us determine who the topDentists should be. Dentists and specialists are asked to take into consideration years of experience, continuing education, manner with patients, use of new techniques and technologies and of course physical results.
The nomination pool of dentists consists of dentists listed online with the American Dental Association, as well as all dentists listed online with their local dental societies, thus allowing virtually every dentist the opportunity to participate. Dentists are also given the opportunity to nominate other dentists that they feel should be included in our list. Respondents are asked to put aside any personal bias or political motivations and to use only their knowledge of their peer’s work when evaluating the other nominees.
Voters are asked to individually evaluate the practitioners on their ballot whose work they are familiar with. Once the balloting is completed, the scores are compiled and then averaged. The numerical average required for inclusion varies depending on the average for all the nominees within the specialty and the geographic area. Borderline cases are given careful consideration by the editors. Voting characteristics and comments are taken into consideration while making decisions. Past awards a dentist has received as well as status in various dental academies can factor into our decisions.
Once the decisions have been finalized, the included dentists are checked against state dental boards for disciplinary actions to make sure they have an active license and are in good standing with the board. Then letters of congratulations are sent to all the listed dentists.
Of course there are many fine dentists who are not included in this representative list. It is intended as a sampling of the great body of talent in the field of dentistry in the United States. A dentist’s inclusion on our list is based on the subjective judgments of his or her fellow dentists. While it is true that the lists may at times disproportionately reward visibility or popularity, we remain confident that our polling methodology largely corrects for any biases and that these lists continue to represent the most reliable, accurate, and useful list of dentists available anywhere.
DISCLAIMER
This list is excerpted from the 2024 topDentists™ list, which includes listings for more than 110 dentists and specialists in the Omaha Metropolitan area. For more information call: 706-364-0853 or email: help@usatopdentists.com or visit: www.usatopdentists.com
topDentists has used its best efforts in assembling material for this list but does not warrant that the information contained herein is complete or accurate, and does not assume, and hereby disclaims, any liability to any person for any loss or damage caused by errors or omissions herein whether such errors or omissions result from negligence, accident, or any other cause. Copyright 2010-2022 by topDentists, LLC of Augusta, GA. All rights reserved. This list, or parts thereof, must not be reproduced in any form without permission. No commercial use of the information in this list may be made without permission of topDentists. No fees may be charged, directly or indirectly, for the use of the information in this list without permission.
ENDODONTICS
THOMAS J. BEESON
Parra Family Dentistry
TOBIN N. DRAKE
Endodontic Associates
JACOB L. FIMPLE
Advanced Endodontic Therapy
PATRICK K. HAFFEY
Nebraska Micro-Endodontics
MICHAEL S. HERMSEN
Heartland Endodontic Specialists
JOSE L. IBARROLA
Creighton University
School of Dentistry
SUNG WOO KANG
Advanced Endodontic Therapy
COREY K. KARIMJEE
Midwest Endodontics
CACI I. LIEBENTRITT
New Wave Endodontics
DAVID A. MAIXNER
Midwest Endodontics
STEPHEN P. PRYOR
Endodontic Specialists
CHRISTOPHER J. REDD
Heartland Endodontic Specialists
GARRETT SCHULTZ
Nebraska Micro-Endodontics
FRANK S. SLEDER, SR
Creighton University
School of Dentistry
GENERAL DENTISTRY
ANTHONY R. BOLAMPERTI
Omaha Laser Dentistry
THEODORE J. BOLAMPERTI
Omaha Dentistry
JARED D. BOLDING
Bolding Dentistry
THOMAS J. BOLT
TJ Bolt, DDS
T. PAT BURCHFIEL
Burchfiel Dental
BRAD W. CARSON
Pacific Village Dental
AMY T. CHADWELL
Chadwell Family Dentistry
JEFFRY F. CHEREK
Cherek Family Dentistry
RALPH M. CORPUZ
Corpuz Family Dentistry
WILLIAM A. DABBERT
Weeping Water Dental
MICHAEL C. DANAHAY
Dental Innovations
KATHERINE L. DEFORD
DeFord Family Dental
JEFFREY D. DWORAK
Capehart Family Dentistry
CHRIS P. FOIX
Shadow Lake Family and Cosmetic Dentistry
MARK C. FRILL
Portal Ridge Dental
GENE M. GASPARD
Family Dentistry Bellevue
KENDRA L. GOSCH
Gosch Family Dental
JEROME F. GRADOVILLE
Creighton University
School of Dentistry
BENJAMIN G. HARDY
Hardy Dental
GREGORY A. HAVELKA
Gregory A Havelka DDS
MICHAEL J. HOOVER
Hoover Dental
TERRY F. LANPHIER
Creighton University
School of Dentistry
KIRSTIN T. MCCARVILLE
Clear Choice Dental
JAMES F. MCCASLIN
Evergreen Dental Group
STUART J. MCNALLY
Millard Hills Dental Health Center
CAROL M. MURDOCK
Creighton University
School of Dentistry
MATTHEW C. NEUMANN
Serenity Dental
JEFFREY R. NIELSEN
Bel Drive Dental
MARK J. PANNETON
Panneton Dental Group
BRIAN S. PENDLEY
The Dentists at Village Pointe
CASSANDRA J. PIETROK
Pacific Hills Dental
SCOTT M. RADNIECKI
Creighton University
School of Dentistry
SUGIKO M. REED
Ohana Smiles
SARA REMM
Summit Dental Health

VILLAGE POINTE ORAL SURGERY & DENTAL IMPLANT CENTER
As a privately run local business, Village Pointe Oral Surgery & Dental Implant Center is proud to treat its patients not just like clients, but rather, like family members.
“We focus on quality, from the materials we use to everything else,” said oral and maxillofacial surgeon Dr. Michael Shnayder. “As a local, non-corporate business, we have that personal approach.”
The growing practice has recently added a new surgeon, Dr. Maria Nord. The practice serves patients of all ages, offers a full scope of oral and maxillofacial surgery, ranging from dental implant surgery and wisdom tooth removal to facial trauma and oral pathology. The comprehensive practice also provides a wide range of aesthetic spa services, including a skin resurfacing Sciton laser. Treatments include BBL Hero, Pro Fractional, MicroLaser Peel, laser hair removal, and Halo. Results can include collagen growth and skin tightening and resurfacing as well as improvement of areas of concern like age spots, sun damage, collagen growth, fine lines and wrinkles, hyperpigmentation, acne scars, and other scars.
“It’s an amazing technology that’s a huge advancement,” Dr. Shnayder said. “I like embracing new technology.”
Village Pointe Oral Surgery & Dental Implant Center
17121 Marcy St., Ste. 102 Omaha, NE 68118 402.317.5657 vpoms.com
// SPONSORED // MARCH/APRIL 2024 // 49 //
JAY D. SAMUELSON
The Dentists at Hillsborough
MICHAEL R. SESEMANN
Nebraska Institute of Comprehensive Dentistry
RANDY E. STOUT
CAROLYN L. TAGGART-BURNS
Millard Oaks Dental
BRETT H. TAYLOR
Taylor Dentistry
BRETT S. THOMSEN
Thomsen Dental Group
ANTHONY VONDRA
Briar Hills Dental
DEBRA S. WEST
KARRY K. WHITTEN
Whitten Dentistry
ORAL AND MAXILLOFACIAL SURGERY
COREY J. AUCH
Oral Surgery Associates
STEPHEN A. COFFEY
Oral Surgery Associates
VALMONT P. DESA
Nebraska Medicine
JOHN D. ENGEL
Oral Surgery Associates
JAMES O’BRIEN
Omaha Oral Surgery
AFOLABI O. OGUNLEYE
Premier Oral & Maxillofacial Surgery
ROBERT M. PFEIFLE
Oral Surgery Associates
BLAIR RACKER
Omaha Oral Surgery
CALEB SCHADEL
Omaha Oral Surgery
MICHAEL I. SHNAYDER
Village Pointe Oral Surgery
17121 Marcy St., Ste. 102 Omaha, NE 68118 402.317.5657
vpoms.com
KAREN A. TUCKER
Nebraska Medicine
JEROME M. WEES
Midwest Oral Surgery & Dental Implants
JOHN P. WEWEL
Midwest Oral Surgery & Dental Implants
ORAL PATHOLOGY
HARDEEP K. CHEHAL
Creighton University School of Dentistry
ORTHODONTICS
MATTHEW J. BECKER
Imagine Orthodontics
NEIL E. DUNLOW
Dunlow Orthodontics
NATHAN HAWLEY
Hawley Orthodontics
THOMAS J. HUERTER
Huerter Orthodontics
KORT A. IGEL
Igel Orthodontics
ANTONIA E. JONES
Nia Jones Orthodontics
TAERA KIM
Metro West Orthodontics & Periodontics
LAURA E. LOW
Wees & Low Orthodontics
BRIAN MCINTYRE
Omaha Orthodontics
MARK MENDLIK
Mendlik Orthodontics
JULIE E. OLSON
Olson Orthodontics
BARBARA J. RIES
TIMOTHY J. SHEEHAN
The Orthodontic Group
KIMBERLEY A. STAFFORD
Stafford Orthodontics
THOMAS J. WEBER
Weber Orthodontics
JULIE WEES
Wees & Low Orthodontics
PEDIATRIC DENTISTRY
ANNE S. AIELLO
Creighton University School of Dentistry
CARMEN L. DANA
Pedodontics, PC
HANNAH GREENE
My Pediatric Dentist
J. BRYAN HOHENSTEIN
Smile Station Pediatric Dentistry
DARIN L. KOTIL
Smile Academy
MATTHEW D. SCHIEBER
Smile Station Pediatric Dentistry
LOURDES M. SECOLA
West Maple Pediatric Dentistry
SCOTT D. SEILER
AMANDA M. SNYDER
Smile Station Pediatric Dentistry
// 50 // MARCH/APRIL 2024
LISA F. STRUNK
Pedodontics, PC
ANGELI J. THAKKER
Bellevue Pediatric Dentistry
BARRY W. WEBBER
Walnut Creek Pediatric Dentistry
GREG WEEDER
Weeder Pediatric Dentistry
NICHOLAS C. WOODWARD
Skyline Pediatric Dentistry
PERIODONTICS
DENNIS M. ANDERSON
Gum Disease Specialists
NATALIE A. FROST
Frost Periodontics & Dental Implants
JESSICA GRADOVILLE
Western Iowa Periodontics & Implant Surgery
MATTHEW R. KELSEY
Kelsey Periodontal Group
W. PATRICK KELSEY V
Kelsey Periodontal Group
MELISSA S. LANG
Creighton University
School of Dentistry
Metro West Orthodontics & Periodontics
TAKANARI MIYAMOTO
Metro West Orthodontics & Periodontics
STACY L. MOFFENBIER
PROSTHODONTICS
ANDREA L. HALL
Millard Hills Dental Health Center

BOLDING DENTISTRY
Bolding Dentistry is humbled and honored to be awarded Top Dentist for the 5th year in a row! We are grateful to be recognized.
We believe patient education is the foundation for building a healthy relationship with us, your dental team. We promise to communicate openly and honestly with you regarding your dental health. With the advances in technology, dental materials are ever-changing and our team takes pride in staying on-top of the latest information to provide the highest quality of dental care to you and your family. This requires many hours of continuing education learning the latest methods and techniques about how to safely deliver quality care.
My wife, Michaela, and I have three children whom we enjoy raising in our growing hometown of Omaha. Outside of the office, I enjoy being active, spending time with family and friends and coaching my childrens’ sports teams-especially basketball. My family is of the utmost importance to me, and I have quickly come to appreciate my ever growing “dental family” of supportive patients with whom I’ve built some great relationships.
Bolding Dentistry sees patients from 2 to 102 years old. We offer comprehensive oral health services including teeth cleanings, oral cancer screenings, periodontal treatment as well as crowns, fillings, and dentures. We offer many cosmetic solutions like veneers, clear aligner orthodontics, and full-arch dental implant prosthetics.
I look forward to welcoming you as part of the Bolding Dentistry family so you can share your smile for a lifetime!
Bolding Dentistry
10110 Nicholas St. Omaha, NE 68114
402.393.4400
boldingdentistry.com


continued from pg.47
Upon arriving at her parents’, she called her significant other, who urged her to induce vomiting. But it was too late; the psilocybin had already metabolized. The intrusive thoughts were here to stay.




“If you can imagine every uncertainty that you have in your life rearing, it’s all in the room with you, no matter where you look or sit, just looking at you and begging for an answer…and it just seemed I gave in, and I said I didn’t have an answer,” she said. “Every insecurity, every unaddressed, unsettling thought you’ve had about your life. Being in your mid-20s, it’s easy to confront them. But having them all in the same room with you, almost having their own face, was just so overwhelming…
“I remember going into my brother’s room and just pulling his comforter over me and just laying in the fetal position, trying to block them out of my head.”
They didn’t relent. Childhood traumas, the morbidity of her aunt’s death, sharp claws of regret—over her career choice, her living situation, her bad habits, friendships lost— tightened their grip on her psyche. She lay in a ball, begging for it to end; she began to believe it never would.
“I’m going to always have this perspective. I’m stuck here with this perspective and this is just how I’m going to view the world […] I don’t want to create a life off of this basis, it hurts too much,” she recalled thinking. “I just thought, ‘Death sounds so sweet.’”
Th ankfully, her brother fi nally arrived home. He held her, told her he loved her, and offered her sage advice.
“He said one thing that really stuck out to me that I remember pivoting my mind, as like, a foothold out of darkness,” Ledger said. “He said, ‘Marie, I’ve been there before, and I can promise you it’s temporary. I can promise you the feelings you are feeling right now you will not feel them forever. You just have to give it time.’”
Eventually, his words became truth, and the psychoactive effects dwindled away. But they left scars on their way out. Ledger fell into a deep depression for months afterwards in what she describes as the “darkest time of [ her] life.”
“And that’s when I had to start rebuilding my perspective of myself, and it was not easy,” she conceded. “I always prided myself on being introspective before, but this [experience] just tore down myself. My ego, my pride, my perception of myself and other people, just points I hadn’t even deeply considered.”
Despite all this, Ledger has come to embrace the transformative, however torturous, lessons learned that night. When asked if she regrets the experience, she answered:
// 52 // MARCH/APRIL 2024 HILLSBOROUGH 13808 W. Maple Rd. Omaha, NE 68164 402.445.4647 RALSTON SQUARE 5360 S. 72nd Street Omaha, NE 68127 402.733.4441 VILLAGE POINTE 302 N. 168th Circle Omaha, NE 68118 402.505.7474 DUNDEE 119 N. 51st Street Omaha, NE 68132 402.502.5593 WWW.THEDENTISTSOMAHA.COM SELECTED BY THEIR PEERS AS THANK YOU FOR VOTING US BEST FAMILY DENTIST 17 YEARS IN A ROW! CONGRATS DR. JAY SAMUELSON! BEST COSMETIC DENTIST 2024 “XXXXXXX” “XXXXXXX”
“Absolutely not. I don’t regret it in the fact that I feel that I have met my psychological rock bottom. I’ve seen myself reach lows I didn’t know were possible, and I put in the work to get to where I am now,” she explained. “It’s given me more self confidence. How do you get to know yourself unless you’ve been through trials and tribulations? It gave me a new perspective that I’m very thankful for. Going through it, I wanted to die. But looking back, I know myself so much better for going through it.”
Ledger demurred that she was likely overdue for a “bad trip,” given the frequency and recklessness of her usage. She’s even ‘tripped’ a few times since, though she’s far more mindful of the amount ingested, the variety of the fungus, and especially, the capabilities of the molecule inside.
“I would never approach the drug in the same way,” Ledger affi rmed. “A healthy, cautious amount of respect for its power is key to fully enjoying and benefiting from it.”
Development
“There’re two entirely different kinds of phenomena. One is called ‘challenging experiences.’ Say you’re in your psychedelic trip, and you are trapped in a graveyard that you can’t get out of or whatever. People with support get through those, and they often fi nd them beneficial,” Lukas said of so-called “ bad trips.”
“But there are these other experiences, where when you come back, things are not right […] a small amount of them, but the phenomenon is known. We’d like to know more, which is why we need more research,” she added.
Isolation and unknown dosages are two of the strongest predictors of such experiences. In a clinical setting, they’re virtually unheard of.
As for the future of psychedelic-assisted therapy in Nebraska, Lukas is already looking ahead. She’s currently raising local funds to launch a safety study on exploring psilocybin’s impact on alcoholism, noting the high number of young people who die of alcohol-related disease here relative to the E ast Coast.
“They’re not candy, they’re not magic— they’re some of the most powerful substances we have,” she concluded, reiterating the untold benefits of harnessing, rather than abusing or neglecting, this power.
“The therapeutic effect will be worth it.”

For more information, visit palliadelic.org.



On view through March 16, 2024 REMBR AND T • GOYA • DÜRER April 5 - July 27, 2024 Frida Kahlo and the Blue House 4701 SOUTH 25TH STREET OMAHA, NE 68107 (402 731-1137) • www.elmuseolatino.org THE MARVEL OF OLD MAS TERS MARCH/APRIL 2024 // 53 // MAY 2023
BA ER UP! "Y
UNO’S PITCHING LAB KEEPS ATHLETES IN SYNC
ou want your body to be moving very smoothly and in sync,” explained Dr. Brian Knarr, Co-director of University of Nebraska Omaha’s Biomechanics Pitching Lab. “When it’s out of sync, that's usually when you have injuries or pain, and it's where you leave energy on the table. You want all of that energy you’re generating to go into the ball. If you're moving inefficiently, that energy gets lost by having to catch up or move in incorrect ways.”
Fortunately for athletes all over the country, UNO’s Sports Medicine and Biomechanics Lab is equipped to evaluate both clinical and performance data to protect an athlete from injury while helping them reach for the next goal. Currently, only a handful of similar labs can be found in research universities across the US.
“I looked at everything in the US, but this pitching lab is my big reason for being here,” said Takato Ogasawara, a student in UNO’s Biomechanics master’s program, who performs analyses on the lab’s clients. “I was working as an athletics trainer, but I felt like I needed to understand more of the ‘why.’ Like, for example, in baseball, if I look at just the body without the pitching, I’m only seeing how things are outside the movement. In the pitching lab, I can know which muscle they’re specifically using or what is the range of motion within the movement. You can sort of see it [without these tools], but it’s hard.”
Th ink of the behind-the-scenes footage you’ve seen of all those superhero movies—specifically, the actor wearing what looks like a bunch of shiny little ping-pong balls. “Th at is the exact same technology that’s used in biomechanics historically,” Dr. Knarr said. “Those allow us to reconstruct someone's skeleton in software.”
A typical evaluation takes about two hours. After a clinical analysis of an athlete’s strength range, motion flexibility, and overall joint health, a biomechanist—or, say, a biomechanist student like Ogasawara—places retro-reflective markers on the athlete’s body, indicating where certain anatomical features are and where specific parts of the body would be in space as the athlete moves around the lab.
“We analyze the actual pitching movement,” Ogasawara explained, “measuring things like
how fast they move and how much stress they put on their elbow, their shoulder—that kind of stuff.”
The lab’s custom pitching mound is encircled by 20 cameras (around $10,000 apiece) and is composed of three six-degrees-of-freedom force plates ($20,000 apiece) that record all the ways an athlete imparts force onto the mound. The motion capture data and the force plate data are fed into a program such as Visual3D, which creates a model of the athlete for analysis.
“Ideally, about a week post-evaluation, the athlete meets one-on-one with our lead biomechanist,” explained Dr. Adam Rosen, co-director of the lab with Dr. Knarr. “He will sit with them for about an hour and go through the data with them rather than just sending the report.”
“Historically, other places that have implemented this type of system take all that data, dump it on a spreadsheet, and say, ‘Here you go,’” Dr. Knarr said. “No one knows what to do with that data, because you're giving non-biomechanists and non-athletic trainers biomechanist data. So, we do all the distilling, and we say, ‘Here are the two things we think you should address fi rst, because these are probably the biggest things you have to fi x before anything else can get fi xed.’ And we give them drills or suggestions on how to do that.”
“The number one reason people come to us is ‘I want to throw faster.’ How do they increase their spin rate, get more movement on their fast ball?”
-Dr. Adam Rosen
While UNO’s Biomechanics Lab does, of course, serve UNO’s athletes, its clients are mostly private individuals. “We've seen everyone from 8-year-olds all the way to professional pitchers,” Dr. Rosen said. The lab’s most common client, however, is probably the aspiring professional—someone who wants to be seen and wants to get drafted. “The number one reason people come to us is ‘I want to throw faster.’ How do they increase their spin rate, get more movement on their fast ball?”
The next major endeavor for the lab is to
SPORTS // STORY BY CHRIS WOLFGANG // PHOTOGRAPHY BY BILL SITZMANN //DESIGN BY RENEE LUDWICK MARCH/APRIL // 54 // 2024


"In the pitching lab, I can know which muscle they’re specifically using or what is the range of motion within the movement. You can sort of see it [without these tools], but it’s hard.”
-Takato Ogasawara
expand more into servicing women's athletics. “The last year or so, we've made a lot of acceleration on softball pitching,” Dr. Knarr explained. “We've partnered with OGX [a company that advances softball development through individualized, science-backed programs] to develop the same level and fidelity of pitching analysis in softball as we have in baseball, which currently doesn't ex ist at all.”
Is analyzing a softball player so different from analyzing a baseball player?
“It is literally 180 degrees different, which has historically been the problem,” Dr. Knarr said with enthusiasm. “A lot of people think they can translate the biomechanics of baseball pitching, an overhead-throwing motion, to softball pitching, which is an underhand-throwing motion. They are fundamentally entirely different.”
The historical neglect of softball, not to mention other women’s sports, in research and technology can to some extent be blamed on lesser profitability in the market, but fortunately, as Dr. Knarr said, “Th is is the academic side of it, right? Running this as an academic endeavor and not like a business endeavor, we can focus on where we can help people the best.”
For more information about UNO’s Pitching Lab or to book a consultation, visit unomaha.edu/college-of-education-health-and-human-sciences/ sports-medicine-and-biomechanics.


OMAHA’S OMAHAMAGAZINE.COM/PAGES/SUBSCRIBE
OF BUSINESS THE
FUTURE
SPORTS // 56 // MARCH/APRIL 2024 NS_OmahaMagAd.indd 1 1/19/24 4:51 PM





Visit our store in the Old Market or check out the website to see what makes us an industry leader. 402.342.2885 | bigbrainomaha.com 1123 JACKSON STREET, OMAHA, NE 68106 2024 First Place Tattoo Parlor Omaha’s Famous For Quality Tattoos Since 2000 MARCH/APRIL 2024 // 57 // KocaChiropractic.com 11420 Blondo St, Ste. 102 | 402.496.4570 2024 First Place Chiropractor SPRING IS COMING ALWAYS LOCAL, ALWAYS BEAUTIFUL. Included with an Omaha Magazine Subscription.
GIVING CALENDAR
MARCH/APRIL 2024
COMPILED BY CLAUDIA MOOMEY

March 1-2
BOWL FOR KIDS’ SAKE
Benefits: Big Brothers Big Sisters of Central Nebraska
Location: Westside Bowling, Grand Island —allevents.in/grand island/ bowl-for-kids-sake/200025994219854
March 2
HEAT THE STREETS RUN & WALK FOR WARMTH
Benefits: Dollar Energy Fund
Location: Aksarben Village —heatthestreetsomaha.org
March 3
20TH ANNUAL WALK & ROLL FOR DISABILITIES
Benefits: Meyer Foundation for Disabilities
Location: Oak View Mall —mfdisabilities.org
March 3
YFC BE THE STORY 2024
Benefits: Omaha Youth for Christ
Location: Top Golf —goyfc.regfox.com/be-the-story-2024
March 5
VOLUNTEER CLUB
Benefits: Open Door Mission
Location: Garland Thompson Men’s Center Chapel —opendoormission.org
March 24
FEATURED EVENT
Guns & Hoses Hockey Challenge
BENEFITS: FIRST RESPONDERS FOUNDATION
Location: Baxter Arena
Local police and firefighters compete on ice for a good cause! Will Team Blue be the reigning champions, or will Team Red take the trophy? Bring the crew out to cheer on first responders and enjoy an exciting hockey game, vendor booths, giveaways, and more. This family-friendly event will allow kids to check out the cool first responder vehicles parked out front and activities in the Kids Zone.
March 9
March 5
TUESDAY TEA TIME WITH DORARENA
Benefits: Women of Wisdom
Location: Virtual Event —womenofwisdominc.org
March 9
OMAHA SPORTS COMMISSION SPELLING BEE
Benefits: Omaha Sports Commission
Location: Strauss Performing Arts Center —omahasports.org/spellingbee
March 9
SPORTS FOR KIDS 33RD ANNUAL SPORTS MEMORABILIA BENEFIT AUCTION
Benefits: Sports for Kids Foundation
Location: The DC Center --sportsforkidsfoundation. com/auction
March 10
ART & SOUP 2024
Benefits: Visiting Nurse Association
Location: Omaha Design Center —nonprofitam.org
March 11-15
STEM DAY CAMP
Benefits: Gifford Farm Education Center
Location: Gifford Farm Education Center —esu3.org
March 16
March 14
2024 NEBRASKA BRAIN INJURY CONFERENCE
Benefits: Brain Injury Alliance of Nebraska
Location: Younes Conference Center (South) —biane.org
March 14
2024 POT O’ WISHES
Benefits: Make-A-Wish Foundation
Location: Venue 304, North Platte —wish.org/nebraska/2024-pot-owishes
March 16
32ND ANNUAL IRISH FEST
Benefits: Catholic Charities of Omaha
Location: Marriott Hotel Capitol District —ccomaha.org
March 19
LIVING A GOOD LIFE…THROUGH SERVING OTHERS
Benefits: Nebraska Hospice and Palliative Care Association
Location: Embassy Suites —nehospice.org
// 58 // MARCH/APRIL 2024
March 19-20
SANDHILL CRANE MIGRATION BUS TOUR
Benefits: Lauritzen Gardens
Location: Mobile —lauritzengardens.org
March 20
STRONGER TOGETHER LUNCHEON
Benefits: Completely KIDS
Location: Scott Conference Center —completelykids.org/events/ stronger-together
March 23
OMAHA MOM PROM 2024
Benefits: Band of the Strong
Location: The Steppe Center —ticketstripe.com/omp2024
March 23
THE ENGAGEMENT PARTY
Benefits: Nebraska Ataxia
Location: 7400 Western Ave —nebraskaataxia.org
March 23
GREATER OMAHA ORCHID SOCIETY ORCHID SHOW AND SALE
Benefits: Lauritzen Gardens
Location: Lauritzen Gardens —lauritzengardens.org
March 23
2024 HABITAT HEROES
Benefits: Habitat for Humanity
Location: Hopkins Arena, Fremont —allevents.in/fremont/2024-habitat-heroes
March 23
9TH ANNUAL FUNDRAISING GALA “LITTLE ITALY”
Benefits: Bennington Public Schools Foundation
Location: A View on State —benningtonschoolsfoundation.org
March 24
WILDLIFE TRIVIA NIGHT
Benefits: Nebraska Wildlife Rehab
Location: Blue Sky Patio & Pickleball —nebraskawildliferehab.org
March 29
IN CONVERSATION: CURATOR CAMILO SANCHEZ AND ARTISTS PAOLO
ARAO AND RON NORSWORTHY
Benefits: Bemis Center for Contemporary Arts
Location: Bemis Center for Contemporary Arts —bemiscenter.org
March 30


March 29
SPRING CELEBRATION AND EGG SCAVENGER HUNT
Benefits: Gifford Farm Education Center
Location: Gifford Farm Education Center —esu3.org











D.J.’s Hero Awards
It’s a special 25th anniversary celebration: notable scholarship winners from years past will join D.J.’s Hero Awards co-founder David Sokol for an onstage discussion of how the awards program has positively impacted the lives of students, families, and communities around Nebraska.
or scan the QR code to purchase tickets.








djshero.org
Visit
Luncheon May 7, 2024 | 11:30 a.m. CHI Health Center Omaha
// GIVING CALENDAR // MARCH/APRIL 2024 // 59 //
2024 First Place
Caterer


OUR TOP PROVIDERS
Salina Anderson, APRN
Geraldine Alexis, LIMHP, PLADC
Julie Bierman, LCSW, LMHP
Chantel Bruha, LIMHP, LADC
Korrie Conners, LMHP, CSAT
Kirby Davis, LMHP
Peggy Deaver, LIMHP, CPC
Davin Dickerson, APRN
Beth Farrell, LCSW, LIMHP
Dumayi Gutierrez, PhD, LMHP
Lucy Hancock, MA
Charlene Hills, LCSW, LIMHP
KG Langdon, APRN
Mary Loftis, LMHP, CPC
Kim Mueller, LIMHP, CPC
Nicole Obrecht, LIMHP
Kara Schneider, BA
Marty Stoltenberg, APRN-BC
Kristi Tackett-Newburg, PhD, LIMHP
Greg Tvrdik, LIMHP, CPC
Sarah Wenzl, LMHP, CPC
Michele Yanney-Wehbi, LIMHP, CPC
March 31
EASTER BRUNCH
Benefits: Lauritzen Gardens
Location: Lauritzen Gardens —lauritzengardens.org
April 1
WOMEN WITH DRIVE
Benefits: Omaha Sports Commission
Location: Miracle Hills Golf Course —omahasports.org/wwd
April 2-3
SPEAKING OF CHILDREN LUNCHEON & CONFERENCE
Benefits: Project Harmony
Location: Embassy Suites La Vista —projectharmony.com/events/ speaking-of-children
April 3
MENTAL HEALTH ROUNDTABLE
Benefits: The Wellbeing
Partners
Location: UNO Community Engagement Center —thewellbeingpartners.org
April 4
NEBRASKA WOMEN IN STEM CONFERENCE
Benefits: Nebraska Cures
Location: Embassy Suites —nebraskawomeninstem.com
April 5
April 3
CABARET 2024: LAUGHING SO KIDS KNOW LOVE
Benefits: Child Saving Institute
Location: Embassy Suites —childsaving.org
April 5-6
VINNEBRASKA 2024 WINE TASTING & GRAND AUCTION
Benefits: Stephen Center
Location: Omaha Marriott Downtown at the Capitol District —stephencenter.org
April 9
THE QUEEN’S SIX: FROM WINDSOR WITH LOVE
Benefits: Vesper Concerts

April 5-6
Location: Presbyterian Church of the Cross —vesperconcerts.org/queens-six
April 10
GEOMETRY OF A LEADER RETREAT
Benefits: Youth Frontiers, Inc.
Location: Benson Theatre —youthfrontiers.org
April 13
BIANNUAL FUNDRAISING FOR MYELOMA PATIENTS
Benefits: Calistus Multiple Myeloma Foundation —calistusfoundation.org
// GIVING CALENDAR //
// 60 // MARCH/APRIL 2024
2024 First Place Counseling Services VOTED FIRST PLACE! -8 YEARS IN A ROWCOUNSELING CONNECTIONS & ASSOCIATES
Dr. Kristi Tackett-Newburg Founder/Owner
* Counseling * Psychotherapy * Medication Management * EMDR Therapy * Online Therapy * Performance / Leadership / Emotional Wellness Coaching * Addiction Treatment * Substance Abuse Evaluations * Couples Therapy 9802 Nicholas Street, Unit 350, Omaha, NE 68114 402-932-2296 | appointments@ccaomaha.com | www.ccaomaha.com
2024 First Place Counseling #1 Couples Counseling #1 Counseling Services Radio Talking Book Service 402.572.3003 | rtbs.org We bring the printed word to life!
Couples • Radio Application • Listen LIVE • Podcasts • Program Schedule • Audio Description • Volunteer • Donate
RTBS is a nonprofit radio station that broadcasts print media read by volunteers to over 11,000 blind, low vision, or print impaired listeners across Nebraska and southwest Iowa.
April 13
UNBREAKABLE
Benefits: River City Mixed Chorus
Location: Orpheum Theater —rcmc.org
April 18
2024 SPRING LEADERSHIP ETHICS LUNCHEON
Benefits: Business Ethics Alliance
Location: UNO Scott Conference Center —members.businessethicsalliance. org/events
April 20
ARTVENTURE 20TH ANNIVERSARY RECEPTION AND SILENT AUCTION
Benefits: Girl Scouts Spirit of Nebraska
Location: UNO Mammel Hall —girlscoutsnebraska.org
April 21
OMAHA CORPORATE CUP
Benefits: American Lung Association
Location: Aksarben Village —omahacorporatecup.donordrive.com
April 22
DR. MICHAEL GREGER
Benefits: Lifestyle Health Alliance
Location: Omaha Community Playhouse —healthyforalifetime.org
April 23
IGNITE THE FLAME
Savings
Benefits: College of Saint Mary
Location: Lied Fitness Center Fieldhouse, College of Saint Mary Campus —csm.edu
April 24
ARTVENTURE 20TH ANNIVERSARY RECEPTION AND SILENT AUCTION
Benefits: Girl Scouts Spirit of Nebraska
Location: UNO Mammel Hall —girlscoutsnebraska.org
April 25
2024 CELEBRITY SPORTS NIGHT
Benefits: Nebraska Greats Foundation
Location: Relevant Center —nebraskagreatsfoundation.org
April 27
2024 JDRF ONE NIGHT GALA
Benefits: JDRF Nebraska-Iowa Chapter
Location: CHI Health Center Omaha —jdrf.org/nebraskaiowa
Event times and details are correct as of presstime, but are subject to change.
Omaha Magazine encourages readers to visit venues' websites and/or calling ahead before attending an event or visiting a museum.


Sring into Savings
kidzshoppeomaha.com | hizandherzomaha.com April 10-13, 2024 Consignor Registration Opens February 12 th Kids • Juniors • Adults Clothing, Shoes, Accessories, Home Goods & MORE! CONSIGN . VOLUNTEER . SHOP 2024 First Place ClothingConsignmentStore
18 // GIVING CALENDAR //
April
MARCH/APRIL 2024 // 61 // 402.558.3500 Corner of 50th & South Saddlecreek 402-502-8757 Southwest Corner of 144th & Industrial Rd 402.502.5511 Southwest corner of 120th & Maple 402.933.9400 Corner of Washington & Lincoln, Papillion SETTING THE STANDARD IN COLLISION REPAIR MECHANICAL REPAIR 2024 First Place Auto Body Repair 2024 First Place Auto Body Repair 402.991.2848 / Southwest Corner of 120th & Maple 1ST PLACE 19 STRAIGHT YEARS! Corner of 50th & South Saddlecreek Southwest Corner of 144th & Industrial Rd Southwest corner of 120th & Maple Corner of Washington & Lincoln, Papillion 1ST PLACE 18 STRAIGHT YEARS! MECHANICAL REPAIR 2023 First Place Auto Body Repair 2023 First Place Auto Body Repair “We’d Rather Be The Best Than Apologize for Anything Less.” “Need an estimate? Visit Dingmans.com to schedule your estimate today.” 402.991.2848 / Southwest Corner of 120th & Maple
GIVING PROFILE
Nebraska Cures
STORY BY KARA WESELY PHOTOGRAPHY BY BILL SITZMANN DESIGN BY RACHEL BIRDSALL
Connecting Science to Community
t face value, laser tattoo removal, smallpox vaccines, and anesthesia don’t seem to have much in common. But if you dig a little deeper, you’ll discover each is rooted in the same concept: medica l research.
Without medical research, that pesky tattoo with an ex’s name would be much more difficult to remove; the smallpox vaccine would not exist, allowing the deadly disease to continue spreading; and the dangers of a surgical world before anesthesia would still be a reality, making even the toughest patient s squeamish.
While medical research has paved the way for countless advances in medicine from which society has heartily benefitted, the average Omaha native likely takes little time to consider it. When it comes to the arena of medical research advocacy and education, the likelihood shrinks even more.
Nebraska Cures aims to change that. The nonprofit’s mission is to promote, support, and advocate for scientific research and education to advance quality of life and economy. Their goal is to help society understand and embrace the importance of scientific research, a mission that Nebraska Cures board chairman, Dr. David Crouse, embraces wholeheartedly.
“We really want to help the public understand the importance of medical research and how that research advances the knowledge of medical professionals, allowing them to develop new treatments, new equipment, and new drugs. Those new developments positively impact the health of all individuals leading to a better quality of life,” Crouse explained.
In addition to medical research advocacy and education, Nebraska Cures focuses on maternal child health, mental health, and the impact of climate chang e on health.
“Climate change has become a somewhat controversial issue. Our efforts strive to help people remove the politics and understand the fact that our climate is changing,” Crouse said. “Those changes impact physical and mental health. If you’re left homeless because of a flood or don’t have access to medical treatment because of a severe weather event, your mental and physical health will b e impacted.”
One challenge the organization regularly faces is sensitively navigating conversations around controversial topics. Nebraska Cures Executive Director, Amanda McGill Johnson, has experienced more success when starting those conversations from a place of und erstanding.
“It is important to lead with compassion and to truly listen to the concerns of each individual,” Johnson explained. “We acknowledge their worries and don’t discount them. We then try to provide facts, always recognizing that we are not going to change minds overnight.”
Given the complexity of the issues Nebraska Cures prioritizes, it’s necessary that their approach takes many forms. They regularly present to community organizations such as Rotary and Optimist Clubs, host “lunch and learns,” and support and sponsor legislative bills. They also partner with other organizations to advance the ir mission.
A recent partnership with Bio Nebraska and the University of Nebraska at Omaha Center for Public Affairs Research led to the development of the Listen Then Act report, which celebrates women in STEM (science, technology, engineering, and mathematics) and highlights the barriers they face. It also provides recommendations on recruiting and retaining women in S TEM careers.
Johnson, who at one point considered pursuing a physics major, is passionate about Nebraska Cures’ efforts to support wom en in STEM.
// 62 // MARCH/APRIL 2024

“It is important to lead with compassion and to truly listen to the concerns of each individual. We acknowledge their worries and don’t discount them. We then try to provide facts, always recognizing that we are not going to change minds overnight.”
—Amanda McGill Johnson
Amanda McGill Johnson

SEASON TICKETS ON SALE
OCT 27 & 29, 2023
DON PASQUALE
FEB 16 & 18, 2024
LA TRAVIATA
MAY 3 & 5, 2024
EL ÚLTIMO SUEÑO DE FRIDA Y DIEGO
(The Last Dream of Frida and Diego)
OPERAOMAHA.ORG/23-24
“The Listen Then Act report allowed us to identify barriers faced by women working in STEM careers and provide recommendations on how to attract and retain those women, which then led to a partnership with the Women in STEM conference [and] our hosting of webinars for women in STEM,” Johnson said. “Our webinars cover topics such as how to utilize artificial intelligence or fight imposter syndrome, all through the lens of women working in STEM professions.”
According to Johnson, the ultimate goal of this effort is to ensure women stay in the STEM fields that they love and to help the organizations at which they work better understand how to support them.
Crouse has seen first-hand how Johnson’s passion and expertise have positively impacted Nebr aska Cures.
“She is a beaming light for us,” he shared. “We are extremely fortunate to have her in the executive director role. She comes with a world of experience all directly related to the work we are doing. She has great energy and has done so much to further our work.”
Both Crouse and Johnson are encouraged by the positive impact Nebraska Cures has on the Omaha community and both remain focused on educating and advocating.
“I’ve always been an educator, and the thing that makes teaching enjoyable is when you see the light go on in a student’s eyes,” Crouse said. “That is what the work I do on behalf of Nebraska Cures allows me to do. When I promote and advocate for scientific research and then see that the people I am talking to start to understand its importance, that is very rewarding.”
Visit nebraskacures.com for more information.
GIVING PROFILE // 64 // MARCH/APRIL 2024












2024 Winner Funeral Home ROEDERMORTUARY.COM 108 TH ST. CHAPEL | 402.496.9000 2727 N. 108TH ST., OMAHA, NE 68164 GRETNA CHAPEL | 402.332.0090 11710 STANDING STONE DR., GRETNA, NE 68028 AMES AVE. CHAPEL | 402.453.5600 4932 AMES AVE., OMAHA, NE 68104 Family & Veteran Owned & Operated Providing several service options to fit within CDC guidelines 2024 First Place Memory Care Facility Inquiries: 402.249.6050 / Main: 402.498.9554 parsonshouseSENIORLIVING.com 14325 Eagle Run Dr., Omaha, NE 68164 THANK YOU OMAHA FOR VOTING US BEST Memory Care AND BEST Assisted Living Facility 2024 Winner Assisted Living Facility OCTOBER 2022 SCHOOLHOUSE STYLE // A BOLD & BRIGHT REDO // A HOME OFFICE TO LOVE // MORE THAN A MAN CAVE ALWAYS LOCAL, ALWAYS BEAUTIFUL The Bakers Buy into Bohemia OmahaHome INCLUDED WITH EVERY Omaha Magazine SUBSCRIPTION! OmahaMagazine.com/Pages/Subscribe SUBSCRIBE TODAY! OMAHA MAGAZINE—1 YEAR 2 Magazines 8 Issues + Bonuses OMAHA MAGAZINE—2 YEARS 2 Magazines 16 Issues + Bonuses B2B MAGAZINE—2 YEARS 1 Magazine 12 Issues + Bonuses $1995 $2995 $1495 it’s about all of us. MARCH/APRIL 2024 60 PLUS // 65 //


Jeanie Neal’s Good Times On The Road & 60 + ACTIVE LIVING
// PHOTOGRAPHY
// DESIGN
RENEE LUDWICK JEANIE NEAL
STORY BY HOLLY MCATEE
BY BILL SITZMANN
BY

hen talking with Jeanie Neal, Program Director for Face-Up First®, the joy she has for swimming is immediately evident. The 63-year-old has enjoyed a lifelong love of swimming and adventure thanks to her mother, who got her children into swimming at a young age, because she wanted them to enjoy swimming and stay safe in the water. The self-described “pool rat” swam summer league and eventually, year-round. She also taught lessons and coached while in high school. Neal then swam a semester at the University of Nebraska Omaha but left to become the full-time coach at Millard Aqu atic Club.
Her sense of adventure then took her to Florida, where she worked in construction management. She also coached swimming part-time for Palm Beach County pool and taught private lessons at people’s homes. The county was building a new pool, so she helped to get the new swim team established. Neal’s sister, Jo Ellen, joined her in Florida, and the two coached the team for 10 years. Together, they built the club around a “good times” philosophy and a list of “Ten Training Habits.” During this time, they started using the Face-Up First® swimming method of instruction.
“I really liked teaching and coaching. Mostly, I wanted my students to like swimming as much as I did,” Neal shared. “I had thoughtful and caring coaching mentors and friends, including my high school coach, who introduced me to what would become the motto: ‘We swim for go od times!’”
Eventually, Neal moved back to Omaha with her son, Jason, where she became the Aquatics Director at Brownell-Talbot School, where she taught for 14 years. A drowning at a local business prompted her to start an online water safety education course for parents and caregivers. She first taught the course in person and then put the information online. It has continued to grow in scope and reach every year.
In 2017, Neal founded her own swimming school, Face Up First®, or “FUF,” for short. She partnered with Shelby Schultz and several other licensed providers for the curriculum. The collaboration with Schultz has led to many innovations and improvements in the FUF swimming program. Lessons take place at Omaha Home for Boys, College of Saint Mary, and the Omaha Kroc Center. Neal currently teaches around 200 swimmers a week.
FUF is a unique approach that uses the “SWIM” model: S-Stabilize; W-Wend; I-Idle; M-Measure. The focus is on first obtaining a relaxed, balanced back float, then propulsive movements. From there, students learn moving with purpose, and finally, they develop advanced swimming strokes and techniques.
To be a safe swimmer, Neal emphasized that it’s important for students to know how to stop and adjust. “Babies can do
the stabilize part, but they can’t measure,” she explained. “It’s important to have the ability to stop and be still. Kids aren’t truly skilled at swimming until they can think while they are doing stuff.”
When teaching FUF, Neal focuses on the joy and opportunity that comes from learning how to swim. “There’s a lot of water in the world. Everyone will be spending time around it, and hopefully, in it. I want everyone to be able to enjoy those opportunities to the fullest ,” she said.
FUF also has a Developmental Program for groups of skilled swimmers, who swim full lengths of the pool to improve their stroke technique and learn about the sport of competitive swimming. In all her programs, the focus is on individualizing the instruction to each swimmer. In both the instructional and developmental segments, the strokes taught remain the same and are practiced in the same order during the lessons, but at ever-increasing levels. The program also emphasizes swim team skills based on FUF’s “Ten Train ing Habits.”
Katie Sewell has three children who took lessons from Neal. “Jeanie is so dedicated to teaching and developing her students as people. She made it fun for my kids,” she shared. “My son, Tommy, swims for Creighton Prep, and she still follows him. She will send us a text about his events. She’s had a real positive influence on all my kids’ lives.”
In addition to swimming, Neal has always loved traveling. In 2019, she took a trip to Alaska to visit friends and toured a husky kennel that specializes in mushing, also known as dogsledding. Neal had discovered mushing during a trip to Ely, Minnesota, and fell in love with the sport.
A friend piqued her interest in the Iditarod, the famed annual long-distance dogsledding race that takes place in March, so when Neal returned to Omaha, she purchased a van and embarked on a six-month tour of Alaska to visit more dogsledding kennels. During that time, she lived in her van and worked in the office at Jeff King’s Husky Homestead. King is often called the “Winningest Musher in the World” and has won the Iditarod four times. Neal was delighted to be able to attend the race while
in Alaska. “I was there with the whole crew and the dogs!” she recounted.
After that experience, Neal kept her van, which she affectionately nicknamed “Vanderley” as a witty play on words for the Manderley mansion in Daphne du Maurier’s novel, “Rebecca.”
“Manderley burns down in the novel,” she joked. “I hope I didn’t jinx myself.”
Throughout the pandemic, Neal dreamt about moving into Vanderley full-time and traveling. In January 2022, she took the leap and has lived in her van ever since. Neal works at FUF three days a week and travels the other four with her two van cats, Pete and Julius. She posts one-minute videos of her travels using the handle VanlifeMinutes on Instagram a nd YouTube.
“What I love best about living in Vanderley is the freedom to pick up and go wherever, whenever. Wherever I go, I am always home. I am always pretty content wherever I am,” Neal said.
That contentment comes from living a simple life without many possessions. At first, Neal believed she would miss buying things, but now she loves simply window shopping. “I look at the beautiful things without considering buying them. I just enjoy them. Sounds corny, but I just collect memories now,” she shared.
Neal also enjoys meeting kindred spirits on the road and swappi ng stories.
“I never feel lonely on the road,” she beamed. Neal’s brother once told her that her world i s “so big.”
“What I like best about my van life is that it makes my world feel even bigger,” she said.
To learn about Jeanie Neal’s swimming methods, visit face upfi rst.com.
STORY BY TAMSEN BUTLER // DESIGN BY RENEE LUDWICK
Those who didn’t live in the Omaha area during the 1990s may be surprised to discover that the city was once home to a popular minor league basketball team named “The Omaha Racers.” The team, oftentimes affectionately referred to simply as the “Racers,” called Ak-Sar-Ben Coliseum their home and competed in the Continental Basketball Association (CBA), the predecessor to the NB A G League.
“I wouldn’t trade Omaha for the world.” -S teve Idelman
Neither the team nor the venue exist anymore, but the memories are still vivid to those who were involved in the organization. It was, after all, a team the people of Omaha could rally behind, at least from 1989 until 1997.
For owner Steve Idelman, who said he never dreamt he would own a sports team, the Racers were so much more than a minor league basketball team he just so happened to own. “The Racers were family entertainment, but the most entertained family was the Idelmans,” he said, reminiscing about sitting courtside with his wife and daughter for every game.
Although the Racers ended their run in 1997, Idelman said he is still frequently approached by strangers with, “Hey, you’re the Racers guy. Can you bring them back?”
A “Save the Racers” campaign during the 1990s made an attempt to extend the life of the team, but eventually, team ownership was too costly to maintain for Idelman. Despite an exciting championship win in 1993, the lure of college sports simply proved too strong for local spectators, dwindling the fan base for the Racers and making the team unprofitable.
Does Idelman regret buying the team since it wasn’t maintainable and he lost money in the long run as the owner?
“I wouldn’t take it back for all the tea in China,” he said with a laugh. “I thought we were buying a basketball team, but we got so much more than that. More than anything, it was a blessing to me and my family.”
Other people involved with the team agree that there was something special about the Racers. ESPN’s Tim Legler, an NBA player who spent time on the Racers early in his career, said, “I don’t think it’s an overstatement to say that the years I spent in Omaha were a very important part of my life. Certain teams you play on make it more special and more fun. Omaha was one of those teams. The people I met became lifelong friends and bec ame family.”
Legler fondly remembers Ak-Sar-Ben Coliseum, which was demolished in the mid1990s, and remembers the kindness of the people of Omaha during his time on the team.
Racers coach Mike Thibault, who later made a name for himself as the winningest WNBA coach, said that, like Idelman, he still encounters Racers fans in public. He was once approached at the airport in Paris by a couple who surprised him by calling out, “Hey, coach! We’re R acers fans!”
Both Legler and Thibault expressed a debt of gratitude to Omaha and Idelman alike. “Everyone involved in the Omaha Racers owes a debt to Steve and Sheri Idelman,” said Thibault. “It was a labor of love for everyone who did it, but we had such a great group of people. As a coach, I got to experiment and try things, and Steve was behind me the whole time.”
As for Idelman, he learned a couple things he wasn’t expecting. First, he discovered that he truly enjoyed owning a professional sports team. Secondly, the Omaha native realized that he truly loved living in Omaha, despite earlier reservations on the city. “I wouldn’t trade Omaha for the world ,” he said.
The former Omaha Racers owner has no plans to buy another team, although he said he’s been approached by people asking if he would ever consider buying a n NBA team.
The answer to that, Idelman said, is a firm “No.”
Nonetheless, the legacy of the Racers endures. The team was inducted into the Omaha Sports Commission Hall of Fame in 2023, and although the team’s run may feel to some like it was a long time ago, Idelman retains his fond memories.
“The championship and relationships last forever. It was the most fun we’ve ever had.”
60PLUS // 68 // OCTOBER 2023



For an audio version of this story, open the camera on your smart device and hover over the QR code above.
Dear Judy On Alzheimer’s, Caregiving, and Loss
Life was good for Michael and Judy James as they entered their 60s. They had been happy together for almost 40 years. The native New Englanders were enjoying successful careers after relocating in 2000 to the Midwest to teach at the University of Nebraska-Lincoln: Judy as a textile artist and visiting lecturer; Michael in the faculty of the Department of Textiles. The couple had been thrilled to see their son, Trevor, become a father to twin girls in 2007.
In 2009, Judy was diagnosed with Alzheimer’s disease, a degenerative neurological condition that affects thinking, behavior, and memory loss. In a sad juxtaposition over the next six years, the couple watched their granddaughters blossom as Jud y declined.
“As they were learning to write, first learning to read, learning the alphabet, learning numbers, she was losing all that,” Michael said. “So, as they were going up one side of the slope, she was going down the other side. In the progression of the disease, all those cognitive and intellectual skills disappear.”
At 61, Judy was younger than most at the time of diagnosis. Neither Michael nor Judy had a family history of dementia or any experience with caregiving for someone with cognitive impairment.
“It was like throwing us into completely unknown territory,” Michael recalled. He sought answers in books from medical texts to personal accounts. “To me, some of them were really helpful. I’m a realistic and pragmatic person; I see a problem, I want to know everything I can about it. I don’t want to put unpleasant things aside and not think about them, because that isn’t a solution in any way, shape, or form. I think it’s better to confront the challenge and then build toward adapting to it, responding to it in a thoughtful and pre pared way.”
Michael had published two books in the late 1970s and early 1980s, both focused on the art of

quilt-making, a professional and creative specialty; he’s recognized as a leader in the “artquilt” movement that began in the 1970s, and his works are included in many American art museums. In 2013, he began a two-year studio project exploring ambiguous grief and loss that culminated in a show featuring 14 of his pieces. He also reflected upon the experience of his wife’s illness through the medium of writing, both in poetry and a blog. After Judy’s death in 2015, Michael wrote “Dear Judy: A Love Story Rewritten by Alzheimer’s,” published in 2023 by Pine Eden Press. Judy’s art is featured on the cover.
In the form of letters with narrative transitional copy, Michael recounted his and Judy’s experience with Alzheimer’s as the disease advanced. He addressed their struggles to accommodate each stage of Judy’s decline and her lost memories and skills. Michael also openly acknowledged grieving in the midst of trying to maintain the best life possible for both Judy and himself. He even shared his reflections on facing adversity and the rewards of caregiving.
“One of the biggest things I learned was how to be in the moment with her. She reached the point where she was fully in the moment, all the time; there was no past for her, there was no future. I felt things were most harmonious when I could be as much in the moment as she was,” he said. “That helped me get past my impatience, and it taught me that patience really is a lot about being in the moment and accepting the moment.”
MARCH/APRIL 2024 60 PLUS // 71 //
60 + PROFILE // STORY BY KARA SCHWEISS // PHOTOGRAPHY BY BILL SITZMANN // DESIGN BY RENEE LUDWICK

In his book, Michael provides practical advice for caregivers and offers perspective gained from his experience.
“This is the exact type of book I didn’t have at my fingertips early on, back then,” Michael said. “There are some other good memoirs, though. In the back of my book, I list a number of them that I read later in Judy’s disease or even after her death that I think would have been really useful to m e early on.”
Michael began seeing a therapist about four years into Judy’s diagnosis, a point when her needs were increasing, but she was resisting the idea of adult da y services.
“I didn’t feel I had the option of retiring early to devote myself entirely to her care, because then we wouldn’t have had health insurance,” he said. “I felt I really needed to talk to somebody to help me negotiate the anxiety, because I was experiencing a lot of anxiety and a lot of fear. The therapist that I saw had a lot of experience with dementia and dementia caregivers, and he helped me a lot.”
Alzheimer’s has its ups and downs, Michael said, and can be confusing for caregivers who know the disease will inevitably progress despite some days being better t han others.
“There are moments of clarity, and they’re brief but shining moments, and in hindsight, I sometimes wish that I had appreciated those moments more,” he said. “I would be puzzled by them, and I’d have that hopeful feeling: ‘Maybe this is going to get better.’ That’s not how it works.”
Dementia can present flashes of levity, too, Michael said, like the time Judy said, “I’m knowing my blows” instead of “blowin g my nose.”
“There were some moments where you could chuckle. There’s a term for that point in the progression of the disease when a sufferer no longer knows that they have this disease, it’s called ‘anosognosia.’ Once Judy reached that point, there were some funny episodes,” he recalled. “One time I said something to her, and she goes, ‘Why not?’ And I said, ‘Well, because you have Alzheimer’s.’ And she goes, ‘I do?’ I said, ‘This disease has been progressing for several years.’ And she goes, ‘Oh, well, I’ll have to reme mber that.’”
Hiring home health care extended the time Judy could be cared for at home, a resource Michael said he realizes is not attainable for m ost people.
“It helped her develop some new relationships that she really valued and her caregivers equally valued. We were
very lucky in that regard. Eventually, when I finally had to put her in full-time memory care, she adapted to that very quickly and never objected, never once asked to go home. That was a blessing,” he said. “I did a really good job, in hindsight, but I felt guilty a lot of the time. I would say now there’re a few things I regret that I didn’t do, that I would do differently if I had to do it over again, but (now) I don’t feel guilty. You do the best you can, and I feel like I did everything I could, under the cir cumstances.”
Michael became part of a local group of caregiver husbands, six of them now widowers, who still meet regularly. Duane Westing is currently the only man among the group who is an active caregiver.
“Linda, my wife, was diagnosed with early-onset Alzheimer’s three years ago,” Westing said. “It is a most difficult thing to go through, and it is so important for caregivers to learn from each other, whether through reading or support groups. Linda and I are in two groups, and I attend the one for men that Michael inv ited me to.”
Talking to other caregiver husbands has provided comfort and assurance f or Westing.
“As a pastor and chaplain, I have been into caregiving more than most (men) but I still get frustrated, impatient, and disappointed,” he admitted.
He’s also finding support in reading “Dear Judy.”
“I am so glad he wrote the book and was so open and honest about his experiences,” Westing said. “Michael’s book has been most helpful to us on an ongoing basis. I read a chapter and then discuss it with Linda. We go slowly, because it is both difficult and comforting to read their story comforting because we can identify with a lot of their experiences, difficult because we hurt for them and are sad about what may happen to us.”
Michael is remarried now, and his wife, Linda, who has also lived through the experience of losing a spouse, has been very supportive of the “Dear Judy” project. James not only pays tribute to his former wife in his memoir, but still speaks of Judy with grea t fondness.
“I think about her, often, multiple times a day, sometimes dream about her,” he said. “She was very thoughtful and very considerate of other people and very compassionate just a lovel y person.”
“Dear Judy: A Love Story Rewritten by Alzheimer’s” by Michael F. James is available from most booksellers. For more information, visit pineed en press.com.
“I think about her, often, multiple times a day, sometimes dream about her. She was very thoughtful and very considerate of other people and very compassionate just a love ly person.”
-M ichael James
// 72 // 60 PLUS MARCH/APRIL 2024
60 + PROFILE

Get Fit in the Metro:
Six Independent Gyms to Elevate Your Fitness Game
Whether you're a veteran gym-goer or someone venturing into the world of fitness for the first time, Omaha's independent gyms accommodate all levels and goals. Spanning boutique-style studios to expansive workout areas, these six gyms stand out for their distinct atmospheres and dedicated commitment to helping you reach your fitness targets. Delve into this lineup of Omaha's independent gyms, each offering a personalized fitness journey and an environment tailored to empower and elevate your workout routine to new heights.
GILLYFIT
12550 West Maple Rd, Omaha, NE | getgillyfit.com
GillyFit, led by Cole Gilliland, embodies a philosophy of gradual improvement, aiming not for perfection, but daily progress. With a background in Exercise Science, Gilliland infuses both theoretical knowledge and practical experience into GillyFit's ethos. Stepping into this gym means entering a familial space where individual fitness journeys are nurtured. Dedicated to inspiring daily 1% improvement for every member, Gilliland and the GillyFit family ensure a supportive environment regardless of one's starting point in their fitness journey.
FIT CULTURE
1258 Royal Dr, Papillion, NE | fitcultureomaha.com
Fit Culture prides itself on fostering a supportive community while providing comprehensive training and nutritional advice for individuals of all athletic levels. Under the guidance of owner Cameron Kriglstein, a certified personal trainer, the gym offers a diverse array of programs ranging from Adult Boot Camp Classes and one-on-one Personal Training to specialized Youth Performance Training. Fit Culture emphasizes tailored fitness classes that adapt to individual fitness levels, ensuring inclusivity and progression. With a focus on building strong client relationships, the staff creates a comfortable and enjoyable environment for all members, complemented by nutritional lifestyle plans and online training options.
FIT FARM OMAHA
4383 Nicholas St, Omaha, NE | fitfarmomaha.com
Fit Farm, an Omaha gym focused on strength and wellness, welcomes individuals of all ages, sizes, and abilities, driven by a common goal: growth. With a commitment to individualized service, Fit Farm offers CrossFit Classes, Personal Training, and nutritional guidance, aiming to foster growth in strength and agility, while maintaining a sense of community within a welcoming and diverse gym environment. Through exercise classes that blend cardio, weightlifting, and gymnastics, Fit Farm prioritizes comprehensive health improvement alongside a holistic nutritional wellness program. On-site nutrition coaches, skilled in dietary and lifestyle modifications, collaborate to enhance overall well-being.
4
BIG OMAHA FITNESS
8529 Frederick St, Omaha, NE | bigomahafitness.com
Big Omaha Fitness stands out as Omaha's exclusive custom-built functional fitness center, boasting a spectrum of group fitness classes, personal training, and specialized nutrition coaching. Owned and operated locally by CrossFit luminary Stacie Tovar, it's a goto destination for functional fitness. A vibrant community, skilled coaches, and adaptable fitness classes cater to diverse abilities, schedules, and lifestyles. Whether a seasoned competitor or not, everyone finds their niche at Big O Fitness. Tailoring programs like CrossFit Omaha, Go Fit Omaha, Big O Wellness, and Go Far Nutrition, this gym prioritizes individual health and fitness needs with varied schedules, ensuring inclusivity every day of the week.
5
1 2 3 6
TODD SMITH FITNESS
434 N 76th St, Omaha, NE | toddsmithfitness.com
Voted Best of Omaha for over 10 years, Todd Smith Fitness redefines traditional gym experiences with over 36 years of expertise in physical training. Unique in its approach, this isn't just a gym; it's a transformative fitness journey. Founder Todd Smith recognized the gap in catering to adults seeking to become active or regain their fitness. With a personalized approach, the staff prioritizes the health and goals of each individual, ensuring safety and smiles throughout the process. Composed of a team of seasoned professionals, Todd Smith Fitness is committed to optimizing health, fostering energy, improving posture, and enhancing strength and flexibility, equipping members to tackle life's challenges head-on.
DYNAMIX STRENGTH AND FITNESS
131110 Birch Dr, Ste 152, Omaha, NE dynamixstrengthandfitness.com
Dynamix Strength and Fitness, a locally owned club in West Omaha, stands out for its collaboration with global fitness brands Les Mills and Kosama to offer premier group exercise classes. Founded by Sheri Idelman and Bri Buge in 2017, this female-owned fitness club delivers a personal trainer-quality workout in a dynamic group setting. With a wide array of formats covering kettlebells, TRX, cycling, yoga, kickboxing, weight training, and HIIT cardio, members experience new workouts daily. Access to over 25 formats and over 350 workouts, including Les Mills programs like Body Pump and Body Combat, ensures challenges suitable for every fitness level, from beginners to advanced enthusiasts.
MARCH/APRIL 2024 // 73 // OBVIOUSLY OMAHA // COMPILED BY NATALIE VELOSO // DESIGN BY RACHEL BIRDSALL


Setting a Place at the Table for Second Chances
Dining at Ooh- D e - L ally in Dundee
Awarm dining glow has returned to the iconic picture windows above Underwood Avenue in Omaha’s historic Dundee neighborhood. The space formerly occupied by the beloved Marks Bistro is open again with a new name and purpose. Ooh-De-Lally creates a community of second chances with familiar faces and great food. The term “second chance” here refers to improving outcomes of the formerly incarcerated when reentering society after completing their sentences. Government agencies, the public, and non-profits alike are supporting such initiatives more since the bipartisan passing of the Second Chance Act in 2008.
Tim Steinbach, Ooh-De-Lally’s executive director, is enthusiastic about sharing the partnerships producing this reality. The Sherwood Foundation, which promotes equity through social justice initiatives enhancing the quality of life in Nebraska, bought the Marks building. The organization then connected Steinbach with Ron Samuelson, who notably ran landmark Omaha restaurants such as M's Pub for 30 years and Vivace for 20 and now co-owns Herbe Sainte, to provide the establishment with advice on running a restaurant and providing a memorable dining experience.
The 180 Re-entry Assistance Program (180 RAP) at Metropolitan Community College (MCC) serves currently incarcerated individuals leaving jail, prison, and treatment centers. One of the largest re-entry programs
in the nation, it provides services and support to help these populations make successful transitions to achieve their education and employment goals. The college’s Institute for the Culinary Arts is developing the academic and experience curriculum required to earn a degree. Branding agency SecretPenguin created the name, brand, swag, and website.
Disney’s 1973 animated film “Robin Hood,” which featured Robin (a fox) and Little John (a bear) singing, “Ooh-De-Lally, OohDe-Lally, golly, what a day!,” inspired the restaurant’s name. Robin and his band of Sherwood Forest Merry Men, after all, were legendary for stealing from the rich to give to the poor.
“Traditionally, Dundee is such a friendly neighborhood. Everyone I talk to is tremendously helpful and supportive of our efforts. It's almost a kismet thing.”
—Tim Steinbach
Story Veronica Wortman Ploetz

| PhotograPhy
| DeSign rachel BirDSall
Bill Sitzmann
DiningFeature

MARCH/APRIL 2024 // 75 //
Doug Case

“With getting a felony, you fall flat on your face. You have to work 10 times harder to prove a restored worth to society. Now I have more motivation. Even if you fall flat because of one or two mistakes, you can recover.”
—Joseph William Blair
MARCH/APRIL // 76 // 2024
Sweet Corn Blue Crab Croquettes
“Some people immediately get the reference. This is our band of brothers, ‘Ooh-De-Lally' is our call to action, our rally cry to get things done,” Steinbach explained. For him, Dundee is the perfect neighborhood to open a concept restaurant like this. “Traditionally, Dundee is such a friendly neighborhood. Everyone I talk to is tremendously helpful and supportive of our efforts. It's almost a kismet thing.”
A 30-year restaurant veteran, Steinbach most recently served as executive chef for a senior housing facility. “Being a chef, there can be a lot of ego, but when I worked with the senior population, I remembered what my grandfather instilled in me—that we are all here to help each other out and that is why I was immediately attracted to the Ooh-De-Lally initiative,” he shared.
Steinbach works closely with Diane GoodCollins, 180 RAP’s director. She visits prisons to identify inmates who are soon to be released and demonstrate a willingness and ability to change. Formerly incarcerated people frequently face numerous challenges when reentering society. In addition to supporting their job search efforts, 180 RAP’s liaisons work to secure wrap-around and support services like securing cell phones, housing, and counseling. They also ensure that participants attend parole and probation meetings, pay their rents on time, and have support systems.
Ooh-De-Lally offers up to nine total participants the opportunity to gain experience. It can accommodate three participants in each segment, with three segments running concurrently. After three months of training, several options exist for graduates. Participants can continue to work at Ooh-De-Lally; they can transfer their earned program credits and continue their culinary education at MCC; or, they can seek employment with another restaurant with the experience earned and learned on the job.
“Whichever they choose, they will have good skills and solid references that can hopefully help them succeed at work and in life,” Steinbach said. “Every dime we make is reinvested in the program to help our participants, so I encourage everyone to come, eat, and bring all your friends.”
Diners who take Steinbach up on his offer will find that the dining experience
Dining Feature
they enjoyed at Marks remains largely unchanged. Even four of Marks beloved menu items are receiving a second chance. Much of that is thanks to Doug Case, an accomplished executive chef and industry leader with an impressive resume of restaurant experience. He was the executive chef at Children's Hospital & Medical Center when Samuelson, a long-time friend, approached him about working with the new Dundee hotspot. “Ooh-De-Lally has a special mission,” Case said. “I enjoy mentoring and helping people through tough times. And the people coming out of incarceration have a tough time getting jobs. We want to be a good partner to help people move on in a different direction.”
Case couldn’t be happier about the opportunity. The restaurant’s space had always presented some challenges. A building four stories tall might have been daunting to some, but Case feels the building’s old energy in his bones. He loves configuring, designing, cleaning, and organizing. Diners will notice some remodeling, but overall the dining room and patio feel familiar. The ground level space will be used as a wine bar featuring a different menu of easy-to-execute items like flat breads and crispy fare to be shared. A future phase will also usher in local provisions, wine, soups, and sandwiches of the grab-and-go variety. A rooftop garden will also return for al fresco dining.
Perhaps the most challenging task is the enormous responsibility of bringing back old menu favorites like Brussels sprouts, mac n’ cheese, smoked chicken lasagna, and whiskey bread pudding. “We want to faithfully recreate these dishes the way people remember them. I have confidence that we are going to execute it well,” Case said.
Described as "New American Comfort Food," Ooh-De-Lally will feature a small
menu of approachable entrées made with as many locally sourced ingredients as possible. Case hints at a creative new burger and a vegan dish that even non-vegans would crave. “The team is excited to bring back something important to the neighborhood. We are not Marks, but we know what they brought to the community,” Case said. “With the 180 RAP piece in place, that is how we give back to the community, creating a learning environment that is not a pressure cooker but based on mastering competency modules. The culture piece will stand up this program. We believe that we can succeed in a positive environment.”
Ooh-De-Lally sous chef Joseph William Blair is collaborating with Case on a successful opening, which at time of this writing had been planned for the end of February. The two spend time perfecting recipes and learning from each other. Blair was formerly incarcerated and is a pandemic-era honors graduate from MCC’s Culinary Arts and Management program. He is also a 180 RAP alumnus. “When I saw a story on the news about 180 RAP and how they help formerly incarcerated people, it spoke to me. I am glad that I had the resources in the program. They have hundreds of people they could have chosen, but they chose me and that’s why I am still a big part of the program today,” Blair said.
Through 180 RAP, Blair had support the day he was released. He received two fullride scholarships at MCC, was able to live with his parents and friends, and secured employment managing different restaurants. At times, Blair was working well over 80 hours a week and also attending school. “With getting a felony, you fall flat on your face. You have to work 10 times harder to prove a restored worth to society. Now I have more motivation. Even if you fall flat because of one or two mistakes, you can recover,” Blair said.
Without dedicated programs and job opportunities, many formerly incarcerated people end up back in the system. Blair stays in regular contact with 180 RAP liaisons to review status, emotions, jobs, goals, and referrals. “The first two years are the scariest, being completely sober and having to adjust your whole mindset. Society pushes you aside. But prison was not for me. I have huge goals,” he said. Blair's first goal is to get Ooh-De-Lally established and learn the non-profit business. “This is new to all of us. It makes me excited and nervous, but the team is the right team. I know we can do it.”
For more information about Ooh-De-Lally, visit oohdelally.org. To learn about Metropolitan Community College’s 180 Re-entry Assistance Program (180 RAP), go to mccneb.edu/ Student-Resources/Re-Entry.
MARCH/APRIL 2024 // 77 //
“An opportunity came into my life where I was traveling quite a bit and just fell in love with food and culture and the whole feel. I was able to take a step back and teach myself to cook. I read hundreds and hundreds of books and had a lot of trial and error in developing my style and what I wanted to do.”
——Don Doty
nce, while visiting the Mediterranean, Don Doty stopped into a restaurant that he described as, “3,000 years old.” The age combined with the menu made for a formative experience. “It was literally like walking into a cave with no more than eight tables in the whole place,” he remembered. With only two people running the restaurant (a wife cooking in the back and a husband running the front), the restaurant presented him with a fish dish that was, as he described, “out of this world.”
Doty set out to recreate this seminal dining experience with Wendy Becker at Cibo Vino, a restaurant that opened in May 2023 on the corner of Jackson and 11th streets in the Old Market.
The restaurant’s name translates from Italian to “Food and Wine,” and it offers a culinary experience similar to what diners experience in Italy’s “blue zone,” a geographic location where residents typically enjoy healthy longevity because of the foods they eat and the activities they enjoy. Doty and Becker set out to create an Italian-inspired restaurant where patrons feel welcome to relax as they enjoy some delicious food and wine.
For Doty, it was a matter of recreating some of his Italian travels, such as the time he rented a car and drove through the Italian Alps from Milan to Florence and then took a train from Florence to Rome. As he traveled throughout Tuscany, encountering wineries and castles along the way, he fell in love with Italian cuisine. Rome also proved to be a formative visit on the way he approaches cooking today.
“It’s not really too fussy or too many ingredients,” he remarked. “It’s just beautiful.”
What’s surprising about Doty is that he is entirely self-taught in the kitchen. His professional background is in procurement and trading. Although he spent time as a commodity broker in Chicago, his trip to Italy and the meal in the cave compelled him to give up his business career and start cooking.
“An opportunity came into my life where I was traveling quite a bit and just fell in love with food and culture and the whole feel,” he revealed. “I was able to take a step back and teach myself to cook. I read hundreds and hundreds of books and had a lot of trial and error in developing my style and what I wanted to do.”
Doty’s award-winning Bolognese makes it difficult to realize that he has no formal culinary training beyond what he taught himself. Before opening Cibo Vino with Becker, he owned Taste in Rockbrook Village and Foodies on 76th and Cass. He also spent time as the executive chef for Rotella’s Bakery.
For Cibo Vino, Doty set out to craft a menu that offers simple, high quality foods that are reminiscent of the travels that shaped him as a chef.
Like most “blue zones,” the vibe in Cibo Vino isn’t one of over-indulgence and guilt—rather, it’s about eating good food from quality ingredients. For those who would like to adhere to a Mediterranean diet, there are ample menu options, including the “Fennel Citrus Salmon” and the “Saffron Shrimp Risotto.”
Doty also recommends the small plates on the menu for those who would like to control their portion sizes. The grilled octopus is a favorite of regulars, and, of course, there’s the wine. Becker said she’s heard their wine list described as both unique and approachable.
“We go from California to Italy. We have Chilean wine. We’re all over the place, but mostly Italian wines,” she said.
When it comes to dessert, Becker suggests the “Hazelnut Panna Cotta” as a solid option for people trying to eat healthy. After all, life is a celebration, and what’s a celebration without some dessert?
“My favorite thing to say about Don is I’ve never had a bad meal at his house or one of his restaurants; it’s all been fantastic,” Becker shared, adding that if she had to choose one dish on Cibo Vino’s menu to designate as her favorite, she would opt for the risotto.
“It’s honestly the best thing ever,” she said.
The restaurant’s menu changes seasonally, although the owners assert they don’t expect any “radical changes” in the near future. Both Becker and Chef Doty have children working at the restaurant, so they hope to make Cibo Vino a legacy eatery, allowing this little slice of blue zone to continue to thrive in the Old Market.
For more information and to view Cibo Vino’s menu, visit cibovinoomaha.com.
// 78 // MARCH/APRIL 2024
Bringing the Blue Zone to the Big O
Chef Don Doty of Cibo Vino

chef profile
Story by Tamsen Butler
Photography by Bill Sitzmann
Design by Rachel Birdsall & Renee Ludwick


Illuminating
Luminarium the
REVIEW BY SAMANTHA & DAMIAN INGERSOLL// PHOTOGRAPHY BY BILL SITZMANN // DESIGN BY RENEE LUDWICK
STEAK FRITES WITH CHIMICHURRI & SIDE SALAD
Fig. a Ste p Up from Museum Cafés DINING REVIEW MARCH/APRIL 2024 // 81 //

Located in one of Omaha's newest attractions, The Kiewit Luminarium, Fig. is a hidden gem well worth exploring. The name is a wordplay inspired by scientific papers, which frequently feature designations like "Fig. 1" for "Figure 1," hence the period after Fig. Simultaneously quaint and contemporary, the restaurant offers breakfast, lunch, snacks, and a kid’s menu for visitors to the museum or anyone wanting a healthy food experience. Fig. also offers a rotating menu featuring inspired specials and hosts a monthly themed family-style "Supper Club" dinner
With its vibrant colors and bright lights, walking into the Luminarium is a sensory experience in itself, but Fig. provides a decidedly different vibe. It boasts a calming, relaxed atmosphere with a terrific view of the riverfront and downtown Omaha. The dining area is bright and open with wall-to-ceiling windows and beautiful dropdown lights for when day transitions to dusk and night. During warmer weather, guests can dine al fresco in the outdoor seating area and enjoy Happy Hour with a splendid view of t he Missouri.
Fig. distinguishes itself from other museum cafés through its dedication to serving organic and local ingredients. The restaurant works with local distributors such as Fare Table, Lone Tree Foods, and Morgan Ranch. All teas are from Artemis Tea & Botanical, while all the freshly baked breads are organic sourdough sourced from Lola's bakery. (It's worth noting that Lola's café is also Fig.'s partner.) Everything is made from scratch with most menu items costing wel l below $20.
Upon entering Fig., patrons are greeted with the deep aromas of freshly brewed coffees as well as warm smiles. Ordering from the counter was a fun way to interact with the staff, who happily provided us with recommendations and explanations about various menu items. Since it is counter service, there is not much other interaction with the servers, but we did fi nd them extremely helpful
The breakfast menu is small but has some solid choices. We loved the the Chia pudding made from coconut milk and punctuated with vanilla. Topped with strawberry jam, berry compote, and almond granola, it had a delightful texture. The salmon toast featured Gravlax with cream cheese, pickled red onion, and fried capers and was accented with Everything Bagel seasoning. The subtle combination provided for a perfect balance among competing savor y fl avors.
The lunchtime sandwich menu consists of a variety of eclectic selections. We opted for the mushroom grilled cheese. Served on crispy, rustic sourdough, it melded cheddar and Swiss cheeses into a buttery blend that was complemented by pickled mushrooms and arugula. The taste was exactly what you'd want from a grilled cheese: it featured perfectly toasted bread and gooey, stringy cheese, with the pickled mushrooms adding a sweet, yet earthy taste and arugula providing a slightly peppery punch. Pairing this with fries was a fitting lunch option. Fig.'s mushroom grilled cheese will change the way you think about this humble lunch favorite.
Fig. has many tempting main course-type options. We indulged in the steak frites. The beef was tender, moist, and cooked to medium perfection. It practically melted in our mouths. It was topped with Chimichurri sauce that packed a bright, savory flavor and a kick of heat, which elevated the beef cut. The frites, or French fries, which can be lackluster at so many establishments, were equally as impressive; they were crispy, warm, and nicely seasoned. The plate was balanced with a simple, fresh spring salad tossed gently with a bright vinaigrette.
We also shared a Caesar salad, which we consumed with great enthusiasm. We went so far as to run our bread around the inside of the bowl to catch all the remaining dressing so we didn't miss a single anchovy. The romaine lettuce was lovely and crisp, the croutons perfectly crunchy, and there were loads of parmesan, but it was really all about the those lovely, salty, meaty little fi sh.
As we had our little one with us (Fig. is perfect after a family outing at the Luminarium), we chose something simple off the kids' menu. There are many interesting choices, but we settled on the cheeseburger. It was tasty and a good size, and our little reviewer gave it two thumbs up, leaving behind an empty plate, itself a ringing endorsement.
Whether you're looking to grab a quick bite or sit in for a leisurely meal, Fig. is a worthy choice for a healthy, inspired meal.
To view Fig.'s menu, visit figomaha.com
Fig. is perfect after a family outing at th
 MUSHROOM GRILLED CHEESE
MUSHROOM GRILLED CHEESE
Luminarium // 82 // MARCH/APRIL 2024
e


FOOD SERVICE
AMBIANCE
OVERALL 5 STARS POSSIBLE
FIG. 345 RIVERFRONT DR, I 531.999.1284
DINING REVIEW
CAESAR SALAD
DJ’S DUGOUT SPORTS BAR - $
Seven Metro Area Locations:
Bellevue - 10308 S. 23rd St.
- 402.292.9096
Miracle Hills - 777 N. 114th St. - 402.498.8855
Downtown - 1003 Capitol Ave. - 402.763.9974
Aksarben - 2102 S. 67th St. - 402.933.3533
Millard - 17666 Welch Plaza - 402.933.8844
Elkhorn - 19020 Evans St. - 402.315.1985
Plattsmouth - 2405 Oak Hill Rd. - 402.298.4166
Voted Omaha’s #1 Sports Bar, DJ’s Dugout is locally and Vietnam Veteran owned. DJ’s Dugout features delicious burgers, wings, wraps, salads, sandwiches and an impressive drink menu. Plus, DJ’s has huge media walls full of HD TVs and projector screens. Catch all the action at DJ’s seven Omaha-area locations. Dig In... At The Dugout! —djsdugout.co m
JAMS- $$
7814 Dodge St. - 402.399.8300
17070 Wright Plz, Ste. 100 - 402.810.9600
1101 Harney St. in the OldMarket - 402.614.9333
Jams is an Omaha restaurant legacy, an “American Grill” that offers a melting pot of different styles and varieties. The dishes are made with high-quality ingredients that pair well with awardwinning wines or creative cocktails. —jamseats.com
LE PEEP - $
69th & Pacific - 402.933.2776
177th and Center St. - 402.934.9914
156th St. & W. Dodge Rd. - 402.408.1728 120th and Blondo St. - 402.991.8222
Le Peep puts a wholesome perspective on your favorite neighborhood breakfast and lunch spot. Fresh. Simple. Elegant. Inviting. We put the emphasis on people, both patrons and staff. We focus on providing each of our guests the fresh food and friendly service that they have come to expect. Open daily 6:30 a.m.-2 p.m. —lepeepomaha.com
SAND POINT - $$$
655 North 114th Street Omaha, NE 68154
—531-466-1008
Sand Point ‘New England Fare’ brings their favorite and unique dishes from New England to the Omaha food community. Freshest seafood, from seared crab cakes, lobster arancini, whole belly clams, New England clam chowder, lobster bisque to charcuterie boards and Angus beef tips and steak burgers, to be topped off with Boston cream pie, blueberry pie or Lemon canna cotta. Full bar to include, specialty cocktails, extensive wine lists, as well as beer and non-alcoholic drinks. –sandpointomaha.com
STELLA’S - $
106 S. Galvin Road, Bellevue - 402.291.6088
Since 1936, we’ve been making our world-famous Stella’s hamburgers the same way. The family secrets have been handed down to each owner, ensuring that your burger is the same as the one you fell in love with the first time you tried Stella’s. And if it’s your first time, we know you’ll be back! Monday-Saturday 11 a.m.-9 p.m., closed Sunday. —stellasbarandgrill.com
T ED AND WALLY’S - $ 1120 Jackson St. - 402.341.5827
Come experience the true taste of homemade ice cream in the Old Market. Since 1986, we’ve created gourmet ice cream flavors in small batches using rock salt and ice. We offer your favorites, plus unique flavors like margarita, green tea, Guinness, and French toast. Special orders available. Mon.-Thurs. 11 a.m.-10 p.m., Fri.- Sat. 11 a.m.-11 p.m., Sunday. Noon-10 p.m. —tedandwallys.co m
TWISTED CORK BISTRO - $$$$
10370 Pacific St. - 531.999.3777
We arrived in Nebraska from Washington intent on purchasing from farmers, ranchers & fishmongers who share our commitment for wholesome, sustainable fare. Our recipes use the Earth’s bounty the way it is intended ~ Wild and Natural ~ We compliment
our dishes, pairing them with exquisite Pacific Northwest wines. –twistedcorkbistro,com
PACIFIC EATING HOUSE - $$$$
1130 Sterling Ridge Dr. - 531.999.3777
We have developed our menu inspired by all that touches the Pacific Ocean. Starting with fresh fish flown from Honolulu, locally sourced steaks and natural chicken with an Asian flare and pairing our dishes with tiki libations and Pacific coast wines. —pacificeatinghouse.com
PINE & BLACK BISTRO - $$$$
248 Olson Dr., Papillion - 531.999.3777
We opened in March of 2023 to bring a family owned bistro to the community, serving local steaks and fresh seafood. We offer a wide variety of Pacific Northwest wines, local beers, and craft cocktails. Pinot Noir translates to Pine & Black, our name originates from our love of wine. —pineandblackbistro.com


// 84 // MARCH/APRIL 2024
- Sponsored ContentDINING GUIDE Omaha DINING GUIDE LEGEND $=$ 1-10 • $$=$ 10-20 • $$$=$20-30 • $$$$=$ 30+ 7 METRO AREA LOCATIONS DJSDUGOUT.COM | WELCOME TO OMAHA BASKETBALL FANS! 2023 1 Place Sports Bar 2022 W NNER 3 VOTED OMAHA'S #1 SPORTS BAR! 2024 First Place Sports Bar





VARSITY SPORTS CAFE - $$
Ralston - 9735 Q St. - 402.339.1944
Bellevue - 3504 Samson Way - 402.932.1944
Millard - 14529 F St. - 402.505.6660
Ralston, Bellevue and Millard. We are truly grateful to have been welcomed into each of these communities and welcome you in for good food, a cold drink and a comfy seat to enjoy the sport of your choosing! Determined to bring only the freshest ingredients, homemade dough and our specialty sauces to the table, we have worked hard to perfect our craft for you. Our goal is to bring the best food service to the area and show the best sports events that you want to see. Pick up and Delivery availalble. Please check website for hours of operation.
—varsityromancoinpizza.com
ITALIAN
S PEZIA - $$$
3125 S. 72nd St. - 402.391.2950
Choose Spezia for lunch or dinner, where you’ll find a casual elegance that’s perfect for business guests, get-togethers, or any special occasion. Exceptional food, wine, and service, with a delectable menu: fresh seafood, certified Angus steaks, innovative pasta, risotto, gnocchi, cioppino, lamb, entrée salads, Mediterranean chicken, flatbreads, and fresh salmon daily. Enjoy a full bar, Italian and California wines, Anniversary/ Lovers’ Booth (call to reserve), private dining rooms, and woodfired grill. Open Monday-Sunday. Cocktail hour 4-6 p.m., when all cocktails, glasses of wine, and beers are half price. Evening reservations recommended.
—speziarestaurant.com
MARCH/APRIL 2024 // 85 //
Omaha thanks to our customers for voting us the BEST BURGER IN OMAHA “ServingWorldFamousHamburgersSince1936” 106 GALVIN RD., BELLEVUE, NE • 402-291-6088 • OPEN MONDAY - SATURDAY, 11 AM - 9 PM 2024 First Place Hamburger DINING GUIDE LEGEND $=$ 1-10 • $$=$ 10-20 • $$$=$20-30 • $$$$=$ 30+
DINING GUIDE
3125 South 72 nd Street (Easy access off I-80, take 72nd Street Exit) 402.391.2950 . Call today to make your reservation Get aLittle Saucy. CALL FOR RESERVATIONS • 402-391-2950 SATURDAY LUNCH [11am–4 pm] SPEZIASPECIALTIES FRESH SEAFOOD • ANGUS BEEF INNOVATIVE PASTA • RISOTTO GNOCCHI • FRESH SALMON DAILY COCKTAIL HOUR MONDAY – SATURDAY 4 – 6 PM ALL COCKTAILS, GLASS WINE AND BEERS ARE HALF PRICE CENTRAL LOCATION • 3125 SOUTH 72ND STREET • EASY ACCESS OFF I-80 • 72ND STREET EXIT $10 OFFANY TICKETOVER $25 NO CASH VALUE. EXPIRES 12/31/2011 2024 Winner Romantic Restaurant 2024 Winner Happy Hour 2024 First Place Italian Dining SPEZIA SPECIALTIES WOOD FIRE STEAKS & SEAFOOD INNOVATIVE PASTA—RISOTTO—GNOCCHI FRESH SALMON DAILY CHECK OUT OUR SPECIAL SPRING DINING FEATURES Open 7 Days a Week for Lunch & Dinner




// 86 // MARCH/APRIL 2024 Family Owned Since 1983 CATERING / PARTY ROOM AVAILABLE HOMEMADE, FRESH FOOD, ALWAYS. 3821 Center St. / 402.346.1528 GreekIslandsOmaha.com 2023 First Place Greek Dining STEAKS • CHOPS • SEAFOOD ITALIAN SPECIALTIES 7 private party rooms Seating up to 400 Lots of parking 1620 S. 10th Street 402-345-8313 www.casciossteakhouse.com 2023 W nner Steakhouse 2022 W nner Steakhouse Serving Omaha for 77 Years 2024 First Place Ice Cream rotellasbakery.com Since 1921 Celebrating over 100 Years of Baking Excellence! GLUTEN-FREE BREADS Rotella March-April 2024 Omaha Mag ad.indd 1 1/23/24 3:17 PM














DINING GUIDE Omaha Take Out & Delivery Available Online Ordering Available at Bellevue & Millard Locations varsityromancoinpizza.com 402.339.1944 402.505.6660 402.932.1944 Sports Bar Happy Hour 3-7 pm M-F Watch Your Favorite Teams On Our Big Screen TVs 655 N 114th St, Omaha NE 68154 sandpointomaha@gmail.com 531.466.1008 Open 7 days a week • 7:00 a.m. - 2:00 p.m. 156th & Dodge | 402-408-1728 • 177th & Center | 402-934-9914 120th & Blondo | 402-991-8222 • 69th & Pacific | 402-933-2776 LePeepOmaha.com • @LePeepOmaha 2023 F rs Place W itSt & Se vice Locally owned and operated since 2001! Voted Omaha’s Best Breakfast 17 years in a row!
Omaha
DINING GUIDE
over four generations, a familyfriendly atmosphere, and plates to satisfy cravings at every hour—with breakfast, lunch, and dinner menus offering a variety of Mexican staples—Primo’s Mexican Restaurant is proud to serve the people of Omaha and Council Bluffs no matter the occasion. —primosmodernmexican.com
SPECIAL DINING
GREEK ISLANDS - $
3821 Center St. - 402.346.1528
Greek cuisine with specials every day at reasonable prices. We are well-known for our gyro sandwiches and salads. We cater and can accommodate a party for 65 guests. Carry-out and delivery available. Monday-Thursday
11 a.m.-9 p.m., Friday-Saturday 11 a.m.-10 p.m., Sunday 11 a.m.-7 p.m. —greekislandsomaha.co m
ZEN COFFEE COMPANY - $
West - 132nd and Center
Downtown - 25th and Farnam One Pacific Place - Drive Thru Kiosk next to Trader Joes
Zen features over 50 popular drink options including Butter Beer, Honey Bee, Lavender Lady and Sunshine Daydream. Choose from hot or iced lattes, blenders, fruit smoothies and teas! Grab a flight or double cup to try the seasonal features! Delicious pastries and toasts made in house daily. —zencoffeecompany.com

STEAKHOUSES
CASCIO’S - $$
1620 S. 10th St. - 402-345-8313
C ascio’s is Omaha’s No. 1 steakhouse. We have been serving Omaha for 69 years. We feature steaks, chops, seafood, and Italian specialties. We have seven private party rooms, seating for up to 400 people, and plenty of parking. —casciossteakhouse.co m
THE DROVER RESTAURANT & LOUNGE - $$$
2121 S. 73rd St. - 402-391-7440
Famous for the original Whiskey Steak. Truly a one-of-a-kind Midwestern experience. Excellent food, wine, service, and value. Rare...and very well done.
LUNCH: Monday-Friday 11 a.m.-2 p.m.,
DINNER: Monday-Friday 5 p.m.-10 p.m.,
Saturday 4:30 p.m.-10:30 p.m.,
Sunday 4:30 p.m.-9 p.m.,
LOUNGE: Monday-Friday Cocktails only 2 p.m.-5 p.m. —droverrestaurant.com

OUR STORY IS A STORY OF FAMILY.
THINGS RELATED, BUT DIFFERENT. NATIONS, NORTH AND SOUTH. WE ARE AMERICAN-GROWN WITH MEXICAN ROOTS, PROUDLY CHICANO. FLAVORS, TRADITIONAL AND NEW. WE EVOLVE MEXICAN FAMILY RECIPES WITH OUR OWN MODERN TWIST.
CITIES, EAST AND WEST. WITH ROOTS IN COUNCIL BLUFFS AND OMAHA, OUR MEMORIES AND DEDICATION TO THIS COMMUNITY SPAN THE MIGHTY MO. OUR STORY IS A STORY OF COUSINS. OR AS OUR ANCESTORS SAY, PRIMOS. WHERE FAMILY, FLAVOR AND COMMUNITY COME TO THE TABLE.

PRIMO’S
5914
PRIMO’S
930
Both locations are open for BREAKFAST AT 7 A.M.
PRIMO’S OMAHA OFFERS THE LARGEST OUTDOOR HEATED PATIO IN OMAHA






OMAHA
Center Street | Omaha,
NE 68106 402-322-8141
COUNCIL BLUFFS
5th Ave. | Council Bluffs, IA 51501 712-256-5200
248 Olson Drive | Papillion PineandBlackBistro.com
1130 Sterling Ridge Drive | Omaha PacificEatingHouse.com










MARCH/APRIL 2024 // 89 // Find the best food in Omaha! omahamagazine.com/pages/subscribe Charlie’s on the Lake 4150 South 144th St. Omaha NE 68137 402-894-9411 2024 First Place Steakhouse @The Drover Restaurant & Lounge | Gift Cards Available 2121 S. 73 St. | (402) 391-7440 | DroverRestaurant.com Lunch M-F 11am-2pm | Dinner M-F 5pm-10 PM Sat 4:30pm-10:30pm • Sun 4:30pm-9pm | Lounge M-F Cocktails Only 2-5pm
come and
explore.
LET’S PLAN A ROAD TRIP!

COMPILED BY
Claudia Moomey
NEBRASKA
HELLO SPRING! CRAFT AND VENDOR SHOW March 2 at the Seward County Fairgrounds in Seward This free craft show presents a day of fun and shopping for the whole family. Over 65 vendors will fill the pavilion, offering everything you need for the Spring season. Bring the kids for an Easter egg hunt and enjoy the adult egg hunt for prize-filled baskets. Food trucks will be on site. —allevents.in/seward/ hello-spring-craft-and-vendor-show
2024 MIDTOWN EVENT CENTER
March 16
ORD GUN SHOW March 2–3 at the Trotter Event Center in Ord Buy, sell, trade, or just admire at this firearm expo. Discounted admission for veterans, active military, and first responders. 308.728.5307 —trottereventcenter-ord.com
DRUM TAO March 7 at the Lied Center for Performing Arts in Lincoln This unique combination of taiko drumming and theatrical staging is sure to dazzle any viewer. The centuries-old Japanese art form comes to life with Drum Tao’s 40 performers whom the Chicago Tribune calls “seductive,” “alluring,” and “extremely talented percussion artists.” 402.472.4747 —liedcenter.org/event/ drum-tao-2024
BRIDAL SHOW March 16 at Midtown Event Center in Norfolk Get ready for the most amazing Bridal Show in Northeast Nebraska! Hosted by Dream Makers Events & Planning, this bridal expo will feature giveaways, a fashion show, food samples, and much more. Whether you're looking for traditional or unique ideas, exhibitors will provide you with a wide range of options to make your special day unforgettable. From breathtaking venues to delicious wedding cakes, you'll find everything you need to plan your perfect wedding. —eventbrite.com/e/2024-midtownevent-centers-1st-annual-bridal-show
SHUFFLE 5K WALK/RUN/CRAWL
March 16 at Tooley’s Lounge in Fairbury
This St. Patrick’s Day-themed 5K will include green beverages and a “Best Dressed” award for the greatest costume. The post-race celebration will feature food, drinks, and live music. 402.729.3000 —visitnebraska.com/fairbury/ events/shamrock-shuffle-5kwalkrun-crawl
AVENGED SEVENFOLD: LIFE IS BUT A DREAM…TOUR March 16 at the Pinnacle Bank Arena in Lincoln Fresh off a #1 single at Rock Radio this year, Avenged Sevenfold, comprised of members M. Shadows, Synyster
Gates, Zacky Vengeance, Johnny Christ, and Brooks Wackerman are touring in support of their recently released 8th studio album, "Life is But a Dream." Don’t miss this headbanging concert! 402.904.5600
—www.pinnaclebankarena. com/events/detail/ avenged-sevenfold-2024
PLAINS GAME FESTIVAL March 22–24 at the Cornhusker Mariott Hotel in Lincoln 2024 will be the 11th year of this event dedicated to tabletop and board games. This weekend of family fun will include prizes, game giveaways, and a huge library of games for all ages.
—tabletop.events/conventions/ great-plains-game-festival-2024
LINCOLN GEM & MINERAL SHOW
April 6 – 7 at the Lancaster Event Center in Lincoln This event is the perfect opportunity for gem and jewelry enthusiasts to find rare, unique jewels, gems, and minerals.
—lancastereventcenter.org
SOULFEST SPRING SHOW 2024
April 27 at the Buffalo County Fairgrounds in Kearney This event showcases a vast array of healing options—energy work, intuitive readings and healing, crystals, natural foods and supplements, handcrafted art, and more. Admission is free, and there is sure to be something for everyone.
// 90 // MARCH/APRIL 2024
DAYTRIPS IN NEBRASKA, IOWA, KANSAS, MISSOURI, AND SOUTH DAKOTA
This event will feature giveaways, and vendors will have exclusive specials. The first 25 visitors will receive swag bags. 308.236.1201 —buffalocountyfairgrounds.com
IOWA
IOWA HOME EXPO March 8–10 at the Iowa State Fairgrounds in Des Moines Meet with vendors and remodeling experts at this expo, which will display all things home improvement, remodeling, outdoor living, and more. —iowahomeexpo.com
HOT WHEELS MONSTER TRUCKS
LIVE GLOW PARTY March 10 at the Mid-America Center in Council Bluffs
The Hot Wheels Monster Trucks Live Glow Party brings audiences the only opportunity to see reallife versions of the famous Hot Wheels monster truck toys in the dark. Mega Wrex, Tiger Shark, Boneshaker, Bigfoot, and more, plus the all-new Gunkster, will light up the floor in outrageous monster trucks competitions and battles. 712.323.0536 —caesars.com
ALL IOWA AUTO SHOW March
15–17 at the Iowa Events Center in Des Moines Featuring dozens of manufacturers displaying brand new makes and models. Win door prizes and see the latest vehicles with no sales pressure. 515.564.8000 —iowaeventscenter.com
of fairy tales is sure to entertain. Prepare to be dazzled with a retelling of Dorothy’s journey with her friends followed by a new, sophisticated interpretation of the Grimm brothers’ “Snow White.” —balletquadcities.com
—visitoverlandpark.com/event/ open-season-sportsmansexpo/420
March
THE KAT AND DAVE SHOW: DAVID FOSTER & KATHARINE MCPHEE April 30 at Hoyt Sherman Place in Des Moines This husband-and-wife duo are a force to be reckoned with in the music world. David Foster has won 16 Grammy Awards and is known for writing some of music’s most famous songs and albums, collaborating with musicians such as George Harrison, Earth, Wind, & Fire, Chicago, Kenny Loggins, and many others. Katharine McPhee was an instant favorite on American Idol in 2006, jumpstarting her success in solo albums and, most notably, her performance as Karen Cartwright in the hit NBC musical TV show “SMASH.” 515.244.0507 —hoytsherman.org
THE IMPROVISED SHAKESPEARE
COMPANY April 30–May 5 at the Temple Theater in Des Moines
March 15-17
IOWA EATS FOOD & DRINK FESTIVAL
April 6 at the Waterloo Convention Center in Waterloo This celebration of food & drink tasting will feature live music, cooking and product demonstrations, and countless Iowa foods, products, chefs, authors, and agriculture-related products. —iowaeatsfesival.com
SHEN YUN April 10–11 at the Paramount Theater in Cedar Rapids This theatrical spectacle brings to life the best of Ancient China through original orchestration and choreography, evoking ethnic and folk traditions alongside legends from China’s 5,000 years of civilization. —creventslive.com/ paramounttheater
DOROTHY GOES TO OZ & SNOW WHITE April 13 at the Adler Theater in Davenport Two one-act ballets in one performance, this compilation
This talented troupe of actors creates fully improvised Shakespearean plays on the spot based on suggestions of made-up play titles from the audience. Performing nationally and internationally, the ISC has been named Chicago’s best improv group and has received numerous awards. —desmoinesperformingarts. org/events/the-improvisedshakespeare-company
KANSAS
MODEL TRAIN SHOW March 2–3
at Crown Toyota in Lawrence The 22nd annual model train show and sale in Lawrence offers fun for the whole family. Adult admission: $8 or $6 with a canned food donation. Children 12 and under can attend for free. There will be a BBQ food truck on site to keep the family fueled for a day of fun. —kcparent.com/events/lawrence-kansas-model-train-showmarch-2nd-3rd
OPEN SEASON SPORTSMAN’S EXPO
March 8–10 at the Overland Park Convention Center in Overland Park Find the latest gear, participate in demos, and learn from industry experts at this outdoor activity expo.
FLOGGING MOLLY: ROAD TO REBELLION TOUR March 9 at the Kansas Star Arena in Mulvane —unation.com/event/floggingmolly-road-to-rebelliontour-46818647
BLAKE SHELTON March 29 at the INTRUST Bank Arena in Wichita Blake Shelton will perform his Back to the Honkey Tonk Tour with special guests Dustin Lynch and Emily Ann Roberts. —visitwichita.com/event/blakeshelton-back-to-the-honky-tonktour/40309/
MANDY PATINKIN IN CONCERT: BEING ALIVE April 1 at the Lied Center in Lawrence —explorelawrence.com/event/ mandy-patinkin/29133/
THE LIFE AND TIMES OF A. EINSTEIN April 27–28 at the White Theater in Overland Park This delightful play presents a day in the life of the great scientist as seen through the eyes of his secretary. —thejkc.org/ events/2024/04/28/theatre/ the-life-and-times-of-a.-einstein/
MISSOURI
PLANET COMICON March 8–10 at the Kansas City Convention Center in Kansas City This event will feature an incredible lineup of celebrities, exhibitors, panels, and cosplay contests. —planetcomicon.com
WOODWORKING SHOW March 15–17 at the Hy-Vee Arena in Kansas City A unique opportunity for woodworkers to come together and show their passion, this expo is a must-attend for anyone interested in woodworking. A wide range of exhibitors, tools, and seminars promises a valuable experience for woodworking artists and sellers alike.
—thewoodworkingshows.com
TIM MCGRAW: STANDING ROOM ONLY
TOUR March 22 at the Enterprise Center in St. Louis Featuring special guest Carly Pearce. —enterprisecenter.com/events/ detail/tim-mcgraw
MARCH/APRIL 2024 // 91 //
9 EXPLORE CALENDAR















RECREATIONAL FISHING CONCERTS & EVENTS GOSARPY.COM 2000 AFFORDABLE ROOMS REDISCOVER THINGS THIS SPRING IN SARPY COUNTY! AWARD-WINNING FOOD & DRINKS BELLEVUE • GRETNA • LA VISTA • PAPILLION • SPRINGFIELD • OFFUTT AFB Experience OUTDOOR ADVENTURE
TACO & MARGARITA FESTIVAL March 23 at the Chaifetz Arena in St. Louis World-class tacos and signature margaritas feature in this festival for food lovers. The day will include live DJs, professional wrestling, and taco and hot pepper eating contests. —greatriverroad.com
16TH ANNUAL GATEWAY BLUES FESTIVAL March 29 at the Stifel Theater in St. Louis This blues festival will feature Tucka, King George, Pokey Bear, West Love, J’Wonn, and Theodis Ealey. Hosted by Heritage Entertainment as part of the 2024 Blues is Alright Tour. —stifeltheatre.com/events/detail/ the-16th-annual-gateway-bluesfestival
SOUTH DAKOTA
NATIONAL PHEASANT FEST & QUAIL CLASSIC March 1–3 at the Denny Sanford Premier Center in Sioux Falls This trade show focuses on wildlife conservation, upland game bird hunting, dog training, and wildlife habitat management and will also feature seminars on various related subjects by Pheasants Forever. —travelsouthdakota.com/siouxfalls/events/huntingfishingevents/national-pheasant-festquail-classic
SPRING SIOUX EMPIRE ARTS & CRAFTS SHOW March 15–16 at the W. H. Lyon Fairgrounds in Sioux Falls Shop handmade items from the Midwest’s most talented artists among food trucks and fun activities. —travelsouthdakota.com/sioux-falls/ events/arts-crafts-shows/springsioux-empire-arts-crafts-show
FORKS, CORKS, AND KEGS April 12–13 at Deadwood Alive in Deadwood Sample a variety of beer and wine from across the country as you make your way to various tasting venues at this festival in Historic Deadwood. Each location will feature their chef’s finest culinary creation paired with the perfect complementary beverage. Then head to the Grand Tasting, which features dozens of beer and wine varieties and light hors d’oeuvres. Must be 21 to participate. —blackhillsvacations.com/event/ forks-corks-kegs







all day long in a world of big toys and big fun!
MARCH/APRIL 2024 // 93 //
EXPLORE CALENDAR
play
REHEARSAL DINNERS • WEDDINGS • RECEPTIONS






Seating from 25 to 250
Unique location with one-of-a-kind views of downtown Omaha
Open, flexible layout
Club rental includes tables, china, flatware and glassware
Wide variety of delicious food options prepared by a Hall of Fame Executive Chef — from hors d’oeuvres to buffets to a full, multi-course, sit-down dinner
Hosted and cash bars available
OMAHA PRESS CLUB • LOCATED ON THE 22ND FLOOR OF THE FIRST NATIONAL BANK BUILDING • 1620 DODGE ST.









 @isaarelaphoto
@rockhoppingpenguin
@sixhesix
@isaarelaphoto
@rockhoppingpenguin
@sixhesix
#OMAHAMAGAZINE ON INSTAGRAM TO BE FEATURED BELOW instagram.com/omahamagazine facebook.com/omahamagazine twitter.com/omahamagazine @russ.torres253
@imagiendojo
@daze_of_film
@huskertiara
@alderimageswildlife
GIVE US A FOLLOW
@urbanaliciaphotography

When I was just a little kid, I was really afraid of getting lockjaw. Though, it must be said, my fear was not instinctive. It was, like most fears we humans wallow in, acquired.
I remember stepping on an old, rusty nail one summer at the farm. The flaky, red spear went straight through the thin sole of my brand new white Keds sneakers and into my big toe.
Now, it must be said, farms are very dangerous places. The risk of dismemberment by auger–fingers usually–being crushed by a tractor, or blinded by an ill-tempered rooster while gathering the eggs before breakfast are real. In fact, it’s a miracle that farm kids ever survive into adulthood at all, and those who do frequently turn into wild risk takers willing to throw caution to the wind and gamble their lives away by taking over the family farm after mom and dad have moved to town to be closer to their weekly pinochle game.
It's just true that farmers think of danger and risk in a whole different way than us sophisticated urban dwellers, who think we are the tough ones. Anyway, there I was, a sweet, innocent city boy, with a bloody spike protruding from the top of my shoe, crying for help. My grandfather, Johann, soon appeared in his Jack Rabbit bib overalls with a plug of Day’s Work chewing tobacco peeking out of the breast pocket. He looked down at me.
“Kann man Dich nicht mal fünf Minuten alleine lassen?” he said.
I took comfort in his words. But only because I didn’t speak German and didn’t realize he was being a bit cross with me.
Grandpa knelt beside me, and he took my foot in his massive hands. Reaching to the underside of the bloody footwear, he grabbed the rusty nail head like it was a sewing needle and pulled it out of my foot in the blink of a teary eye. He carried me to the pump in the barnyard, and after removing my shoe and reddened sock, he rinsed my bloody toe in the cold pump water that gushed out with every plunge of the lever. The chill of the well water numbed the pain, stopped the bleeding, and grandma wrapped my toe in gauze before she gave me a glass of fresh milk.
It was all so wonderful.
Then my mother came to pick me up at the end of the week, found out what happened, and began screaming.
“Lockjaw! He’ll get Lockjaw!”
“Lockjaw?” I thought. That sounds scary. And, of course, it is scary if you get Tetanus, though I didn’t know that was the real name of lockjaw, and to be honest, Tetanus is not as scary a word, is it? But lockjaw? That is so descriptive.
Mom rushed me to the clinic and got me a Tetanus shot. I never got lockjaw. But ever since that day, I’ve been very frightened of having my or my children’s jaws locked. I think I have driven them to get scores of Tetanus shots for even the most minor of wounds—rusty or otherwise.
I remain surprised that I have yet to know anyone who has ever gotten lockjaw. Yet, I still remain hypervigilant and to this day have never been able to bring myself to buy another pair of Keds.
Listen to Otis Twelve host “Morning Classics,” weekdays 6AM—10AM, on KVNO, Omaha Classical Radio, 90.7 or kvno.org.
NOT FUNNY // COLUMN BY OTIS TWELVE // PHOTOGRAPH BY BILL SITZMANN
MARCH/APRIL // 96 // 2024
LOCKJAW









10730 Pacific Street | Omaha 531.999.3777 Open Monday-Saturday Always Wild, Always Natural TwistedCorkBistro.com 248 Olson Drive | Papillion 531.999.3777 Open Tuesday through Sunday Family-owned bistro, serving wholesome, sustainable fare PineandBlackBistro.com 1130 Sterling Ridge Drive | Omaha 531.999.3777 Open Monday through Sunday A taste of the Pacific Coast in the Heartland PacificEatingHouse.com
As easy as one, two, ThreeForMe™
The newest cutting-edge treatment for total skin rejuvenation has arrived at Schlessinger MD. You can now schedule your customized ThreeForMe™ laser treatment, which combines three laser sessions in one appointment to treat wrinkles, sun damage and unwanted veins for the best results, in a fraction of the time. With advancements for increased patient comfort, ThreeForMe™ provides immediate results in fewer treatments with additional improvement over time.
Schedule your ThreeForMe™ treatment today and save $500*
* Cannot be combined with any other offer.

Best of Omaha 2024 winner in 9 categories
Best Cosmetic Surgeon
B est Dermatologist
Best Local Website
Best Beauty Supply Store
Best Med Spa
Best Day Spa
Best Body Contouring
Best Laser Hair Removal
Best Waxing/Hair Removal


GET IN TOUCH 402 334 7546
Cosmetics@LovelySkin.com SchlessingerMD.com 2802 Oak View Drive | Omaha, NE 68144
|



































































 RENEE LUDWICK
RENEE LUDWICK
 BY BILL SITZMANN
STORY BY NATALIE VELOSO
BY BILL SITZMANN
STORY BY NATALIE VELOSO

STORY BY SARA LOCKE
BILL SITZMANN
STORY BY SARA LOCKE
BILL SITZMANN
 Mischa Mikityuk
Dr. Anup Pathania
Julia Matos
by Claudia Moomey | Design by Rachel Birdsall
Mischa Mikityuk
Dr. Anup Pathania
Julia Matos
by Claudia Moomey | Design by Rachel Birdsall


































































































 MUSHROOM GRILLED CHEESE
MUSHROOM GRILLED CHEESE



















































































